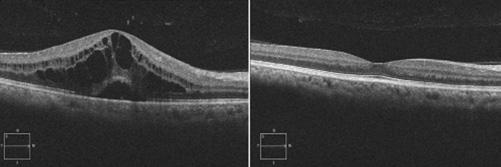

ARTICLE 1
Médication soutenue, MIGS, MIBS et implants • Partie III
ARTICLE 2
L’uvéite non infectieuse • Partie I
ARTICLE 3 La blépharoptose


ARTICLE 1
Médication soutenue, MIGS, MIBS et implants • Partie III
ARTICLE 2
L’uvéite non infectieuse • Partie I
ARTICLE 3 La blépharoptose
Une conception. Deux options.
Faites confiance aux lentilles cornéennes BiofinityMD toric et MyDayMD toric dont la conception torique avancée, l’excellente acuité visuelle6, la bonne stabilité⁷ et l’ajustement fiable7 en font le produit idéal

Pour un confort tout au long de la journée, jour après jour.

Lentilles toriques
BiofinityMD toric
Géométrieoptimisée de la lentille toriqueMC TechnologieAquaformMD Convient jusqu’à 99,9 % des patientsastigmates3
Chose certaine, à tous points de vue
CooperVision offre à vos patients astigmates des performances 3,4inégalées
DMmrofauqAeigolonhceT tneivnoC à’uqsuj 9,99
3setamgitsastneitap
eésimitpoeirtémoéG ed al ellitnel CMeuqirot
unique MyDayMD toric

Lentilles toriques à usage



Pour un confort tout au long de la journée, jour après jour.
Faites confiance aux lentilles cornéennes BiofinityMD toric et MyDayMD toric dont la conception torique avancée, l’excellente acuité ,6visuelle la bonne 7stabilité et l’ajustement 7fiable en font le produit idéal pour presque 5tous vos patients astigmates.
Une conception. Deux options.

de se retrouver dans un cours d’eau à l’échelle mondiale. CooperVision achète un nombre de crédits égal au poids du plastique dans les commandes de [claritiMD 1 day/MyDayMD à usage unique, BiofinityMD et MiSightMD 1 day] au cours d’une période précise. Le plastique présent dans les commandes de [claritiMD 1 day/MyDayMD à usage unique, BiofinityMD et MiSightMD 1 day] est déterminé par le poids du plastique dans l’emballage-coque, les lentilles et l’emballage secondaire, y compris les stratifiés, les adhésifs et les ajouts auxiliaires (par exemple, l’encre). 3. Données internes, CVI, 2020. Sondage en ligne mené par Kubik auprès de professionnels de la vue aux États-Unis, en Allemagne, en Espagne, au Japon et en Corée du Sud. Échantillon pondéré total n = 549. Significativement plus élevé que Johnson & Johnson Vision, Alcon et Bausch + Lomb; p<0,05. 4. Données internes, CVI, 2020. Revue sur le rendement tirée de 12 études sur les lentilles cornéennes souples toriques, comprenant les lentilles MyDayMD toric à usage unique BiofinityMD



ÉDITEUR
Association des Optométristes du Québec 1255, boul. Robert-Bourassa, bureau 1400 Montréal, Québec H3B 3X1
COURRIEL | aoq@aoqnet.qc.ca
PRÉSIDENT
Docteur Guillaume Fortin, optométriste ABONNEMENT ANNUEL
CANADA | 85,45 $
ÉTRANGER | 125,00 $ (taxes incluses)
COORDONNATEUR SCIENTIFIQUE
Docteur Jean-Pierre Lagacé, optométriste, M.Sc. COURRIEL | jpierre.lagace@aoqnet.qc.ca
COORDONNATRICE DE LA PRODUCTION
Josée Lusignan | 514 288-6272
COURRIEL | josee.lusignan@aoqnet.qc.ca
PUBLICITÉ
Cynthia Fournelle
CPS Média Inc.
TÉLÉPHONE | 450 227-8414, poste 318 COURRIEL | cfournelle@cpsmedia.ca
CONCEPTION GRAPHIQUE
BooDesign.ca
ARTICLES DEMANDÉS
TÉLÉCOPIEUR | 514 288-7071
COURRIEL | aoq@aoqnet.qc.ca
SITE INTERNET | www.aoqnet.qc.ca
Bibliothèque nationale du Québec 2e trimestre 1979
Reproduction interdite sans autorisation.
LE PRÉSENT NUMÉRO A ÉTÉ TIRÉ À
3 050 exemplaires
ISSN-0708-3173
Numéro de convention postale : 41129579
L’Optométriste ouvre ses pages à toute collaboration pouvant intéresser la profession optométrique sur le plan professionnel, social, économique et syndical. Le Comité de rédaction invite tous les optométristes à soumettre le rapport d’un cas ou un article susceptible d’intéresser leurs confrères. Tous les écrits soumis deviennent la propriété de la revue l’Optométriste. Le Comité de rédaction se réserve le droit de publier un article dans le numéro qui lui convient. Aucune indemnité ne sera versée à l’auteur pour l’utilisation d’un article. Les textes ainsi que les publi-reportages publiés dans cette revue n’engagent que leur auteur.
VEUILLEZ ENVOYER VOS ARTICLES À L’ÉDITEUR
Revue l’Optométriste
1255, boul. Robert-Bourassa, bureau 1400 Montréal, Québec H3B 3X1
TÉLÉPHONE | 514 288-6272

05 ÉDITORIAL
Un air de déjà vu
« L’optométriste (O.D.) est un professionnel de la santé de première ligne, détenteur d’un doctorat universitaire de 5 ans, qui agit comme porte d’entrée des services oculo-visuels. Il évalue la vision, la binocularité et la santé oculaire. Son rôle est de procéder à l’examen des yeux et de la vision. Il peut également prescrire et administrer des médicaments aux fins de l’examen de la vision et du traitement de certaines pathologies oculaires. Il prescrit les lentilles ophtalmiques nécessaires, qu’elles soient cornéennes ou pour lunettes, et des traitements de rééducation visuelle. L’optométriste prodigue des conseils afin de prévenir les troubles visuels et de promouvoir la saine santé oculo-visuelle de ses patients et, au besoin, il peut diriger le patient vers d’autres professionnels de la santé. »


40 CHRONIQUE LES CONSEILS D'AFFAIRES MNP
Fiducie 101 : comment s’y retrouver ?
Docteur Guillaume Fortin, optométriste, Président
08 ARTICLE 1
Médication soutenue, MIGS, MIBS et implants • Partie III
Docteur Jean-Pierre Lagacé, optométriste, M.Sc.
22 ARTICLE 2
L’uvéite non infectieuse • Partie I
Docteur Jean-Pierre Lagacé, optométriste, M.Sc.
32 ARTICLE 3
La blépharoptose
Docteur Jean-Pierre Lagacé, optométriste, M.Sc.
44 CHRONIQUE JURIDIQUE
Le droit du logement fait peau neuve
48 CHRONIQUE ACTUALITÉS
59 CHRONIQUE LUSSIER
59 Dommage par l'eau
60 Fatigué ? Attention de ne pas vous blesser
62 CHRONIQUE FMOQ
La pénurie de logements locatifs : bien plus qu’un enjeu d’immigration
64 LES PETITES ANNONCES CLASSÉES DE L'AOQ


Comme vous le savez, nos négociations avec l’État ne sont jamais faciles. À moins d’un revirement extraordinaire et bien malgré nos bonnes intentions au départ, les présentes négociations se déroulent sur un air de déjà vu. Ce même refrain que nous avons entendu à la dernière ronde : nous présentons des demandes basées sur l’étude des frais d’exploitation et le MSSS prend un temps fou à nous revenir avec une contre-offre. Celle-ci est ni plus ni moins que celle offerte aux salariés de l’État sans aucune logique puisque, mis à part nos optométristes en centres de réadaptation, nous ne sommes pas des employés du système de santé. Le MSSS met en doute les résultats de l’étude et va même plus loin en niant pratiquement l’existence des frais de gestion. Nous avons dit au MSSS que leur offre est inacceptable et, malgré cela, ils nous reviennent avec exactement la même offre… Point de rupture, nos membres se braquent et le spectre de la non-participation au régime de la RAMQ revient. Cette fois, selon les commentaires reçus de nos membres, nous sentons que le ras-le-bol par rapport à la RAMQ est possiblement plus grand qu’en 2017 !

L’opinion partagée par la majorité de nos membres est que la couverture de la RAMQ pour les jeunes, les personnes âgées et les plus vulnérables est une bonne chose, puisque nos services sont une nécessité pour les Québécoises et Québécois et qu’ils ne peuvent être rendus à l’intérieur des établissements de santé par d’autres professionnels. De plus, la difficulté de faire reconnaitre l’existence des frais de gestion associés aux services que la RAMQ paye dans nos cliniques privées devient un irritant majeur ! Cet irritant amène plusieurs d’entre vous à nous communiquer sur les réseaux sociaux votre volonté de couper définitivement le lien avec ce mauvais payeur qu’est la RAMQ. Sachez que malgré notre objectif premier d’obtenir une entente adéquate, nous avons été et serons toujours en phase avec la volonté majoritaire de nos membres.
En sus du manque de sérieux de nos visà-vis, toutes nos demandes concernant l’accessibilité de nos services et l’amélioration de l’efficacité ont été balayées du revers de la main… ! Notamment, la couverture des examens en téléoptométrie, la couverture de la dilatation pupillaire pour les personnes âgées et, comme cela existe chez les médecins, pouvoir facturer des appels aux patients, à la famille ou à d’autres professionnels en gestion de cas problématiques. Les mesures proposées par le MSSS en matière d’accessibilité et d’efficacité seraient plutôt de nature à ralentir le flot des patients et à favoriser l’adoption de méthodes non souhaitables de la part des optométristes pour maintenir leurs revenus et leur efficacité. Dans le cas particulier de la téléoptométrie, en refusant de tarifer nos actes, le MSSS ouvre la porte toute grande au profilage de patients ! Certaines mesures proposées par le MSSS mettraient même à mal notre autonomie professionnelle. Nous sommes encore une fois devant un manque de connaissance de la pratique optométrique, un manque de capacité d’analyse des enjeux et un manque de sérieux en matière de reconnaissance des frais de bureaux.
Si la dernière rencontre n’a rien donné côté monétaire, elle aura tout de même permis aux optométristes de votre comité de négociation d’exprimer le non-sens des propositions du MSSS d’un point de vue pratique et clinique. Espérons que cette dernière rencontre engendrera une réflexion plus approfondie de la part de nos vis-à-vis. Alors oui, c’est un air de déjà vu et, oui, l’explication de notre réalité unique est toujours à recommencer, et ce, même lorsque le MSSS s’adjoint un optométriste-conseil.
Plusieurs d’entre vous nous ont dit que « leur stylo était prêt » et nous ont demandé « Où est-ce que je signe ? »
La non-participation est une avenue que tous peuvent prendre. Nous doutons fort que la situation change à court terme et nous vous invitons à participer en grand nombre à l’assemblée générale annuelle le 8 juin lors de laquelle l’état de la situation vous sera présenté.
 Docteur Guillaume Fortin, optométriste Président
Docteur Guillaume Fortin, optométriste Président
POUR NOUS JOINDRE
514 288-6272
1 888-SOS-OPTO
DES QUESTIONS ?
écrivez-nous à aoq@aoqnet.qc.ca





VENDREDI, 4 OCTOBRE DE 12 H À 18 H
SAMEDI, 5 OCTOBRE DE 10 H À 14 H 30
Palais des congrès de Montréal



FAIRE UN CHANGEMENT D'ADRESSE
Rendez-vous sur le portail de l'AOQ | aoqnet.qc.ca

















Vous avez mieux à faire de votre temps que de vous rappeler d’investir ?
Automatisez votre épargne et courez la chance de gagner des billets pour des spectacles de votre choix partout au Canada et aux États-Unis*.
10 CERTIFICATS-CADEAUX TICKETMASTER D’UNE VALEUR DE 500 $ SERONT TIRÉS PARMI LES PERSONNES ADMISSIBLES.
Pour en savoir plus : fondsfmoq.com/concours-cotisez
* Certaines conditions s’appliquent.


PAR

A. Goniotomie à la lame double Kahook Dual Blade (KDB)
La lame double Kahook (New World Medical, Rancho Cucamonga, CA) est une lame de goniotomie spécialisée qui a été introduite aux États-Unis en 2015. Elle a été conçue pour améliorer l’excision du réseau trabéculaire lors de la goniotomie. Il s’agit d’une lame jetable à usage unique dotée d’une pointe acérée qui sert à percer le réseau trabéculaire, d’une rampe qui étire le réseau trabéculaire et de deux lames parallèles qui créent des incisions parallèles jumelées dans le réseau trabéculaire. Cette conception permet une excision complète du réseau trabéculaire et réduit le potentiel de cicatrisation des feuillets de tissu résiduels. La technique chirurgicale implique une approche ab interno par des incisions cornéennes claires avec visualisation de l’angle par gonioscopie directe et une approche perpendiculaire du réseau trabiculaire (RT). Le traitement dure de trois à cinq heures.
La deuxième génération de KDB GLIDE est disponible depuis octobre 2020. Bien que la conception de la double lame parallèle et de la rampe reste la même, les nouvelles caractéristiques comprennent un talon arrondi, des côtés effilés et une plaque de pied plus petite. Ces changements améliorent la facilité d’utilisation et optimisent l’ajustement dans le canal.
La goniotomie à la lame double de Kahook peut être pratiquée chez les patients atteints de glaucome à angle ouvert, d’hypertension oculaire et chez certains patients atteints de glaucome par fermeture de l’angle. La goniotomie KDB peut être pratiquée soit au moment de la chirurgie de la cataracte, soit en tant que procédure autonome chez les patients phaques, aphaques ou pseudophaques.
Plusieurs études ont démontré l’efficacité clinique de la goniotomie à la lame double de Kahook pour la réduction de la PIO chez les patients atteints de glaucome. L’une de ces études, réalisée par Greenwood et al., s’est penchée sur les résultats à un an de la KDB par rapport à la phacoémulsification. L’étude a porté sur 71 yeux d’une population mixte de patients atteints de glaucome léger à sévère de différents types, y compris le glaucome primaire à angle ouvert, le glaucome pigmentaire, la pseudoexfoliation, le glaucome à tension normale et le glaucome par fermeture de l’angle. Les critères de jugement primaires étaient la réduction de la PIO et la proportion de patients ayant obtenu une réduction de la PIO de plus de 20 % par rapport à la valeur initiale. Les critères de jugement secondaires comprenaient la réduction du nombre de collyres hypotenseurs91 Après 6 mois, la PIO moyenne a diminué de 17,4 ± 5,2 mm Hg à 12,8 ± 2,6 mm Hg, et 58,3 % des patients avaient une réduction de la PIO de ≥ 20 % par rapport à la ligne de base. Le nombre de gouttes oculaires hypotensives a diminué de 1,6 ± 1,3 à 0,9 ± 1,0 goutte oculaire92. Une autre étude a porté sur 52 yeux de patients atteints de glaucome à angle ouvert et de cataractes visuellement significatives qui ont subi une phacoémulsification avec goniotomie KDB. Les mesures des résultats étaient la réduction moyenne de la PIO, la proportion de patients avec une réduction ≥ 20 % de la PIO et la réduction du nombre de gouttes ophtalmiques réduisant la PIO.
Un an après l’opération, les yeux ayant subi une phacoémulsification avec goniotomie KDB ont connu une réduction significative de la PIO moyenne de 16,8 ± 0,6 mm Hg au départ à 12,4 + 0,3 mm Hg, 57,7 % des yeux ont connu une réduction de 20 % de la PIO et le nombre de médicaments a diminué de 1,6 ± 0,2 à 0,8 ± 0,1 collyre93. Une autre étude a évalué les résultats à 12 mois de la phaco-KDB par rapport à la KDB seule. Le succès a été défini comme une réduction ≥ 20 % de la PIO et/ou une réduction d’au moins un médicament contre le glaucome. La phaco-KDB a eu un taux de réussite de 71,8 % et la KDB seule de 68,8 %94
La goniotomie à lame double de Kahook est le plus souvent pratiquée sous anesthésie topique. Chez les enfants ou les adultes moins coopératifs, elle peut être pratiquée sous anesthésie générale. Pour les patients nécessitant une anesthésie générale, il est important de rappeler à l’équipe d’anesthésie que la rotation de la tête du patient sera nécessaire avant d’effectuer ces manœuvres. La pilocarpine préopératoire et/ou les agents miotiques intracaméraux peuvent être utilisés chez les patients subissant l’intervention sans phacoémulsification pour faciliter la visualisation de l’angle, mais ce n’est pas nécessaire95


Une paracentèse cornéenne est d’abord créée, puis la chambre antérieure et l’angle sont approfondis avec du viscoélastique. De la lidocaïne non conservée peut être instillée par voie intracamérulaire avant le viscoélastique pour renforcer l’anesthésie. Une incision temporale de la cornée claire d’au moins 1,5 mm est ensuite pratiquée. Du viscoélastique est ajouté si nécessaire pour approfondir l’angle nasal. Il faut veiller à ne pas trop gonfler l’œil, car cela peut entraîner un affaissement et une difficulté à pénétrer dans le canal. De même, un sous-gonflage de la chambre antérieure peut entraîner des stries cornéennes à la gonioscopie. Ensuite, la tête du patient est inclinée d’environ 30 à 45 degrés par rapport au chirurgien et le microscope est incliné de 45 degrés vers le chirurgien. Du viscoélastique est placé sur la face inférieure d’un gonioprisme direct et le dispositif est inséré par l’incision cornéenne sur le côté avec la main dominante du chirurgien tandis que le gonioprisme est placé sur la surface oculaire avec la main non dominante de façon à ce que le trabéculum nasal soit en vue directe. Si les structures anatomiques sont difficiles à identifier, du bleu trypan peut être utilisé pour colorer le trabéculum, ou la PIO peut être abaissée temporairement pour produire un reflux sanguin dans le CS. La pointe acérée de la lame est insérée à travers le RT et dans le CS. Une fois le RT percé, le talon du dispositif est placé contre la paroi du CS et avancé dans le sens des aiguilles d’une montre ou dans le sens inverse jusqu’à 3 à 5 heures environ, selon la préférence du chirurgien. Au fur et à mesure que le dispositif est avancé, la rampe étire doucement le RT tandis que les doubles lames créent des incisions parallèles pour générer une bande de RT91, 97
En présence d’une large bande trabéculaire, celle-ci peut être retirée à l’aide d’une pince intraoculaire. Les petites bandes et/ou les bandes périphériques peuvent toutefois être laissées en place. Le viscoélastique est ensuite irrigué de la chambre antérieure et une solution intraoculaire de carbachol peut être injectée par voie intracamérulaire pour produire un myosis pupillaire. Toutes les plaies sont hydratées et vérifiées pour assurer une fermeture étanche et un nylon 10-0 est placé dans la plaie principale si nécessaire. Il est recommandé de maintenir une PIO légèrement élevée, de l’ordre de 20 à 25 mm Hg, à la fin de l’intervention afin d’éviter un nouveau reflux sanguin, bien que cela dépende du patient et du chirurgien.
Lorsqu’elle est pratiquée en même temps que la chirurgie de la cataracte, la goniotomie peut être effectuée avant ou après la phacoémulsification, selon les préférences du chirurgien, car une étude n’a montré aucune différence dans la visualisation évaluée par les chirurgiens, que l’intervention soit effectuée avant ou après la phacoémulsification. Lors de l’enquête, 98 % des chirurgiens ont reconnu que l’utilisation de la lame était simple et 98 à 99 % ont reconnu que l’avancement de la lame dans le CS était efficace98
Le Trabectome est un système chirurgical développé par NeoMedix (Tustin, CA). Il a été approuvé par la FDA en 2004 et est utilisé pour réaliser une trabéculotomie ab interno Le système fonctionne en retirant une bande du réseau trabéculaire et la paroi interne du canal de Schlemm afin de créer un chemin pour le drainage de l’humeur aqueuse99-101 Le dispositif consiste en une pièce à main jetable à usage unique qui effectue l’électrocautérisation, l’irrigation et l’aspiration. Il est relié à un générateur d’une fréquence de 550 kHz qui permet des réglages par incréments de 0,1 watt et est commandé par une pédale à trois niveaux qui déclenche l’irrigation, l’aspiration et l’électrocautérisation dans l’ordre. L’irrigation et l’aspiration continues permettent d’éliminer les débris et de réguler la température. En outre, l’extrémité du Trabectome est pliée à un angle de 90° pour créer une plaque triangulaire protectrice et faciliter l’insertion dans le canal de Schlemm; elle est recouverte d’un revêtement pour faciliter le mouvement à l’intérieur du canal. L’ablation peut être appliquée sur 60˚-120˚ du réseau trabéculaire pour permettre le rétablissement de la voie de drainage.

Le dispositif Trabectome a été inventé par George Baerveldt, de l’Université de Californie à Irvine, et Roy S. Chuck, du Montefiore Medical Center, le brevet associé ayant été déposé en 2002 102. Le dispositif commercial est fabriqué par NeoMedix Corporation (Tustin, CA) et est commercialisé pour la « gestion microchirurgicale du glaucome de l’adulte et de l’enfant ». Le dispositif a été homologué par la Food and Drug Administration (FDA) des États-Unis en avril 2004. Les premiers cas ont été réalisés au Mexique et les premières procédures aux États-Unis ont eu lieu en janvier 2006 pour le traitement du glaucome à angle ouvert103
L’instrument Trabectome utilise une électrode bipolaire de 550 kHz, à puissance réglable, pour ablater le RT104=6 Contrairement à la cautérisation, le plasma généré ici a un cône de dissipation de chaleur très confiné avec un transfert thermique minimal vers la paroi externe (environ 1,2 C). Le dispositif est équipé d’une plaque de base qui aide à guider la pointe électrochirurgicale et à protéger les tissus adjacents. Une perfusion constante permet de maintenir la chambre et les débris tissulaires sont éliminés par aspiration à travers la tige du dispositif104
Avec plus de 50 000 cas documentés au cours de la décennie qui a suivi l’approbation initiale de la FDA, l’utilisation du Trabectome a été plus largement acceptée et ses indications se sont élargies pour inclure le Trabectome après une trabéculectomie ratée105 et dans les angles étroits106. Le reste de cet article traite des indications de la procédure, des contre-indications, de la technique chirurgicale, des résultats et des complications potentielles.
Le Trabectome est indiqué pour les patients souffrant de divers types de glaucome à angle ouvert, d’hypertension oculaire et peut être utilisé chez certains patients souffrant de glaucome par fermeture de l’angle. Le Trabectome peut être réalisé en conjonction avec une opération de la cataracte ou en tant que procédure autonome. Il peut être pratiqué sur des patients phaques, pseudophaques ou aphaques.
Maeda et al.100 ont évalué les résultats du Trabectome autonome sur 80 yeux de 69 patients avec ou sans chirurgie intraoculaire ou laser préalable. Une PIO préopératoire moyenne de 26,6 ± 8,1 mm Hg a été réduite à une moyenne de 17,4 ± 3,4 mm Hg six mois après l’opération. Le nombre moyen de médicaments a également diminué, passant de 4,0 ± 1,4 à 2,3 ± 1,2 gouttes à 6 mois. L’étude n’a fait état d’aucune complication grave, notamment d’épanchement choroïdien, d’hémorragie choroïdienne ou d’infection. Treize yeux ont nécessité des interventions chirurgicales ultérieures en raison d’une PIO non contrôlée, 10 patients ayant subi une trabéculectomie et 3 patients ayant subi un nouveau Trabectome100. Dans une étude achevée en 2008 et portant sur 304 yeux de patients atteints de glaucome à angle ouvert, des résultats similaires ont été obtenus en combinant phacoémulsification et Trabectome101 La PIO moyenne est passée de 20,0 ± 6,3 mm Hg à 15,5 ± 2,9 mm Hg un an après l’opération et le nombre moyen de médicaments topiques a été réduit de 2,65 ± 1,13 à 1,44 ± 1,29 gouttes. Les complications comprenaient une lésion de l’iris chez 4 patients et un pic de PIO chez 26 patients.
C. TRAB 360/OMNI/Visco 360/OMNI
Le système chirurgical OMNI® est une technologie de nouvelle génération qui combine les fonctions distinctes de ses deux dispositifs prédécesseurs TRAB® 360 pour la trabéculotomie et VISCO360® pour l’administration transluminale de viscoélastique en un seul dispositif de sorte que les trois sources de résistance dans la voie d’écoulement conventionnelle (réseau trabéculaire, canal de Schlemm et canaux collecteurs) peuvent être ciblées avec un seul dispositif et une seule intervention chirurgicale.
Le système OMNI (Sight Sciences, Menlo Park, Californie) est une pièce à main à usage unique qui permet au chirurgien d’effectuer une trabéculotomie au moyen d’une incision cornéenne claire. L’extrémité de la pièce à main est utilisée pour percer le réseau trabéculaire et le microcathéter est avancé à partir de l’extrémité du dispositif et enfilé à travers 180 degrés du canal de Schlemm. Le microcathéter étant toujours dans le canal de Schlemm, le dispositif est rétracté de l’œil en déchirant le microcathéter à travers le réseau trabéculaire sur 180 degrés. Le dispositif est ensuite tourné et réinséré et la procédure est répétée pour les 180 degrés restants de l’angle afin de réaliser un traitement complet de 360 degrés.
Cette intervention peut être pratiquée sur des patients adultes ou pédiatriques atteints de glaucome à angle ouvert et dont la cornée est claire. Les patients peuvent être phaques, pseudophaques ou aphaques. Cette opération peut être réalisée seule ou en conjonction avec une opération de la cataracte.
Cette approche ab interno est utilisée pour canuler et viscodilater le canal de Schlemm en utilisant le même type de microcathéter que pour une procédure de canaloplastie standard, mais sans laisser la suture au Prolene à l’intérieur du canal. Outre la baisse de la PIO, un autre avantage de la canaloplastie ab interno est qu’elle laisse la conjonctive intacte et prête pour d’autres interventions chirurgicales, y compris les procédures MIGS107
Le dispositif OMNI est facilement inséré dans la chambre antérieure, par une incision cornéenne claire de 1 mm (Figure 1), avec un embout de canule courbé rempli d’un OVD de haut poids moléculaire tel que Healon GV (Johnson & Johnson Vision) ou similaire. Une lentille gonio avec ou sans poignée est placée sur la cornée pour permettre une visualisation correcte de l’angle. L’extrémité de la canule est ensuite déplacée à travers la pupille, vers l’angle iridocornéen, et l’extrémité de la canule est pressée contre le réseau trabéculaire (RT) pour créer une petite ouverture dans le canal de Schlemm. Le microcathéter est ensuite inséré en tournant la petite roue située sur la poignée du dispositif (Figure 2). Une fois le microcathéter rétracté, l’OVD est injecté en quantité constante et mesurée pour dilater le canal de Schlemm et traiter les éventuelles hernies ou blocages des canaux collecteurs distaux107




La nouvelle série Ergo optimise l’ergonomie et la facilité d’utilisation chirurgicale tout en permettant aux chirurgiens d’effectuer des procédures de glaucome peu invasives et sans implant108
Une étude de Sarkisian et al. a évalué l’innocuité et l’efficacité de TRAB360 chez des patients atteints de glaucome primaire à angle ouvert réfractaire. Quatre-vingt-un yeux de 57 patients atteints de divers types de glaucome (fermeture de l’angle, congénital, inflammatoire, néovasculaire, induit par les stéroïdes et à angle ouvert) ont subi l’intervention TRAB360 en tant que procédure autonome. Les mesures des résultats comprenaient la réduction de la PIO après l’opération, la proportion d’yeux atteignant une réduction ≥ 20 % de la PIO à 12 mois et le nombre de gouttes ophtalmiques nécessaires pour abaisser la PIO. Un an après l’opération, seuls 41 yeux (51 %) étaient disponibles pour l’analyse. La réduction moyenne de la PIO était de 7,3 ± 6,7 mm Hg et 59 % des yeux ont connu une réduction ≥ 20 % de la PIO. Le nombre de médicaments pour réduire la PIO a diminué de 1,7 ± 1,3 goutte oculaire avant l’opération à 1,1 ± 1,0 goutte oculaire à 12 mois. En outre, 37 % des yeux n’ont pas eu besoin de médicaments pour abaisser la PIO à 1 an109
Trabéculotomie autonome et viscodilatation du canal de Schlemm et des canaux collecteurs dans le glaucome à angle ouvert à l’aide du système chirurgical OMNI : résultats à 24 mois
Objectif : Pression intraoculaire (PIO), résultats de la médication à 24 mois après trabéculotomie/viscodilatation à l’aide du système chirurgical OMNI® en tant que procédure autonome dans le glaucome à angle ouvert (GAO) léger à modéré non contrôlé médicalement110
Cadre de l’étude : Centre chirurgical (Düsseldorf, Allemagne).
Conception : Analyse rétrospective. Les données relatives à la PIO et aux médicaments ont été recueillies avant l’opération et pendant 24 mois. Les données de sécurité comprenaient les événements indésirables et la nécessité d’une intervention chirurgicale supplémentaire.
Méthodes : Élimination des médicaments avant l’opération. Tonométrie de Goldmann. Nombre de médicaments et d’événements indésirables à chaque point dans le temps.
Résultats primaires : Changements dans la PIO et les médicaments. Des tests t bilatéraux par paires comparent les valeurs à chaque suivi avec la ligne de base, signification p = 0,05. Résultats secondaires : proportion d’yeux avec une réduction de la PIO de ≥ 20 %, avec moins de médicaments et sans médicaments à chaque point dans le temps.
Résultats : Cette analyse a porté sur les données de 38 yeux de 27 sujets. La PIO initiale moyenne (écart-type) était de 24,6 (3,0) mm Hg et, après 24 mois, elle variait de 12,6 à 14,9 mm Hg (p < 0,0001), ce qui représente des réductions de 10,0 à 12,0 mm Hg. La moyenne des médicaments était de 1,9 (au départ) et, au cours des 24 mois, elle a varié de 0,0 à 0,5 (réduction de 70,6 à 100 %) (p < 0,0001). Au 24e mois, la PIO moyenne était de 14,9 mm Hg (-10,0 mm Hg), et 100 % des yeux avaient obtenu une réduction de la PIO de > 20 % par rapport à la valeur initiale; la consommation moyenne de médicaments était de 0,5 (-1,4 médicaments, p < 0,0001), 84,6 % des yeux utilisaient > 1 médicament de moins, et 57,7 % n’utilisaient aucun médicament. L’événement indésirable le plus fréquent était l’hyphème peropératoire (44,7 %), qui s’est résolu spontanément. Il y a eu deux procédures secondaires pour le contrôle de la PIO.
Conclusion : Le système chirurgical OMNI permet des réductions cliniquement pertinentes et statistiquement significatives de la PIO et des médicaments avec un excellent profil de sécurité et devrait être envisagé dans les yeux phaques ou pseudophaques avec un GAO léger à modéré nécessitant une réduction de la PIO ou des médicaments, ou les deux.
Amélioration de l’écoulement aqueux par le canal de Schlemm
A. Visco 360/OMNI
Nous en avons parlé dans la rubrique précédente.
B. Canaloplastie Ab interno (ABiC)
L’ABiC offre une approche complète de la chirurgie micro-invasive du glaucome (MIGS) grâce à l’accès, la cathétérisation et la viscodilatation de tous les aspects de la résistance à l’écoulement, le réseau trabéculaire, le canal de Schlemm et le système d’écoulement distal, en commençant par les canaux collecteurs. L’ABiC est un moyen innovant d’utiliser une technique et une technologie éprouvées plus tôt dans le processus de la maladie, et la procédure peut être réalisée pendant la chirurgie de la cataracte ainsi que sur des patients pseudophaques111 Les premiers cas ont confirmé que la procédure offrait une efficacité de réduction de la PIO équivalente à celle de la chirurgie filtrante traditionnelle, mais sans les complications liées aux bulles qui empêchent les chirurgiens du glaucome de dormir la nuit112
De nombreuses études cliniques évaluées par des pairs ont depuis confirmé que la canaloplastie est aussi efficace que la trabéculectomie pour réduire la PIO et la dépendance des patients à l’égard des médicaments, mais avec un profil de sécurité bien meilleur113-118
En tant que chirurgien, je pense que l’excellence n’est pas une destination, mais un voyage. Pour moi, la dernière avancée est la canaloplastie ab interno (ABiC), un raffinement subtil, mais significatif de la canaloplastie ab externo traditionnelle qui peut abaisser la PIO de manière similaire chez les patients atteints de glaucome primaire à angle ouvert (GPAO) léger à modéré.
L’ABiC offre une approche complète de la chirurgie micro-invasive du glaucome (MIGS) grâce à l’accès, la cathétérisation et la viscodilatation de tous les aspects de la résistance à l’écoulement, le réseau trabéculaire, le canal de Schlemm et le système d’écoulement distal, en commençant par les canaux collecteurs. L’ABiC est un moyen innovant d’utiliser une technique et une technologie éprouvées plus tôt dans le processus de la maladie, et la procédure peut être réalisée pendant la chirurgie de la cataracte ainsi que sur des patients pseudophaques.
La principale différence entre l’ABiC et la canaloplastie traditionnelle est que, dans le premier cas, aucune suture de tension n’est nécessaire pour maintenir la réduction de la PIO. Bien que certains chirurgiens, dont moi-même, aient noté de manière anecdotique que l’absence de suture de tension ne compromettait pas la réduction de la PIO chez certains patients après des procédures de canaloplastie traditionnelle, des preuves plus solides ont été apportées par une étude des données à 3 ans de Lewis et al. qui a indiqué que la viscodilatation à 360˚ seule (c’est-à-dire la canaloplastie sans suture) réduisait avec succès la PIO113=2. La mise en correspondance des résultats de la viscodilatation avec la tension de la suture a également montré que la viscodilatation était le moteur de la réduction de la PIO plus que la tension de la suture.
Avec l’ABiC, l’algorithme de traitement chirurgical du glaucome s’est élargi. Les chirurgiens peuvent désormais intervenir plus tôt dans le glaucome qu’avec les procédures de filtrage conventionnelles, et les médecins et les patients bénéficient en outre d’un suivi postopératoire simplifié et d’une réduction des effets secondaires et des complications par rapport à la trabéculectomie.
Étant donné que l’ABiC est recommandée à un stade précoce de la maladie, l’indication principale est pour les patients atteints de glaucome léger à modéré qui suivent un traitement médical. La procédure peut également être considérée comme un traitement de première intention, et c’est une option pour les patients qui ont subi une trabéculoplastie au laser et ceux pour qui l’adhésion au traitement médical du glaucome est problématique. Les patients atteints de glaucome exfoliatif et ceux chez qui la chirurgie du glaucome dans l’autre œil a échoué peuvent également être pris en considération pour l’ABiC. Les critères d’exclusion sont similaires à ceux de la canaloplastie traditionnelle, et l’ABiC ne doit pas être pratiquée sur des patients atteints de glaucome néovasculaire ou de glaucome chronique à angle fermé.
L’ABiC est le plus souvent réalisée en association avec la phacoémulsification. Elle n’est cependant pas limitée à une procédure combinée, mais peut être réalisée seule. En outre, l’ABiC préserve le tissu conjonctival en vue d’interventions ultérieures, le cas échéant.
L’expérience clinique de l’ABiC est conforme aux conclusions de Lewis et al. Pour ce qui est de la sécurité et de l’efficacité de la procédure113. Sur 106 patients traités dans une série de cas récente, il y a eu une diminution moyenne totale de la PIO de 35 % et des médicaments contre le glaucome de 100 % 6 mois après l’opération par rapport à la ligne de base (M.A.K., données non publiées, 2014-2015). La valeur initiale médiane maximale de la PIO enregistrée pour 106 patients était de 21 mm Hg (± 5,4 écart-type [ET] sous 2 médicaments ± 1 ET); à 1 mois, 100 patients ont enregistré une PIO médiane de 16 mm Hg (± 5,2 ET sous aucun médicament ± 0,6 SD); à 3 mois, 48 patients avaient une PIO médiane maximale enregistrée de 15 mm Hg (± 4,5 SD sur aucun médicament ± 1 SD); et à 6 mois, 20 patients avaient une PIO médiane maximale de 14,5 mm Hg (±2,7 SD sur aucun médicament ± 1 SD).
Pour les patients ayant subi une phacoémulsification et une ABiC combinées, la diminution moyenne totale de la PIO était de 38,4 % à 6 mois. Pour les patients qui n’utilisaient pas de médicaments contre le glaucome avant l’opération, la diminution moyenne totale de la PIO a été de 36,4 % après 6 mois. Pour les patients qui n’avaient pas subi de chirurgie du glaucome auparavant, la diminution moyenne totale de la PIO était de 38,1 % et de 100 % des médicaments à 6 mois. La diminution totale à 6 mois était de 33,3 % pour ceux qui avaient déjà subi une chirurgie du glaucome.
Bien qu’un suivi plus long soit clairement nécessaire pour confirmer ces premiers résultats, je suis convaincu que l’ABiC s’appuiera sur la réputation éprouvée de la canaloplastie en tant que procédure peu invasive et maximalement efficace pour traiter le GPAO léger à modéré.
Plus récemment, les approches ab interno du canal de Schlemm qui épargnent les incisions conjonctivales et sclérales ont gagné en popularité, y compris de nombreuses chirurgies micro-invasives du glaucome (MIGS).
La technique ab interno implique la création d’au moins deux incisions cornéennes claires et la création d’une goniotomie limitée. Après la création de la goniotomie, le cathéter iTrack (Nova Eye Medical Limited, Adélaïde, Australie) est enfilé à travers le site de goniotomie jusqu’à 360 degrés ab interno. Le chirurgien peut visualiser l’extrémité illuminée pendant l’enfilage pour s’assurer que le dispositif est placé avec précision dans le canal de Schlemm. Après l’enfilage, le chirurgien retire lentement le segment externe du cathéter afin de « sortir » du canal de Schlemm pendant que l’assistant chirurgical injecte du viscoélastique à travers l’extrémité du cathéter afin de dilater et de distendre le canal de Schlemm et les orifices du canal collecteur118
L’ABiC est réalisée à l’aide du système de microcathéter iTrack (EllexiScience, Fremont, CA), un microcathéter de 250 microns doté d’une fibre optique permettant de visualiser le cathéter lorsqu’il se trouve dans le canal de Schlemm. Après avoir pratiqué une goniotomie nasale, on avance le cathéter de 360 degrés dans le canal de Schlemm, puis on le retire lentement tout en effectuant une viscodilatation du canal et du système d’écoulement distal. Cette approche permet d’améliorer le système d’écoulement naturel sans destruction des tissus. En outre, on pense qu’elle diminue la hernie de la paroi interne du canal de Schlemm dans les canaux collecteurs distaux afin d’améliorer l’écoulement.
L’ABiC peut être pratiquée en conjonction avec l’extraction de la cataracte ou en tant que procédure autonome. Elle est indiquée pour le traitement du glaucome léger-modéré ainsi que pour le traitement du glaucome plus avancé et réfractaire. Gallardo et al. ont évalué l’efficacité de l’ABiC dans le cadre d’une étude de 12 mois sur un seul site. 75 yeux de 68 patients atteints de GPAO ont subi une ABiC : 41 yeux ont subi une ABiC autonome et 34 yeux ont subi une ABiC/phacoémulsification combinée. La PIO préopératoire moyenne dans les deux groupes était de 20,4 ± 4,7 mm Hg et a diminué à 13,3 ± 1,9 mm Hg 12 mois après l’opération. Il n’y avait pas de différence significative entre la réduction de la PIO dans les yeux ayant subi une ABiC autonome et dans les yeux ayant subi une ABiC/phacoémulsification combinée. La réduction moyenne de la PIO 12 mois après l’opération était de 32,3 % dans les deux groupes; 32,8 % dans le groupe ABiC autonome et 31,7 % dans le groupe ABiC/phacoémulsification. 84,9 % des yeux ont connu une réduction de la PIO de plus de 20 % par rapport à la valeur initiale. En outre, le nombre moyen de gouttes pour abaisser la PIO est passé de 2,8 ± 0,9 gouttes à 1,1 ± 1,1 goutte, ce qui représente une réduction de 60,0 % en moyenne. Un an après l’opération, 40 % des yeux n’avaient plus besoin de gouttes pour réduire la PIO119
Ab interno seule ou associée à une chirurgie de la cataracte pour le traitement du glaucome à angle ouvert
Objectif : Rendre compte de l’efficacité à 36 mois de la canaloplastie ab interno réalisée avec le microcatheter iTrack (Nova Eye Medical) en tant que procédure autonome ou combinée à une chirurgie de la cataracte120
Conception : Série de cas rétrospectifs d’un seul centre.
Participants : Yeux diagnostiqués avec un glaucome primaire à angle ouvert (GPAO).
Méthodes : Les yeux atteints de GPAO ont été traités soit par canaloplastie ab interno en tant que procédure autonome (iTrack seul), soit en conjonction avec une phacoémulsification (iTrack+phaco).
Principaux résultats : Les principaux résultats étaient les réductions moyennes de la pression intraoculaire (PIO) et le nombre de médicaments contre le glaucome à 12, 24 et 36 mois après l’intervention. Les critères d’évaluation secondaires étaient l’acuité visuelle et le taux de complications.
Quarante-quatre yeux de 44 patients atteints de glaucome à angle ouvert ont été inclus : 23 yeux dans le groupe iTrack seul et 21 yeux dans le groupe iTrack+phaco. Lorsque les deux groupes ont été analysés ensemble, les PIO et le nombre de médicaments ont été réduits de manière significative à 12 mois (P < 0,0001) et sont restés stables à 24 et 36 mois. Les PIO sont passées de 20,5 ± 5,1 mm Hg en préopératoire à 13,3 ± 2,1, 13,1 ± 2,4 et 13,3 ± 2,1 mm Hg à 12, 24 et 36 mois, respectivement; le nombre de médicaments est passé de 2,8 ± 0,9 en préopératoire à 1,1 ± 1,1, 1,0 ± 1,1 et 1,3 ± 1,3 à 12, 24 et 36 mois après l’opération, respectivement. Des résultats comparables de PIO ont été observés dans les groupes iTrack seul et iTrack+phaco, des valeurs de base 20,9 ± 6,1 et 20,0 ± 3,9 mm Hg, respectivement, à 13,2 ± 2,1 et 13,5 ± 2,2 mm Hg à 36 mois, respectivement. À 36 mois, 95,5 % des yeux avaient une PIO ≤ 17 mm Hg et 68,2 % des yeux prenaient ≤ 1 médicament. Aucune complication peropératoire ou postopératoire grave n’a été rapportée.
Conclusions : La canaloplastie ab interno réalisée avec le microcathéter iTrack s’est avérée efficace pour réduire la PIO et la dépendance aux médicaments. Des résultats comparables ont été observés lorsqu’elle est utilisée comme procédure autonome ou lorsqu’elle est combinée à une chirurgie de la cataracte.
C. STREAMLINE Surgical System
Le système chirurgical Streamline est un dispositif à usage unique conçu pour créer des goniotomies titrables et des canaloplasties localisées en une seule étape unifiée. Son utilisation a été approuvée par la Food and Drug Administration des États-Unis en octobre 2021 pour traiter les patients souffrant d’hypertension oculaire ou de glaucome à angle ouvert. Le dispositif offre aux chirurgiens une grande polyvalence, car il peut être utilisé chez les patients phaques ou pseudophaques, et en combinaison avec la chirurgie de la cataracte ou en tant que traitement indépendant. La pièce à main du système Streamline contient une canule en acier inoxydable, logée dans un manchon extérieur en polymère, tous deux situés en aval d’un réservoir de dispositif de viscosité ophtalmique (OVD). La partie supérieure de la pièce à main contient un bouton d’actionnement qui, lorsqu’il est enfoncé, rétracte le manchon extérieur. Cela permet d’exposer la canule interne tout en réalisant une injection bidirectionnelle d’OVD par ses deux orifices latéraux121


Deux orifices latéraux dans la canule interne de Streamline facilitent l’administration d’un agent viscoélastique dans le canal de Schlemm après une goniotomie avec le dispositif122
En peropératoire, le dispositif est utilisé sous visualisation directe avec l’aide d’une lentille gonioscopique. Le manchon extérieur est aplani contre le réseau trabéculaire (RT) et le bouton d’actionnement est enfoncé, ce qui permet à la canule de coupe de créer une goniotomie de 150 µm tout en injectant environ 7 µl d’OVD de manière bidirectionnelle dans le canal de Schlemm. Le bouton d’actionnement est ensuite relâché et la pièce à main rétractée, de sorte que le dispositif peut être déplacé vers une zone adjacente non traitée du RT, où la procédure peut être répétée. Le dispositif contient suffisamment d’OVD pour effectuer 8 applications, injectant un total de 56 µl d’OVD dans le canal de Schlemm sur plusieurs degrés de l’angle. Pour titrer la taille de la goniotomie formée par la ponction initiale dans le RT, le bouton de l’actionneur est maintenu enfoncé pour garder le manchon extérieur rétracté, et la canule est avancée de chaque côté dans une capacité de coupe le long du RT, avec pour objectif d’atteindre plus de 90° ou 3 heures d’horloge de goniotomie.
Avant l’insertion dans l’œil, le dispositif Streamline doit être amorcé juste à l’extérieur de l’incision cornéenne en appuyant sur le bouton de l’actionneur pour injecter l’OVD à travers la canule et débarrasser le manchon de toutes les bulles d’air retenues. Cette opération peut également être effectuée à l’intérieur de l’œil, juste à l’intérieur de la plaie, de part et d’autre de la vue. Le chirurgien doit également s’assurer d’avoir une prise confortable, mais stable sur la pièce à main, l’index ou le troisième doigt pouvant être manipulé, afin de permettre l’enfoncement du bouton d’actionnement.
La surface du bouton du Streamline est légèrement plus grande que celle de la plupart des autres dispositifs MIGS et, par conséquent, la force nécessaire pour appuyer sur le bouton peut être légèrement supérieure à celle à laquelle le chirurgien s’attend. Il est impératif d’avoir une prise ferme sur le dispositif pour s’assurer qu’il n’y a pas de glissement ou de mouvement vers le bas de la pièce à main lorsque le bouton d’actionnement est enfoncé. Si un gonioprisme mains libres est utilisé, la main supplémentaire peut être utilisée pour aider à soutenir la main dominante qui tient le dispositif lorsque le bouton est enfoncé.
Il est essentiel de s’exercer à l’utilisation du dispositif dans le laboratoire humide pour garantir une prise en main sûre et confortable du dispositif avant de se rendre dans la salle d’opération.
Il y a également quelques différences dans l’administration du traitement lui-même avec Streamline. Tout d’abord, le manchon bleu extérieur peut servir de guide pour un positionnement correct de la hauteur dans l’angle. Les évasements latéraux du manchon peuvent être alignés avec le RT et le manchon peut être doucement aplani contre le maillage avant l’activation du bouton. Une pression trop forte vers l’extérieur peut provoquer des stries cornéennes ou l’effondrement du RT dans le canal, tandis qu’une pression insuffisante vers l’extérieur empêchera l’entrée appropriée de la canule dans le canal. Lorsque l’on appuie sur le bouton d’actionnement, la pièce à main doit être maintenue en place pendant 2 secondes avant de passer à autre chose, afin de laisser le temps à l’OVD de s’écouler des deux côtés du canal de Schlemm. Enfin, le chirurgien doit savoir que la goniotomie et l’injection d’OVD réalisées par le système Streamline peuvent avoir peu ou pas de repères visuels pendant la procédure. Cela est dû en grande partie à la perturbation minimale des tissus que la procédure entraîne avec des microgoniotomies qui sont souvent trop petites pour être visualisées directement. Cependant, il existe plusieurs indices visuels qui peuvent confirmer le positionnement correct du dispositif et le traitement. Ces indices comprennent le reflux sanguin à travers les incisions de goniotomie lorsque la PIO tombe en dessous de la pression veineuse épisclérale, le blanchiment ou le déplacement du sang résidant dans le canal de Schlemm, la sortie de l’OVD à travers les goniotomies voisines et le blanchiment des vaisseaux épiscléraux en aval des degrés traités. Le chirurgien doit surveiller ces indices pour s’assurer que le dispositif est correctement placé et traité, tout en sachant qu’ils peuvent ne pas être évidents chez tous les patients malgré une utilisation correcte du dispositif122
Compte tenu de son développement relativement récent, les données des études rapportant les résultats du système chirurgical Streamline chez les patients atteints de glaucome sont jusqu’à présent limitées. L’une des premières études réalisées a été une série de cas prospective à un seul bras portant sur la réduction de la PIO et l’utilisation de médicaments à 6 mois chez des patients ayant subi une chirurgie de la cataracte avec le Streamline. La population étudiée était composée de 20 yeux atteints de glaucome primaire à angle ouvert (GPAO) léger à sévère. Après 6 mois de suivi, 89,5 % des patients ont obtenu une réduction moyenne de la PIO de 20 % ou plus, 42,1 % ne prenaient plus de médicaments et aucun événement indésirable n’a été signalé123
Un autre groupe a réalisé une série de cas rétrospectifs d’yeux atteints de glaucome à angle ouvert léger à sévère ayant subi une chirurgie de la cataracte avec Streamline. Après 6 mois de suivi, le taux de réussite chirurgicale, défini comme une réduction de la PIO de 20 % ou plus et/ou une réduction d’un médicament topique contre le glaucome, était de 66,7 %. Une complication a été signalée, à savoir un pic de PIO après l’opération, qui a été traité médicalement124
Analyse intérimaire des résultats cliniques du système chirurgical STREAMLINE® dans les yeux atteints de glaucome
Objectif : Caractériser les résultats cliniques d’une nouvelle procédure mini-invasive ab interno avec le système chirurgical STREAMLINE® pour la création de goniotomies incisionnelles et la viscodilatation du canal de Schlemm dans les yeux atteints de glaucome primaire à angle ouvert (GPAO) léger à sévère125
Méthodes : Dans le cadre d’une série de cas prospective, à bras unique, première chez l’homme, 20 yeux de 20 sujets atteints de GPAO léger à sévère ont subi des goniotomies incisionnelles et une viscodilatation du canal de Schlemm à la suite d’une extraction de la cataracte par phacoémulsification après l’élimination de tous les médicaments qui abaissent la pression intraoculaire (PIO). La partie chirurgie de l’angle a été réalisée avec une pièce à main à usage unique munie d’une microcanule qui crée des goniotomies précises à travers le réseau trabéculaire jusqu’au canal de Schlemm et injecte un petit volume de matériau viscochirurgical ophtalmique directement dans le canal grâce à un cathétérisme précis. Les résultats de cette analyse intermédiaire comprenaient la réduction moyenne de la PIO et des médicaments au cours des 6 mois de suivi, ainsi que la proportion d’yeux ayant atteint une réduction de la PIO ≥ 20 % par rapport à la ligne de base.
Résultats : Au mois 6, une réduction moyenne de la PIO de ≥ 20 % par rapport à la ligne de base a été obtenue dans 89,5 % des yeux (17/19). La PIO médicamenteuse moyenne (écart-type) au moment de la sélection était de 16,3 (± 3,6) mm Hg et la PIO de base non médicamenteuse (après le lavage) était de 23,5 (± 2,5) mm Hg. La PIO moyenne a été réduite de manière significative depuis le début jusqu’à 6 mois de suivi à 14,7 (2,4) mm Hg (p < 0,001), ce qui représente une réduction de la PIO de 8,8 mm Hg (36,9 %). Dans l’ensemble, 57,9 % (11/19) des yeux ont réduit leur dépendance aux médicaments abaissant la PIO d’au moins un médicament, et 42,1 % (8/19) n’avaient plus besoin de médicaments. La consommation moyenne de médicaments a été réduite de 2,0 (± 0,8) au moment du dépistage à 1,1 (± 1,1) à 6 mois (p < 0,001). Trois yeux ont eu des pics de PIO transitoires traités avec des médicaments topiques.
Conclusion : La création de goniotomies incisionnelles et la viscodilatation du canal de Schlemm ont réduit de façon sûre et efficace la PIO et le besoin de médicaments abaissant la PIO de façon cliniquement et statistiquement significative dans les yeux atteints de GPAO léger à sévère subissant une extraction de cataracte par phacoémulsification concomitante au cours des 6 premiers mois de suivi.
Amélioration de l’écoulement aqueux à travers l’espace suprachoroïdien
Contrairement aux MIGS basés sur le canal de Schlemm qui visent à améliorer la voie d’écoulement trabéculaire, les dispositifs MIGS suprachoroïdiens visent à tirer parti de la voie uvéosclérale pour réduire la PIO126. Ces dispositifs, illustrés à la figure 5, comprennent le micro-stent CyPass®, l’iStent SUPRA®, le shunt en or SOLX®, l’implant STARfloMC pour le glaucome et le MINIjectMC 127-130
L’espace suprachoroïdien a été exploré en tant que cible pour la réduction de la PIO au cours des 100 dernières années, et la capacité de l’exploiter de manière fiable et sûre pour abaisser la PIO semble désormais à portée de main.
L’innovation en matière de soins oculaires au cours des prochaines années impliquera très certainement l’utilisation de l’espace suprachoroïdien pour traiter un éventail de plus en plus large de maladies.

Le micro-stent CyPass ® montrant ses fenestrations par lesquelles l’humeur aqueuse s’écoule dans l’espace suprachoroïdien, ses anneaux de rétention qui aident à ancrer le dispositif, et sa mise en place dans l’œil (figure ci-haut)126
Le micro-stent CyPass (Alcon Laboratories, inc., Texas, États-Unis) est un dispositif en polyimide biocompatible52 Il est fenêtré sur toute sa longueur, comme le montre la figure ci-bas, avec des pores de 76 µm de diamètre qui permettent l’écoulement de l’eau52, 56. L’endoprothèse est introduite par un fil-guide et un applicateur dans l’espace supraciliaire (par une procédure ab interno), où elle est ensuite ancrée passivement avec des anneaux de rétention moulés54, 56. Bien que les premières études cliniques aient montré que l’implantation de ce dispositif entraîne une légère réduction de la PIO et des médicaments contre le glaucome, en août 2018, le CyPass a été retiré du marché mondial en raison de problèmes de sécurité liés à la perte de cellules endothéliales résultant de dispositifs mal positionnés34, 52, 131, 132


L’iStent SUPRA®, avec ses anneaux de retention; image reproduite avec l’autorisation de Healio, may 6, 202312
L’iStent SUPRA (Glaukos Corporation, Californie, États-Unis) est une itération différente des deux dispositifs iStent MIGS pour le canal de Schlemm dont il a été question précédemment. Il s’agit d’un petit dispositif recouvert d’héparine, composé de polyéthersulfone et de titane, légèrement incurvé pour suivre la courbure de la sclérotique et doté de crêtes pour améliorer la rétention de l’implant52, 124 Comme le microstent CyPass, l’iStent SUPRA est inséré par une incision ab interno56
Après des décennies sans avancées significatives dans cet espace, James Gills, MD, a développé en 1966 un implant en téflon qui a été placé ab externo dans la fente pour empêcher la fermeture spontanée. Cependant, ce dispositif a finalement échoué en raison de la difficulté d’implantation, de l’inflammation profonde et des pics de PIO133, 134. Une fois de plus, l’intérêt pour cet espace a diminué en faveur d’approches sous-conjonctivales plus traditionnelles de la chirurgie du glaucome.
L’iStent Supra mesurait 4 mm de long et est fabriqué en polyéthersulfone et en titane, avec une lumière de 165 µm recouverte d’héparine135=14. Les premiers rapports ont utilisé le travoprost postopératoire et ont démontré une réduction de la PIO de 30 à 50 % à 12 mois. Aucun événement indésirable majeur n’a été signalé. Les effets indésirables les plus fréquents étaient une hypotonie transitoire et des épanchements choroïdiens autolimités136, 137
L’iStent Supra avait reçu le marquage CE en 2010 et était évalué dans le cadre d’un essai clinique randomisé en vue d’obtenir l’approbation de la FDA138

La dérivation SOLX® gold, montrant ses deux plaques d’or et sa procédure d’implantation réalisée par une incision ab externo

L’implant STARfloMC pour le glaucome montrant sa tête en forme d’enclume conçue pour empêcher l’extrusion de la chambre antérieure, et sa géométrie multiporeuse caractérisée par des sphères creuses disposées en réseau régulier112, 129, 139

Le dispositif MINIjectMC montrant sa structure multiporeuse et son positionnement dans l’œil128
Ce dispositif est fabriqué à partir du matériau Star, propriété de la société, un silicium biocompatible contenant une microstructure géométrique poreuse qui favoriserait l’intégration avec les tissus environnants et réduirait la fibrose afin de préserver le flux. Le Miniject est implanté par une approche ab interno et seule une très petite partie du dispositif est exposée à la chambre antérieure afin de réduire les lésions des cellules endothéliales cornéennes140
La structure poreuse distinctive, souple et flexible de MINIject® offre de multiples avantages :
Le matériau STAR®, propriété d’iSTAR Medical, présente des propriétés anti-fibrotiques et anti-inflammatoires exceptionnelles;
L’implant poreux permet un écoulement naturel de l’humeur aqueuse, ce qui contribue à réduire la fibrose, à réduire les cicatrices et à augmenter la durabilité;
Il se conforme à l’anatomie de l’œil et s’intègre aux tissus environnants pour assurer l’efficacité du drainage à long terme.
L’essai STAR-I a porté sur 25 patients atteints d’un glaucome primaire à angle ouvert d’intensité légère à modérée, qui ont subi l’implantation de Miniject. Après un an, le dispositif a montré une réduction moyenne de la PIO de 32,6 %, 75 % des patients n’ayant plus besoin de médicaments. Il est important de noter qu’aucun événement indésirable oculaire grave n’a été signalé141
iSTAR Medical a annoncé en mai 2023, que plus de 1 000 patients ont été traités commercialement avec MINIject®, son implant de chirurgie mini-invasive du glaucome (MIGS). MINIject® est commercialisé en Allemagne, au RoyaumeUni, en Suisse, en Autriche et dans les pays nordiques. iSTARMedical prévoit une nouvelle expansion du marché dans d’autres régions géographiques en 2023 142
iSTAR Medical a annoncé en septembre 2023 des résultats positifs à trois ans de l’étude STAR-GLOBAL sur MINIject® Ces données ont été présentées lors du symposium d’iSTAR Medical qui s’est déroulé en juin dans le cadre du Congrès mondial du glaucome (WGC) à Rome, en Italie.
STAR-GLOBAL est un essai de prolongation portant sur la sécurité et l’efficacité à long terme pour les patients jusqu’à cinq ans de suivi. Les patients ayant reçu le dispositif MIGS supraciliaire MINIject® sont invités à s’inscrire à l’étude STARGLOBAL à l’issue d’un essai iSTAR Medical d’une durée de deux ans, afin de poursuivre le suivi de deux à cinq ans.
Données de STAR-GLOBAL
Le Dr Inder Paul Singh (The Eye Centers of Racine & Kenosha, WI, É.-U.) a présenté les données intermédiaires de 48 patients de l’essai STAR-GLOBAL qui ont achevé le suivi à trois ans, lors du symposium d’iSTAR Medical au WGC. Les résultats d’efficacité indiquent une réduction durable et significative de 36 % de la pression oculaire à trois ans, 42 % des patients n’ayant plus besoin de médicaments.
Un profil d’innocuité favorable, y compris la santé de la cornée, a été confirmé après trois ans de suivi, sans aucun événement indésirable grave lié au dispositif ou à la procédure au cours de la période de suivi de STAR-GLOBAL.
La trabéculectomie et la chirurgie de dérivation tubulaire restent les interventions incisionnelles les plus couramment pratiquées pour abaisser la pression intraoculaire (PIO) dans le traitement du glaucome modéré à sévère et réfractaire143. Ces méthodes chirurgicales permettent de remédier à l’adhésion sous-optimale associée aux traitements pharmacologiques144. Cependant, bien qu’elles soient efficaces pour abaisser la PIO, les techniques de chirurgie incisionnelle sont associées à la nécessité d’une prise en charge postopératoire importante143, 145
Certains chirurgiens préfèrent utiliser une approche ab externo parce qu’elle leur donne plus de liberté dans le positionnement et l’application de la mitomycine C146
Déviation de l’écoulement aqueux dans l’espace sous-conjonctival
A. Trabéculectomie/sclérectomie profonde
Depuis sa description par Cairns en 1968 et malgré quelques variantes décrites ultérieurement, la technique de trabéculectomie a peu changé et reste une chirurgie de référence dans le traitement du glaucome141. Le principe de fonctionnement de la trabéculectomie est basé sur l’évacuation de l’humeur aqueuse dans l’espace sous-conjonctival avec la création d’une bulle de filtration qui permettra ensuite de drainer l’humeur aqueuse dans les vaisseaux lymphatiques et veineux. Après désinsertion conjonctivale au limbe ou au fornix, un volet scléral mesurant environ 4 mm sur 5 mm est réalisé jusqu’à atteindre le trabéculum et l’ouvrir soit manuellement au couteau soit avec des instruments assistés. Ensuite le volet scléral est suturé afin de rétablir une contre-pression et éviter une hyperfiltration de l’humeur aqueuse en postopératoire immédiat.
Une suture ajustable au niveau du volet scléral peut être mise en place également pour réguler le débit de filtration au cours du suivi postopératoire et limiter les risques d’hypotonies précoces notamment. Enfin, une suture conjonctivale est réalisée afin d’obtenir une bulle de filtration. La baisse pressionnelle attendue est de l’ordre de 48 % par rapport à la PIO sans traitement préopératoire.
Cette baisse de PIO est supérieure à la baisse observée avec un traitement médical. Enfin, le risque d’échec chirurgical est de l’ordre de 17,9 à 20,7 % à cinq ans lors d’une première ou d’une deuxième trabéculectomie142. L’efficacité pressionnelle de cette intervention est très étroitement liée aux phénomènes de fibrose de la bulle de filtration. Afin d’améliorer le pronostic pressionnel de la chirurgie, des antimitotiques de type mitomycine ou 5-fluorouracile peuvent être appliqués en sous-ténonien et en regard de la sclère pour inhiber l’activité fibroblastique dans l’espace sous-conjonctival et limiter les phénomènes d’adhérence de la bulle de filtration. Par ailleurs ces produits peuvent également induire un cyclo-affaiblissement chimique en regard du site chirurgical et potentialiser la baisse de PIO.

La chirurgie conventionnelle pour traiter le glaucome crée une nouvelle ouverture dans le réseau. Cette nouvelle ouverture permet au liquide de s’écouler de l’œil et d’abaisser la pression intraoculaire147
Des antimétabolites sont généralement utilisés au cours de la trabéculectomie pour prévenir l’échec de l’hémostase dû à la cicatrisation de la plaie. Les antimétabolites les plus couramment utilisés sont le 5-fluorouracile (5-FU) ou la mitomycine C (MMC)148. Le 5-fluorouracile est un analogue de la pyrimidine qui bloque la synthèse de l’ADN. Il peut être appliqué sur le site chirurgical en imbibant une éponge chirurgicale et en la plaçant sur le site chirurgical scléral avant la création de la stomie, avant ou après la création d’un lambeau scléral149. L’éponge est retirée après un temps variable (en fonction des caractéristiques sous-jacentes du patient ou des préférences du chirurgien, l’éponge peut être retirée après 30 secondes à 5 minutes).
Le mmC peut également être injecté en préopératoire dans l’espace sous-conjonctival, puis irrigué. La trabéculectomie crée une bulle de filtration sous la conjonctive de l’œil, que l’on peut parfois apercevoir sous la paupière supérieure. Cette bulle est en quelque sorte la chambre de résorption de l’humeur aqueuse. Néanmoins, son évolution peut être marquée de complications imprévisibles et dont certaines sont potentiellement dévastatrices150
La trabéculectomie peut être envisagée lorsque les risques chirurgicaux sont supérieurs aux bénéfices potentiels. Les patients sont candidats à la trabéculectomie si leur pression intraoculaire les expose à un risque important de lésions glaucomateuses progressives entraînant un handicap visuel. Bien que l’étude CIGTS ait montré que le pronostic visuel était comparable chez les patients traités initialement par des médicaments et par la chirurgie, la plupart des médecins essaient un traitement médical avant de procéder à une intervention chirurgicale.
Toutefois, si la pression intraoculaire n’est pas correctement contrôlée par les médicaments ou si des obstacles importants s’opposent à l’utilisation régulière des médicaments (coût, observance, effets secondaires oculaires ou systémiques, inconvénients, handicap physique ou autres problèmes psychosociaux), il convient d’envisager une intervention chirurgicale.
La chirurgie au laser peut être pratiquée si une baisse modeste de la PIO est nécessaire, en particulier si les lésions du glaucome ne sont pas avancées. Cependant, la trabéculectomie est indiquée si le glaucome est modéré ou avancé, si le taux de progression est rapide, si l’intervention au laser a échoué ou s’il existe un risque important de progression future qui entraînera une incapacité symptomatique151
Technique chirurgicale
La trabéculectomie peut être pratiquée sous anesthésie locale ou générale. Une suture de traction (placée sur une épaisseur partielle à travers la cornée claire périphérique) est souvent utilisée pour une exposition adéquate du site chirurgical (quadrants supérieurs de l’œil). Une péritomie conjonctivale est créée pour exposer la sclérotique supérieure nue. Cette péritomie peut être basée sur le limbe ou sur le fornix151
Un lambeau scléral d’épaisseur partielle est créé dans la sclérotique supérieure, articulé au limbe. Il existe de nombreuses variations dans la forme (rectangulaire, triangulaire, trapézoïdale) et la taille de ce lambeau. Le volet scléral est disséqué vers l’avant jusqu’à ce que la zone gris bleuté du limbe soit exposée.
Une dissection de l’espace sous-conjonctival est ensuite effectuée afin de créer une voie d’écoulement aqueux. Une paracentèse est créée dans la cornée claire périphérique avant de créer une stomie dans la chambre antérieure par le dessous du volet scléral. Un matériau viscoélastique peut être injecté pour stabiliser la pression intraoculaire lors de la création de la stomie afin d’éviter un affaissement de la chambre antérieure. Il existe plusieurs façons de créer la stomie sous le volet scléral. Une lame est d’abord utilisée pour pénétrer dans la chambre antérieure juste derrière la charnière du volet scléral. L’entrée dans la chambre antérieure est ensuite élargie à l’aide de la lame, de ciseaux de Vannas et/ou d’un poinçon de Kelly.
Souvent, une iridectomie périphérique est créée à ce stade, en utilisant des pinces pour tirer l’iris périphérique à travers le site de stomie, et des ciseaux pour créer l’iridectomie. Dans les yeux pseudophaques, certains chirurgiens omettent cette étape chirurgicale. Des sutures (généralement en nylon 9-0 ou 10-0) sont ensuite utilisées pour fermer le volet scléral. Les sutures peuvent être placées de manière interrompue, ou des sutures libérables peuvent être placées. Le volet doit être fermé de manière suffisamment serrée pour que la chambre antérieure reste formée, mais de manière suffisamment lâche pour permettre un drainage aqueux sur les bords du volet scléral. La péritomie conjonctivale est ensuite refermée à l’aide de sutures résorbables ou en nylon.
Une injection sous-conjonctivale de corticostéroïdes peut être effectuée à la fin de l’intervention chirurgicale.
La sclérectomie profonde est l’autre chirurgie filtrante de référence152. Cette technique est basée sur un principe de fonctionnement similaire à la trabéculectomie avec pour objectif également de créer une bulle de filtration.
Cependant, cette technique chirurgicale se différencie de la trabéculectomie quant à la méthode d’évacuation de l’humeur aqueuse. En effet, la technique consiste à ouvrir le canal de Schlemm selon la même voie d’abord que la trabéculectomie et ensuite de retirer la paroi interne du canal de Schlemm.
Cette paroi interne correspond au trabéculum juxtacanaliculaire qui est responsable de 75 % des résistances à l’écoulement de l’humeur aqueuse, son ablation se traduit ainsi par une amélioration du flux d’évacuation sans pénétrer le globe oculaire. Le flux d’humeur aqueuse est ainsi mieux contrôlé, ce qui limite le risque de complications peropératoires et postopératoires. Cette technique chirurgicale peut éventuellement être suivie par une goniopuncture au laser nd:YAG du site opératoire pour améliorer le débit de filtration.
Une méta-analyse comparant ces deux techniques chirurgicales de référence montrait que la baisse de PIO était supérieure dans le groupe de patients traités par trabéculectomie que dans le groupe de patients traités par sclérectomie profonde et cette différence devenait non significative lorsque la mitomycine était utilisée en peropératoire dans les 2 groupes153. En revanche, le risque de développer une complication de type hypotonie oculaire, décollement choroïdien, effacement de chambre antérieur ou cataracte était significativement plus bas dans le groupe sclérectomie. Cependant, cette méta-analyse ne pouvait pas non plus analyser l’effet pressionnel et les complications sur le long terme.
La chirurgie non pénétrante du glaucome (NPGS) est utilisée de manière sélective sur les structures altérées responsables de l’hypertension oculaire. Elle est réalisée sans pénétrer dans le bulbe de l’œil et, contrairement à d’autres techniques largement utilisées, il s’agit essentiellement d’une chirurgie extraoculaire. Le chirurgien évite ainsi les complications possibles associées à la chirurgie pénétrante, comme la trabéculectomie, toujours considérée comme le traitement chirurgical de référence du glaucome à angle ouvert. Dans le glaucome primaire à angle ouvert et dans certains cas de glaucome secondaire, la résistance au drainage de l’humeur aqueuse est principalement produite par le trabéculum juxtacanaliculaire et la paroi interne du canal de Schlemm : ce sont les deux structures cibles du NPGS154
Le choix de la procédure à utiliser chez un patient atteint de glaucome doit être fait au cas par cas et il est extrêmement difficile de proposer un protocole de traitement standard. Trois types de procédures sont inclus dans ce groupe : la viscocanalostomie, la sclérectomie et, plus récemment, la canaloplastie. La canaloplastie est l’intervention qui, ces derniers temps, fait l’objet d’un plus grand consensus parmi les spécialistes de la chirurgie du glaucome. De plus en plus, ce type de chirurgie est pratiqué en combinaison avec la procédure de la cataracte (phacoémulsification).
Chirurgie non pénétrante du glaucome : la chirurgie du glaucome peut être divisée en deux grandes catégories : les techniques pénétrantes (PGS), trabéculectomie, et les techniques non pénétrantes (NPGS).
Les techniques non pénétrantes évitent de pénétrer dans la chambre antérieure, réduisant ainsi l’incidence des complications liées à l’hypotonie, des problèmes associés aux saignées, ainsi que des complications graves telles que l’endophtalmie. La résistance à l’écoulement aqueux est assurée par le réseau trabéculaire et la membrane de Descemet, ce qui permet de mieux contrôler le drainage aqueux. Les deux principales catégories de NPGS sont la sclérectomie profonde (SP) et la viscocanalostomie (VC). Dans le premier cas, l’eau est destinée à s’écouler par voie sous-conjonctivale, tandis que la viscocanalostomie vise à éliminer les bulles, l’eau s’écoulant par le canal de Schlemm. Outre le risque réduit de complications graves, la NPGS peut induire une inflammation postopératoire moindre, nécessitant un suivi moins intensif que la PGS. Les inconvénients de la NPGS sont qu’elle peut être moins efficace pour abaisser la pression intraoculaire que la PGS, et qu’elle présente une courbe d’apprentissage abrupte155
Efficacité et sécurité de la chirurgie du glaucome non pénétrante avec phacoémulsification par rapport à la chirurgie du glaucome non pénétrante : une méta-analyse
Objectif : Comparer l’efficacité clinique et la sécurité de la chirurgie non pénétrante du glaucome (NPGS) associée à la phacoémulsification (Phaco-NPGS) et de la NPGS seule156
91. Greenwood MD, Seibold LK, Radcliffe NM, Dorairaj SK, Aref AA, Román JJ, Lazcano-Gomez GS, Darlington JK, Abdullah S, Jasek MC, Bahjri KA, Berdahl JP. Goniotomy with a single-use dual blade: Short-term results. J Cataract Refract Surg. 2017 Sep;43(9):1197-1201. doi: 10.1016/j. jcrs.2017.06.046. PMID: 28991617.
92. Seibold L. K., Soohoo J. R., Ammar D. A., Kahook M. Y. Preclinical investigation of ab interno trabeculectomy using a novel dual-blade device. American Journal of Ophthalmology. 2013;155(3):524–529.e2.
93. SooHoo, J.R., L.K. Seibold, and M.Y. Kahook, Ab interno trabeculectomy in the adult patient. Middle East Afr J Ophthalmol. 2015;22(1):25-9.
94. Allingham RR, Damji KF, Freedman SF, Moroi SE, Rhee DJ, Shields MB. Shields textbook of glaucoma. Lippincott Williams & Wilkins; 2012 Mar 28.
95. https://eyewiki.aao.org/Kahook_Dual_Blade:_Ab_Interno_ Trabeculectomy
96. https://vijayanethralaya.com/micro-invasive-glaucomasurgeries-in-glaucoma-treatment/
97. Dorairaj S, Seibold LK, Radcliffe N, Aref A, Jimenez-Roman J, Lazcano-Gomex G, Darlington J, Mansouri K, Berdahl J. 12-Month Outcomes of Goniotomy Performed Using the Kahook Dual Blade Combined with Cataract Surgery in Eyes with Medically Treated Glaucoma. Adv Ther 2018; 35:1460-1469.
98. Maeda M, Watanabe M, Ichikawa K. Evaluation of trabectome in open-angle glaucoma. J Glaucoma. 2013;22(3):205-8.
99. Brian A. Francis, Kuldev Singh, Shan C. Lin, Elizabeth Hodapp, Henry D. Jampel, John R. Samples, Scott D. Smith, Novel Glaucoma Procedures: A Report by the American Academy of Ophthalmology. Ophthalmology, Volume 118, Issue 7, July 2011, Pages 1466-1480.
100. Maeda M, Watanabe M, Ichikawa K. Evaluation of trabectome in open-angle glaucoma. J Glaucoma. 2013;22(3):205-8.
Méthodes : Nous avons effectué une recherche systématique dans diverses bases de données et examiné les études qui avaient évalué les effets de la Phaco-NPGS ou de la NPGS seule pour les patients atteints de glaucome. Les résultats primaires comprenaient la pression intraoculaire (PIO) postopératoire et le nombre de médicaments antiglaucomateux postopératoires. Les résultats secondaires étaient la prévalence des complications, l’incidence de l’aiguilletage ou de la goniopuncture et le taux de réussite chirurgicale.
Résultats : Au total, 380 et 424 yeux ont été inclus dans les groupes NPGS seuls et Phaco-NPGS respectivement. La PIO postopératoire et le nombre de médicaments ont été significativement plus faibles dans le groupe PhacoNPGS que dans le groupe NPGS seul [différence moyenne pondérée (DMP) = -1,12, intervalle de confiance (IC) à 95 % : -2,11 à -0,12, P = 0,03; DMP = -0,31, IC à 95 % : -0,53 à -0,09, P = 0,006]. De plus, la prévalence des complications et des procédures postopératoires était significativement plus faible dans l’étude Phaco-NPGS que dans l’étude NPGS seule, alors qu’il n’y avait pas de différence significative quant au succès chirurgical.
Conclusion : La phaco-NPGS est supérieur à la seule NPGS dans la réduction de la PIO et des médicaments. Le Phaco-NPGS peut être recommandé pour les patients atteints de glaucome avec des cataractes coexistantes en raison de son efficacité supérieure, de la diminution des complications et des procédures postopératoires.
101. Francis BA, Minckler D, Dustin L, et al. Combined cataract extraction and trabeculotomy by the internal approach for coexisting cataract and open-angle glaucoma: Initial results. J Cataract Refract Surg; 34(7). 1096-1103.
102. Baerveldt, G. and Chuck, R. “Minimally Invasive Glaucoma Surgical Instrument and Method” US Patent (2005): Available at https://www.google.com/patents/US6979328
103. Minckler D., Baerveldt G., Ramirez M. A., Mosaed S., Wilson R., Shaarawy T., Zack B., Dustin L. and Francis B. “Clinical Results with the Trabectome, a Novel Surgical Device for Treatment of Open-Angle Glaucoma” Transactions of the American Ophthalmological Society 104, (2006): 40–50.
104. Kaplowitz K., Schuman J. S., and Loewen N. A. “Techniques and Outcomes of Minimally Invasive Trabecular Ablation and Bypass Surgery” The British journal of ophthalmology 98, no. 5 (2014): 579–585.
105. Bussel I. I., Kaplowitz K., Schuman J. S., Loewen N. A., and Trabectome Study Group. “Outcomes of Ab interno Trabeculectomy with the Trabectome after Failed Trabeculectomy” The British journal of ophthalmology 99, no. 2 (2015): 258–262.
106. Tojo N., Abe S., Miyakoshi M., and Hayashi A. “Comparison of Intraocular Pressure Fluctuations before and after Ab interno Trabeculectomy in Pseudoexfoliation Glaucoma Patients” Clinical ophthalmology 11, (2017): 1667–1675.
107. https://crstodayeurope.com/articles/omni-surgical-system/ early-experience-with-the-omni-surgical-system/
108. https://www.sightsciences.com/us/sight-scienceslaunches-the-ergo-series-of-the-omni-surgical-system/
109. Sarkisian S, Mathews B, Ding K, Patel A, Nicek Z. 360o abinterno trabeculotomy in refractory open-angle glaucoma. Clinical Ophthalmology 2019; 13: 161-168.
110. https://www.ncbi.nlm.nih.gov/pmc/articles/PMC8313377/ 111. https://glaucomatoday.com/articles/2015-nov-dec/abinterno-canaloplasty
112. Klink T, Panidou E, Kanzow-Terai B, et al. Are there filtering blebs after canaloplasty ? J Glaucoma. 2012;21(2):89-94.
113. Lewis RA, von Wolff K, Tetz M, et al. Canaloplasty: threeyear results of circumferential viscodilation and tensioning of Schlemm’s canal using a microcatheter to treat openangle glaucoma. J Cataract Refract Surg. 2011;37:682-690.
114. Bull H, von Wolff K, Korger N, Tetz M. Three-year canaloplasty outcomes for the treatment of open-angle glaucoma: European study results. Graefes Arch Clin Exp Ophthalmol. 2011;249:1537-1545.
115. Grieshaber MC, Fraenkl S, Schoetzau A, et al. Circumferential viscocanalostomy and suture canal distension (canaloplasty) for whites with open-angle glaucoma. J Glaucoma. 2011;20:298-302.
116. Peckar CO, Körber N. Canaloplasty for open angle glaucoma: a three years critical evaluation and comparison with viscocanalostomy [in German]. Spektrum der Augenheilkunde. 2008;22(4):240-246.
117. Brüggemann A, Despouy JT, Wegent A, Müller M. Intraindividual comparison of canaloplasty versus trabeculectomy with mitomycin C in a single-surgeon series. J Glaucoma. 2013;22(7):577-583.
118. Klink T, Sauer J, Körber NJ, et al. Quality of life following glaucoma surgery: canaloplasty versus trabeculectomy. Clin Ophthalmol. 2014;18;9:7-16.
119. Gallardo M, Supnet R, Ahmed II. Viscodilation of Schlemm’s Canal for the Reduction of IOP Via an Ab-interno Approach. ClinicalOphthalmology 2018; 12: 2149-2155.
120. https://www.sciencedirect.com/science/article/pii/ S2589419622000254
121. New World Medical. New World Medical announces launch details for the Streamline Surgical System. News release. March 1, 2022. Accessed June 20, 2023. https://www. newworldmedical.com/new-world-medical-announceslaunch-details-for-the-streamline-surgical-system/
122. https://www.glaucomaphysician.net/issues/2023/ september-2023/surgical-pearls-for-the-streamlinesurgical-system
123. Lazcano-Gomez G, Garg SJ, Yeu E, Kahook MY. Interim analysis of Streamline surgical system clinical outcomes in eyes with glaucoma. Clin Ophthalmol. 2022;16:1313-1320. doi:10.2147/OPTH.S358871
124. Temple H, Grove N, Patnaik J, Kahook M, Seibold L. Clinical outcomes with the Streamline Surgical System in mild to severe open angle glaucoma. Presented at: the American Glaucoma Society Meeting; Austin, TX; March 2023.
125. https://www.ncbi.nlm.nih.gov/pmc/articles/PMC9058234/
126. Shah M. Micro-invasive glaucomasurgery an interventional glaucoma revolution. Eye Vis. 2019;6:29.
127. Samples JR, Ahmed IIK. Surgical innovations in glaucoma. New York, NY: Springer; 2014.
128. Denis P, Hirneiß C, Reddy KP, Kamarthy A, Calvo E, Hussain Z, et al. A first-in-human study of the efficacy and safety of MINIject in patients with medically uncontrolled open-angle glaucoma (STAR-I). Ophthalmol Glaucoma. 2019;2:290–7.
129. Caretti L, Buratto L. Glaucoma surgery: Treatment and Techniques. Cham, Switzerland: Springer International Publishing; 2018.
130. Kammer JA, Mundy KM. Suprachoroidaldevices in glaucomasurgery. Middle East Afr J Ophthalmol. 2015;22:45–52.
131. García-Feijoo J, Rau M, Grisanti S, Grisanti S, Höh H, Erb C, et al. Supraciliary micro-stent implantation for openangle glaucoma failing topical therapy: 1-year results of a multicenter study. Am J Ophthalmol. 2015;159:1075–.e1.
132. Hoeh H, Vold SD, Ahmed IK, Anton A, Rau M, Singh K, et al. Initial clinical experience with the CyPass microstent: Safety and surgical outcomes of a novel supraciliary microstent. J Glaucoma. 2016;25:106–12.
133. Gills JP, Jr., Paterson CA, Paterson ME. Mode of action of cyclodialysis implants in man. Invest Ophthalmol. 1967;6(2):141-144.
134. Gills JP. Cyclodialysis implants in human eyes. Am J Ophthalmol. 1966;61(5):841-846.
135. Figus M, Posarelli C, Passani A, et al. The supraciliary space as a suitable pathway for glaucoma surgery: ho-hum or home run ? Surv Ophthalmol. 2017;62(6):828-837.
136. Myers JS. Three-year follow-up outcomes after MIGS with two trabecular micro-bypass stents, one suprachoroidal stent and travoprost in patients with refractory OAG and prior trabeculectomy. Paper presented at: AGS Annual Meeting; March 3, 2016; Fort Lauderdale, FL.
137. Junemann A. Twelve-month outcomes following ab interno implantation of suprachoroidal stent and postoperative administration of travoprost to treat open angle glaucoma. Paper presented at: ESCRS Annual Meeting; 2013; Amsterdam, Netherlands.
138. Multicenter investigation of the Glaukos suprachoroidal stent model G3 in conjunction with cataract surgery. https://clinicaltrials.gov/ct2/show/ NCT01461278 ?term=glaukos&rank=2. Accessed May 1, 2019.
139. Fili S, Wölfelschneider P, Kohlhaas M. The STARflo glaucoma implant: preliminary 12 months results. Graefe’s Arch Clin Exp Ophthalmol. 2018;256:773–81.
140. https://www.istar-medical.com/treatments/miniject-migs/
141. iStar Medical. iStar Medical's Miniject maintains exceptional results in first-in-human trial one year post-surgery (STAR-I) [press release]. December 19, 2018. www. istarmed.com/wp-content/uploads/2018/12/iSTAR_ MINIject-FIH-trial-1-year-results-EN.pdf.
142. https://www.istar-medical.com/1000-patients-benefitingfrom-miniject/ ?categorieSource=63
143. Gedde SJ, Feuer WJ, Shi W, Lim KS, Barton K, Goyal S, et al. Treatment outcomes in the primary tube versus trabeculectomy study after 1 year of follow-up. Ophthalmology. 2018;125(5):650–63.
144. Jones JP, Fong DS, Fang EN, Mesirov CA, Patel V. Characterization of glaucoma medication adherence in Kaiser Permanente Southern California. J Glaucoma. 2016;25(1):22–6.
145. Gedde SJ, Schiffman JC, Feuer WJ, Herndon LW, Brandt JD, Budenz DL. Treatment outcomes in the Tube Versus Trabeculectomy (TVT) study after five years of follow-up. Am J Ophthalmol. 2012;153(5):789–803.e2.
146. Tan NE, Tracer N, Terraciano A, Parikh HA, Panarelli JF, Radcliffe NM. Comparison of safety and efficacy between ab interno and ab externo approaches to Xen Gel Stent placement. Clin Ophthalmol. 2021;15:299-305.
147. https://commons.wikimedia.org/wiki/File:Conventional_ surgery_to_treat_glaucoma_EDA11.JPG
148. Cairns JE. Trabeculectomy. Preliminary report of a new method. Am J Ophthalmol. 1968;66:673-9.
149. AGIS Investigators. The Advanced Glaucoma Intervention Study (AGIS): 11. Risk factors for failure of trabeculectomy and argon laser trabeculoplasty. Am J Ophthalmol. 2002;134:481-98.
150. https://www.associationfranceglaucome.fr/le-traitementchirurgical-du-glaucome-en-2020/
151. https://eyewiki.aao.org/Trabeculectomy
152. Mendrinos E, Mermoud A, Shaarawy T. Nonpenetratingglaucomasurgery. Surv Ophthalmol. 2008;53:592-630.
153. Rulli E, Biagioli E, Riva I et al. Efficacy and safety of trabeculectomy vs nonpenetrating surgical procedures: a systematic review and meta-analysis. JAMA Ophthalmol. 2013;131:1573-82
154. https://link.springer.com/ chapter/10.1007/978-3-319-64855-2_4
155. https://www.college-optometrists.org/professionaldevelopment/college-journals/optometry-in-practice/ all-oip-articles/volume-16,-issue-4/2015-11-nonpenetratingglaucomasurgery
156. Xiao JY, Liang AY, Wang YL, Cheng GW, Zhang MF. Efficacy and safety of non-penetrating glaucoma surgery with phacoemulsification versus non-penetrating glaucoma surgery: a Meta-analysis. Int J Ophthalmol. 2021 Dec 18;14(12):1970-1978. doi: 10.18240/ijo.2021.12.24. PMID: 34926216; PMCID: PMC8640778.


L’uvéite est définie comme une inflammation du tractus uvéal, l’iris, le corps ciliaire et la choroïde. Cependant, la rétine, le liquide de la chambre antérieure et le vitré sont souvent impliqués. Environ la moitié des cas sont idiopathiques; les causes identifiables comprennent les traumatismes, les infections et les maladies systémiques, bon nombre d’entre elles étant auto-immunes. Les symptômes comprennent une baisse de la vision, une douleur, une rougeur, une photophobie et des myodésopsies (corps flottants). Bien que le diagnostic d’uvéite soit clinique, l’identification de la cause nécessite généralement des examens. Le traitement dépend de la cause, mais comprend généralement des corticostéroïdes, topiques, périoculaires ou systémiques avec des collyres mydriatiques-cycloplégiques. D’autres immunosuppresseurs non corticostéroïdes peuvent être utilisés dans les cas graves et réfractaires d’uvéite1
On sait que l’uvéite est une inflammation du tractus uvéal. Les uvéites sont classées anatomiquement en :
L’uvéite antérieure : localisée principalement dans le segment antérieur, comprend l’iritis (inflammation de seulement la chambre antérieure) et l’iridocyclite (inflammation de la chambre antérieure et du corps vitré antérieur);
Uvéite intermédiaire : localisée dans la cavité vitréenne et/ou la pars plana (partie du corps ciliaire qui s’étend postérieurement au-delà de la jonction de l’iris et de la sclère);
L’uvéite postérieure : toute forme de rétinite, de choroïdite ou d’inflammation de la papille optique;
Panuvéite : inflammation impliquant des structures antérieures, intermédiaires et postérieures.
L’uvéite est également classée selon son mode d’apparition (soudaine ou insidieuse), sa durée (limitée ou persistante) et son évolution (aiguë, récurrente ou chronique).
Les causes d’uvéites antérieures comprennent
Cause idiopathique ou post-chirurgicale (cause la plus fréquente)
Traumatisme
Spondylarthropathies
Arthrite juvénile idiopathique
Infection herpétique (virus de l’herpès simplex [HSV], virus de la varicelle et du zona [VZV], et cytomégalovirus [CMV])
Néphrite tubulo-interstitielle et uvéite
Les causes d’uvéite intermédiaire comprennent
Cause idiopathique (la plus courante)
Sclérose en plaques
Sarcoïdose
Tuberculose
Syphilis
Maladie de Lyme (dans les régions endémiques)
Les causes d’uvéite postérieure (rétinite) comprennent
Cause idiopathique (la plus courante)
Toxoplasmose
CMV (chez les patients immunodéprimés)
HSV/VZV
Sarcoïdose
Syphilis
Tuberculose
Les causes de la panuvéite comprennent
Cause idiopathique (la plus courante)
Sarcoïdose
Tuberculose
Syndrome de Vogt-Koyanagi-Harada
Syphilis
Il existe peu de médicaments systémiques qui entraînent une uvéite (le plus souvent antérieure). Les exemples en sont des sulfamides, les bisphosphonates (inhibiteurs de la résorption osseuse), la rifabutine et le cidofovir, de même que les inhibiteurs de point de contrôle tels que le nivolumab et l’ipilimumab1
OPDIVO® (nivolumab) est un médicament délivré sur ordonnance utilisé pour traiter les adultes et les enfants âgés de 12 ans et plus atteints d’un type de cancer de la peau appelé mélanome2
L’ipilimumab, vendu sous le nom de Yervoy, est un anticorps monoclonal qui active le système immunitaire en ciblant CTLA-4, un récepteur protéique qui régule le système immunitaire3
Les lymphocytes T cytotoxiques (CTL) peuvent reconnaître et détruire les cellules cancéreuses. Cependant, un mécanisme inhibiteur interrompt cette destruction. L’ipilimumab désactive ce mécanisme inhibiteur et renforce la réponse immunitaire de l’organisme contre les cellules cancéreuses.
L’ipilimumab a été approuvé par la Food and Drug Administration (FDA) en mars 2011 pour le traitement du mélanome, du carcinome à cellules rénales (CCR), du cancer colorectal, du carcinome hépatocellulaire, du cancer du poumon non à petites cellules (CPNPC), du mésothéliome pleural malin et du cancer de l’œsophage.
L’uvéite englobe un groupe de maladies oculaires inflammatoires qui peuvent causer des dommages dévastateurs aux structures oculaires4. On estime qu’elle est responsable d’environ 10 % des pertes visuelles ou d’environ 30 000 nouveaux cas de cécité légale aux États-Unis chaque année1 L’uvéite touche généralement des patients dans la force de l’âge et, comme des études épidémiologiques plus récentes démontrent des taux de prévalence et d’incidence plus élevés que prévu, l’uvéite représente un fardeau important pour le système de soins de santé américain.
L’uvéite est classée en deux catégories : infectieuse et non infectieuse. L’uvéite non infectieuse peut survenir dans le cadre d’une maladie auto-immune systémique ou d’une maladie auto-immune localisée à l’œil. Les étiologies de l’uvéite non infectieuse comprennent l’uvéite antérieure associée à HLA-B27, le syndrome de l’uvéite de Fuchs, la sarcoïdose, Vogt-Koyanagi-Harada (VKH), l’ophtalmie sympathique, la choriorétinopathie en tache d’oiseau, la choroïdite multifocale, la choroïdite serpigineuse et la maladie de Behçet.
Les uvéites non infectieuses représentent la majorité des cas d’uvéite (67-90 %) dans les pays développés5-7. La plupart des études épidémiologiques antérieures combinent les étiologies infectieuses et non infectieuses. Bien que les facteurs de risque des uvéites infectieuses et non infectieuses puissent se chevaucher, les causes de l’inflammation sont intrinsèquement différentes et nécessitent des approches de prise en charge différentes.
Aux États-Unis, une seule étude répondait spécifiquement à nos critères de recherche concernant la prévalence de l’uvéite non infectieuse de l’adulte. Thorne et coll. ont utilisé une base de données de demandes de remboursement de frais médicaux de près de 4 millions de patients aux États-Unis et ont montré que la prévalence de l’uvéite non infectieuse de l’adulte était de 121 pour 100 000 personnes. Compte tenu de la méthodologie de l’étude, Thorne et coll. n’ont pas été en mesure d’évaluer l’incidence de l’uvéite non infectieuse6
Au cours des 50 dernières années, trois grandes études épidémiologiques de l’uvéite basées sur la population ont été réalisées aux États-Unis. Elles portaient sur les causes infectieuses de l’uvéite, telles que l’herpès, l’histoplasmose, la toxoplasmose, la tuberculose, la neurorétinite à bartonella et le VIH/SIDA5, 8, 9. Deux études proviennent du système de santé Kaiser Permanente : l’une à Hawaï (Pacific Ocular Inflammation Study) et l’autre en Californie du Nord (Northern California Epidemiology of Uveitis Study).
L’étude Pacific Ocular Inflammation Study a révélé une incidence annuelle d’uvéite de 24,9, tandis que l’étude Northern California a révélé une incidence de 52,4 cas d’uvéite pour 100 000 personnes-années5, 8. La troisième étude, réalisée par la Pacific Northwest Veterans Administration (VA), a révélé que l’incidence annuelle de l’uvéite était de 25,6 pour 100 000 personnes-années9. Plusieurs raisons peuvent expliquer la grande variabilité de l’incidence de l’uvéite entre ces études, notamment les caractéristiques démographiques des populations étudiées.
Si les données sur l’incidence de l’uvéite sont utiles pour comprendre le taux de nouveaux cas au cours d’une période donnée, la prévalence de l’uvéite peut être plus significative, car de nombreux patients atteints d’uvéite peuvent développer une évolution chronique et/ou récurrente. L’étude de population menée en Californie du Nord a rapporté une prévalence de 114,5 pour 100 000 adultes5 = (6), ce qui est similaire à la prévalence rapportée par Thorne et coll. de 121 pour 100 000 personnes6 = (7). Cependant, il n’est pas possible de comparer directement les deux études, car l’étude de la Californie du Nord incluait des cas d’uvéite infectieuse. Dans l’étude de la Veterans Administration, la prévalence était plus faible (69 pour 100 000 personnes), probablement en raison d’une population essentiellement masculine par rapport à d’autres études9 = (13). De même, la population étudiée dans l’étude Pacific Ocular Inflammation du système de santé Kaiser à Hawaï a contribué à une prévalence plus faible de l’uvéite de 58 pour 100 000, probablement parce que les habitants des îles du Pacifique ont une prévalence plus faible de l’uvéite par rapport à d’autres groupes raciaux/ethniques étudiés dans d’autres études basées sur la population8 = (12)
Bien qu’il soit adapté à chaque patient, le paradigme de traitement de l’inflammation intraoculaire implique généralement un contrôle initial rapide de l’inflammation, généralement à l’aide de corticostéroïdes systémiques ou locaux, ainsi que l’instauration concomitante ou ultérieure d’un traitement immunomodulateur à base de stéroïdes en cas d’inflammation grave nécessitant un contrôle plus poussé, ou si la maladie est connue pour être particulièrement destructrice, comme dans le cas de la granulomatose avec polyangéite (anciennement connue sous le nom de granulomatose de Wegener), de la maladie de Behçet et de la sclérite nécrosante. Une fois l’inflammation contrôlée, les corticostéroïdes systémiques sont diminués et arrêtés afin de réduire au minimum et de prévenir les effets indésirables.
Les complications les plus fréquentes comprennent
Cataracte (secondaire au processus pathologique et/ou au traitement par corticostéroïdes);
L’œdème maculaire cystoïde (la cause la plus fréquente de diminution de la vision en cas d’uvéite);
Glaucome (secondaire au processus pathologique et/ou au traitement par corticostéroïdes);
Décollement de la rétine;
Kératopathie en bande (dépôt de calcium en forme de bande à travers la cornée);
Néovascularisation de la rétine, du nerf optique, ou de l’iris;
Hypotonie (une pression intraoculaire trop faible pour soutenir la santé de l’œil).
Traitements de l’uvéite
Corticostéroïdes (habituellement topiques) et parfois d’autres médicaments immunosuppresseurs;
Médicaments mydriatiques-cycloplégiques;
Parfois, médicaments antimicrobiens;
Parfois, traitement chirurgical.
Le traitement d’une inflammation active implique habituellement des corticostéroïdes administrés par voie topique (par exemple, acétate de prednisolone à 1 %, 1 goutte toutes les heures pendant le jour en cas d’inflammation sévère) ou par injections périoculaires, accompagnés d’un médicament mydriatique-cycloplégique (par exemple, homatropine en gouttes à 2 % ou 5 % ou cyclopentolate à 0,5 % ou 1,0 % en gouttes, l’un ou l’autre médicament donné de 2 à 4 fois/ jour, en fonction de la sévérité de l’uvéite). Les antibiotiques sont utilisés pour traiter certaines uvéites infectieuses.
Les cas particulièrement graves ou chroniques peuvent nécessiter des corticostéroïdes systémiques ou des immunosuppresseurs systémiques non stéroïdiens. Par exemple,
Prednisone 1 mg/kg par voie orale 1 fois/jour;
Immunodépresseurs systémiques non stéroïdiens (par exemple, méthotrexate 15 à 25 mg par voie orale 1 fois/ semaine; mycophénolate mofétil 500 mg 2 fois/jour pendant 2 semaines, suivis d’une dose d’entretien de 1 à 1,5 g par voie orale 2 fois/jour selon la tolérance; adalimumab10, dose initiale de 80 mg, suivie de 40 mg par voie sous-cutanée toutes les 1 à 2 semaines);
Infliximab 5 à 10 mg/kg IV toutes les 4 semaines;
Un traitement supplémentaire pour les cas graves ou chroniques peut nécessiter une photothérapie laser, une cryothérapie trans-sclérale appliquée à la périphérie de la rétine, ou l’ablation chirurgicale du vitré (vitrectomie)10-12
Stéroïdes, immunomodulateurs ou les deux ?
Selon les experts, il est courant de commencer par des stéroïdes. « Je dirais que dans la majorité des cas, on traite d’abord avec des stéroïdes topiques et oraux, puis, en fonction des résultats des examens de laboratoire et de la réaction du patient, et selon que la maladie risque d’être chronique ou de menacer la vision, il peut être nécessaire de passer à un agent d’épargne stéroïdienne à plus long terme », explique le Dr Henry13
La Dre Arepalli recueille des informations lors de l’instauration des stéroïdes. « En général, je commence par des stéroïdes topiques pour deux raisons : tout d’abord, j’établis une relation avec le patient, ce qui me permet de voir comment il tolère un régime et dans quelle mesure il sera fidèle au traitement, explique-t-elle. C’est aussi un moyen facile d’arrêter si quelque chose me surprend dans le bilan et que je veux changer d’orientation. Enfin, cela m’aide à tester la façon dont le patient va réagir aux stéroïdes, par exemple s’il va développer une réaction à la pression ».
Le plus souvent, ses patients ont besoin d’un traitement par immunomodulateurs. « À Emory, je vois souvent des patients de niveau tertiaire qui n’ont pas réussi à prendre des stéroïdes topiques ou oraux, explique la Dre Arepalli. Avec ces patients, je passe souvent à l’immunosuppression ou au traitement local assez rapidement parce que je vois des signes d’inflammation incontrôlée ».
Dans le cas d’une maladie agressive, une prise en charge précoce et énergique est souvent nécessaire, explique le Dr Henry. « Une erreur fréquente est de ne pas traiter suffisamment. Il faut écraser l’inflammation rapidement et la réduire de manière structurée. En réalité, les problèmes sont plus importants si l’on ne calme pas l’inflammation rapidement et qu’on la laisse s’installer, explique-t-il. Je pense que les patients finissent par aller plus mal de cette manière. Si vous les maintenez sous stéroïdes topiques pendant une longue période, il est essentiel de surveiller la pression oculaire. Si un patient répond aux stéroïdes, il faut le surveiller et le traiter également ».
Le choix d’une thérapie immunomodulatrice (TIM) à long terme est une décision importante. « Quels sont les seuils qui incitent l’ophtalmologiste traitant à recommander une TIM ? » demande Sam S. Dahr, MD, MS, directeur de la division Rétine du département Ruiz d’ophtalmologie et de sciences visuelles de l’école de médecine McGovern de l’Université du Texas à Houston. « En cas d’uvéite antérieure chronique ou récurrente, la prévention des séquelles anatomiques telles que le glaucome inflammatoire, la cataracte, les synéchies postérieures progressives, les synéchies antérieures périphériques, la kératopathie en bande et l’œdème maculaire peuvent également indiquer le besoin d’une TIM. En ce qui concerne l’uvéite intermédiaire, un œdème maculaire chronique récidivant après un traitement local par injection intravitréenne de stéroïdes est souvent l’indication d’une TIM. En cas d’uvéite postérieure ou de panuvéite, un œdème maculaire, une cicatrice choriorétinienne, une néovascularisation choroïdienne inflammatoire, une dégénérescence rétinienne inflammatoire, une perte de champ visuel ou une vascularite rétinienne sévère peuvent être des indications d’un traitement immunomodulateur. »
« Pour répondre à la question de savoir s’il faut ou non procéder à une TIM, nous utilisons tous nos paramètres, poursuit-il. Nous utilisons notre examen oculovisuel. Nous pouvons utiliser la TCO, l’angiogramme à la fluorescéine et les champs visuels. Si nous avons le sentiment que la maladie progresse ou va progresser en raison de sa nature, nous devons alors passer à l’étape suivante et nous orienter vers une thérapie immunomodulatrice ».
L’image de
un traitement par stéroïdes intravitréens et une thérapie immunomodulatrice13 (Avec l’aimable autorisation de Sam S. Dahr, MD, MS)
Catégorisation de l’uvéite
« Je pense que le plus difficile est que l’uvéite est hétérogène», explique le docteur Christopher R. Henry, spécialiste de la rétine médicale et chirurgicale exerçant à Houston.
« L’uvéite englobe des centaines d’affections oculaires différentes qui peuvent être auto-immunes, infectieuses ou masquées. Il existe un large spectre en termes de gravité de la maladie, de risque pour la vue et de stratégies de traitement. Par exemple, un problème tel qu’une uvéite antérieure aiguë, unilatérale et isolée peut être très facile à traiter, mais une panuvéite chronique grave et bilatérale sera probablement beaucoup plus difficile à traiter13 »
Le Dr Henry précise qu’il faut examiner certains facteurs clés avant de procéder au traitement. Il faut évaluer la gravité de la maladie :
Maladie unilatérale ou bilatérale;
Localisation anatomique : antérieure, intermédiaire, postérieure ou panuvéite;
Maladie aiguë ou chronique;
Degré d’agressivité du processus;
Degré de perte de vision au départ;
Probabilité d’une évolution rapide.
Dans la majorité des cas, je demande des examens de laboratoire, sauf s’il s’agit d’une uvéite antérieure simple et isolée, pour essayer de déterminer la cause. Les examens de laboratoire seront vraiment motivés par l’aspect clinique de la maladie.

Cette femme de 58 ans présente une uvéite intermédiaire idiopathique depuis 30 ans13. Sa vision est actuellement de 6/60 (20/200) bilatéralement. La patiente avait des antécédents documentés d’œdème maculaire au cours des 10 à 15 premières années de sa maladie, traité uniquement avec des stéroïdes topiques. Ce cas montre qu’un œdème maculaire insuffisamment traité peut entraîner un amincissement de la fovéa et une perte de la vision centrale.
Pour l’instant, les gens se concentrent sur les cytokines et les récepteurs, mais il existe de nombreuses cibles potentielles pour les produits biologiques dans l’œil, notamment les molécules d’adhésion, le système du complément, les chimiokines, le stress oxydatif, les facteurs de croissance, les inflammasomes et les systèmes d’ubiquitine-protéasome. Ce domaine a le potentiel de s’épanouir réellement au cours des 10 ou 20 prochaines années.
Les anti-TNFα
Parmi les différentes classes de produits biologiques systémiques, les bloqueurs du facteur de nécrose tumorale (TNF) sont les plus couramment étudiés et utilisés pour l’uvéite : certains bloquent le TNF circulant, tandis que d’autres bloquent à la fois le TNF circulant et le TNF lié à la membrane14
Les bloqueurs du TNF sont fabriqués à l’aide de techniques de biologie moléculaire et sont généralement des anticorps monoclonaux, ce qui signifie qu’ils sont très spécifiques dans les protéines qu’ils ciblent dans le système immunitaire. En ciblant le TNF, ils neutralisent essentiellement ce médiateur pro-inflammatoire de la cascade immunitaire. Parmi les différentes classes de produits biologiques systémiques, les bloqueurs du facteur de nécrose tumorale (TNF) sont les plus couramment étudiés et utilisés pour l’uvéite15
La science fondamentale qui sous-tend l’utilisation des bloqueurs de TNF dans l’uvéite est assez solide. En utilisant une souris préclinique, les chercheurs ont montré que les cellules de la rétine enflammée, les cellules microgliales de la rétine et les macrophages infiltrants, produisent du TNF et démontré comment sa neutralisation modifie la maladie.
Il est bien établi que le TNF est un facteur de l’uvéite.
Il augmente dans l’œil et le sérum des patients atteints de certains types d’uvéites intermédiaires et postérieures non infectieuses et de panuvéites, et il diminue chez les patients qui contrôlent leur maladie.
Infliximab et adalimumab. En juillet 2016, l’adalimumab (Humira) est devenu le premier et le seul médicament biologique à recevoir l’approbation de la FDA pour l’uvéite. « Comme son nom commercial l’indique, il est fabriqué à partir de protéines humaines, explique le Dr Lee. Plus le produit biologique est humain, moins il est probable que le système immunitaire le reconnaisse comme étranger16 ».
L’infliximab (Remicade) est un autre inhibiteur du TNF plus couramment utilisé pour l’uvéite. Il s’agit d’un exemple d’anticorps monoclonal modifié contenant des protéines étrangères provenant de plusieurs espèces, une chimère entre une protéine humaine et une protéine de souris17
Les biothérapies utilisées dans le traitement des uvéites non infectieuses incluent l’interféron (IFN), les immunoglobulines intraveineuses (IgIV), ainsi que les anticorps monoclonaux et les protéines de fusion (anti-TNF α , anakinra, tocilizumab, rituximab). L’IFN permet d’induire une rémission prolongée, se maintenant après l’arrêt du traitement, chez 20 à 40 % des patients. Les effets secondaires (syndrome pseudo-grippal, effets psychiatriques) limitent son utilisation. Les anti-TNFα (infliximab, adalimumab) représentent une alternative thérapeutique attractive dans les uvéites sévères résistantes aux immunosuppresseurs, en particulier dans la maladie de Behçet.
Ils sont efficaces la plupart du temps (> 90 % des cas), et rapidement, mais leur action est souvent suspensive. Les anti-TNFα sont utilisés de façon prolongée ou dans l’attente de l’efficacité d’un autre immunosuppresseur, une fois l’inflammation oculaire contrôlée. Les IgIV sont utilisées dans la maladie de Birdshot. Leur tolérance est bonne, mais leur efficacité est transitoire. Le rituximab a montré son efficacité dans quelques observations d’inflammations oculaires variées (uvéites, sclérites et pseudo-tumeurs inflammatoires associées à la granulomatose avec polyangéite) ainsi que dans la pemphigoïde cicatricielle. Le risque d’infection limite son utilisation dans les maladies résistantes aux traitements conventionnels18
L’anakinra (anti-IL1β) a montré des résultats intéressants en termes d’efficacité dans une petite étude ouverte sur la maladie de Behçet. Sa sécurité d’utilisation est bonne et son court délai d’action peut être intéressant pour le traitement des uvéites sévères.
Le canakinumab est un anticorps monoclonal humain (IgG1) dirigé contre l’interleukine 1β19. Il a été utilisé avec succès dans les syndromes périodiques associés à la cryopyrine, l’arthrite juvénile idiopathique (AJI) à début systémique, la maladie de Behçet réfractaire et la fièvre méditerranéenne familiale résistante à la colchicine. Des données préliminaires suggèrent l’efficacité du canakinumab pour les maladies oculaires réfractaires chez les patients atteints du syndrome de Blau20, du syndrome de Behçet juvénile21 et du syndrome cutané et articulaire neurologique infantile chronique22
La présence d’une uvéite est associée à une réponse soutenue aux inhibiteurs de l’interleukine (IL)-1, l’anakinra et le canakinumab, dans la maladie de Behçet
Objectif : Identifier les facteurs associés à une réponse durable à l’inhibition de l’interleukine (IL)-1 parmi les données démographiques, cliniques et thérapeutiques chez les patients atteints de la maladie de Behçet (MB)23, 24
Méthodes : Des patients atteints de la maladie de Behçet et traités par anakinra ou canakinumab ont été recrutés. Ils ont été divisés en deux groupes en fonction de la réponse clinique : le groupe 1 comprenait les sujets ayant suivi le traitement pendant au moins 52 semaines et n’ayant pas présenté d’inefficacité secondaire au cours de la première année de suivi; les autres patients ont été inclus dans le groupe 2. Les données démographiques, cliniques et thérapeutiques ont été analysées afin d’identifier les différences significatives entre les groupes.
Résultats : Dix-huit patients ont été inclus dans le groupe 1 et 18 patients dans le groupe 2. Une meilleure réponse aux inhibiteurs de l’IL-1 était significativement plus fréquente chez les patients atteints d’uvéite liée à la MB (p = 0,006) et chez les patients dont la maladie durait depuis plus longtemps (p = 0,03).
Conclusion : Le blocage de l’IL-1 est efficace dans la maladie de Crohn, en particulier dans le sous-groupe de patients présentant une atteinte oculaire et chez ceux dont la maladie dure depuis longtemps.
Inhibition de l’interleukine (IL)-1 par l’anakinra et le canakinumab dans l’uvéite liée à la maladie de Behçet : étude observationnelle rétrospective multicentrique
Cette étude visait à évaluer le rôle des inhibiteurs de l’interleukine (IL)-1, de l’anakinra (ANA) et du canakinumab (CAN) dans le traitement de l’uvéite liée à la maladie de Behçet (MB). Une étude observationnelle rétrospective multicentrique a porté sur 19 patients consécutifs atteints de la maladie de Behçet (31 yeux atteints) ayant reçu un traitement par des agents anti-IL-125.
Les données ont été analysées au début de l’étude, puis après 3 et 12 mois. Le critère d’évaluation principal est la réduction des poussées inflammatoires oculaires (OIF). Les critères d’évaluation secondaires sont l’amélioration de la meilleure acuité visuelle corrigée (MAVC), la réduction de l’épaisseur maculaire définie par tomographie par cohérence optique (TCO) et de la vascularite évaluée par angiographie à la fluorescéine (AF), l’évaluation des différences statistiquement significatives entre les patients traités par des inhibiteurs de l’IL-1 en monothérapie, les sujets également traités par des antirhumatismaux modificateurs de la maladie (ARMM) et/ou des corticostéroïdes, ainsi qu’entre les patients traités par des inhibiteurs de l’IL-1 en tant que traitement biologique de première ligne et ceux précédemment traités par des inhibiteurs du TNF-α. À 12 mois, les OIF ont diminué de manière significative, passant de 200 épisodes/100 patients/an à 48,87 épisodes/100 patients/an (p < 0,0001).
La fréquence des vascularites rétiniennes évaluées par AF a significativement diminué entre le début de l’étude et les visites de suivi à 3 et 12 mois (p < 0,0001 et p = 0,001, respectivement). Le taux d’OIF était significativement plus élevé chez les patients traités en association avec des ARMM (81,8 épisodes/100 patients/an) que chez les patients traités par des inhibiteurs de l’IL-1 en monothérapie (0,0 épisode/100 patients/an) (p = 0,03). Aucune différence n’a été relevée en fonction de l’utilisation de corticostéroïdes et entre les patients traités par des inhibiteurs de l’IL-1 en première ou en deuxième intention. La dose de corticoïdes a été significativement réduite lors de la visite à 12 mois par rapport au début de l’étude (p = 0,02). Le traitement par inhibiteurs de l’IL-1 est efficace dans la prise en charge de l’uvéite liée à la MB et permet un contrôle à long terme de l’inflammation oculaire dans les cas réfractaires et durables. Autres options. D’autres bloqueurs du TNF tels que le golimumab (Simponi) et le certolizumab (Cimzia) ont été utilisés beaucoup moins fréquemment, a déclaré la Dre Sen : « Ils ne sont pas nécessairement moins efficaces. Nous ne disposons tout simplement pas de suffisamment de données à leur sujet. Les médecins peuvent envisager de faire passer leurs patients à l’un de ces médicaments s’ils ont des problèmes avec l’adalimumab ou l’infliximab13 »
L’adalimumab est un anticorps monoclonal totalement humanisé et présente donc moins d’effets indésirables que l’infliximab, qui est un anticorps monoclonal chimérique. Il est administré par voie sous cutanée à raison de 40 mg toutes les 2 semaines. Dans le cas de l’uvéite, seuls l’adalimumab et l’infliximab sont utilisés. L’étanercept semble moins efficace en raison d’une plus faible pénétration oculaire et n’est pas recommandé dans cette indication.
Le golimumab est injecté par voie sous-cutanée à la dose de 50 mg toutes les quatre semaines, et sa voie d’administration ainsi que son délai d’administration sont de grands avantages par rapport aux autres anti-TNF22
Traitement des uvéites par biothérapies : n’oublions pas le certolizumab pégol
Les biothérapies, notamment les anti-TNF alpha, ont pris une place très importante dans le traitement des uvéites sévères non infectieuses, essentiellement l’infliximab et l’adalimumab. L’utilisation du certolizumab pégol (CTZ) est plus confidentielle dans la littérature26, 27
Patients et méthodes : Nous rapportons ici une série de 11 patients traités avec le certolizumab pégol. Il s’agissait de 7 femmes et 4 hommes : 3 panuvéites (avec respectivement contexte de psoriasis, maladie de Behçet, Vogt Koyanagi Harada) et 8 uvéites antérieures aiguës récidivantes (une arthrite chronique juvénile, un Crohn et 6 spondylarthrites ankylosantes). La durée moyenne d’évolution de la maladie causale est de 6,2 ans (extrêmes 1–30). L’âge moyen au moment de la mise en route du CTZ est de 34,3 ans (extrêmes 23–70). Sept patients avaient reçu préalablement de la colchicine, 8 du méthotrexate, 1 de l’azathioprine, 1 du mycophénolate, 1 de l’interféron, 1 de l’adalimumab. Ces traitements se sont avérés insuffisamment efficaces ou inefficaces, ou mal tolérés (hépatite sous azathioprine, syndrome lupique sous adalimumab). Dans ce contexte, le CTZ a été introduit à la dose de 200 mg tous les 15 jours en SC avec une première injection de 200 mg × 2. La durée moyenne de traitement par CTZ est de 12 mois (extrêmes 6–48).
Résultats : Tous les patients sont à l’heure actuelle encore sous CTZ, sauf la plus âgée (70 ans) pour laquelle un doute sur une insuffisance cardiaque n’existant pas antérieurement a fait stopper le CTZ. Une seule patiente est encore à l’heure actuelle sous 5 mg de prednisone par jour. L’évolution ophtalmologique est favorable chez tous les patients, avec amélioration d’au moins deux points de l’acuité visuelle, absence de nouvelle poussée, absence d’atteinte intermédiaire et postérieure chez les patients concernés, stabilité de la maladie causale. Les résultats dans notre série, comme dans ceux de la littérature, sont donc encourageants.
Discussion : Le CTZ pégol est la « petite dernière » des biothérapies non bio similaires dirigées contre le TNF, ce qui explique pourquoi le nombre de patients avec uvéite sévère non infectieuse traités par cet anti-TNF est plus faible et le nombre de séries de la littérature moins importants qu’avec l’infliximab ou l’adalimumab. Une série espagnole publiée à l’American College of Rheumatology à Washington en 2016 en souligne l’intérêt potentiel puisque 22 patients réfractaires à d’autres anti-TNF se voient contrôlés par le CTZ. Dans cette série, seuls deux patients ne répondent pas au switch thérapeutique proposé et nécessitent un passage au tocilizumab.
Conclusion : Le CTZ pégol est une arme thérapeutique supplémentaire des uvéites sévères non infectieuses. Sa place dans le catalogue thérapeutique disponible reste à évaluer à une plus grande échelle.

BIRDSHOT. Ce patient de 42 ans présentait une choriorétinopathie en tache d’oiseau et un œdème maculaire cystoïde. Cette image a été publiée à l’origine dans la banque d’images de la rétine de l’ASRS. Pauline T. Merrill, MD, et John Pollack. BSC CME OS. Banque d’images de la rétine. 2012
En règle générale, beaucoup commencent par des stéroïdes, puis ajoutent un immunosuppresseur traditionnel tel qu’un antimétabolite, souvent le mycophénolate mofétil, ou un inhibiteur des lymphocytes T, comme le tacrolimus ou la cyclosporine A. Mais plutôt que de passer aux agents cytotoxiques comme étape suivante ou de combiner l’inhibiteur des lymphocytes T avec un antimétabolite, ils essaieront un produit biologique si c’est faisable du point de vue du patient.
Outre l’infliximab et l’adalimumab, voici quelques-uns des médicaments qui ont été testés ou qui sont en cours de développement pour les patients atteints d’uvéite :
Le rituximab : injecté dans l’œil pour les patients atteints de lymphome vitréo-rétinien, le rituximab est également administré par voie systémique pour traiter les patients atteints de maladie inflammatoire orbitaire et de sclérite, a déclaré la Dre Smith. Plus récemment, il a été utilisé chez des patients atteints d’uvéite, y compris chez des enfants souffrant d’uvéite associée à l’arthrite juvénile idiopathique (AJI). Le rituximab cible les cellules B, mais son mécanisme d’action spécifique dans l’uvéite est mal compris, a déclaré le Dr Lee.
Les bloqueurs d’interleukine : les inhibiteurs du récepteur de l’interleukine-6 (IL-6) sont une alternative raisonnable pour l’uvéite lorsque les autres médicaments échouent, a déclaré le Dr Lee, bien que les données de la littérature ne soient pas du plus haut niveau28. « L’IL-6 semble être efficace pour restaurer la barrière hémato-oculaire et se débarrasser de l’œdème maculaire, mais il est moins efficace pour éradiquer les autres caractéristiques de l’inflammation ». Bien que son utilisation soit principalement étayée par des rapports de cas et de petites séries de cas, le tocilizumab (Actemra) est un bloqueur de l’IL-6 qui semble prometteur, a déclaré la Dre Thorne, et il est actuellement évalué dans le cadre de l’essai clinique multicentrique STOP-UVEITIS.
Les inhibiteurs de l’interleukine 6 constituent une nouvelle frontière dans le traitement de l’uvéite non infectieuse. « Les anticorps contre l’IL-6, comme le tocilizumab, sont relativement nouveaux, poursuit la Dre Arepalli. J’ai obtenu de très bons résultats chez certains patients, en particulier ceux qui souffrent d’uvéite postérieure et d’œdème maculaire uvéitique. Nous disposons également d’études portant sur l’administration intravitréenne d’IL-6, telles que DOVETAIL, une étude de phase I, qui a donné des résultats positifs. »
Les résultats préliminaires de l’étude de phase I DOVETAIL ont montré que l’injection de RG6179 entraînait une amélioration de la vision et de l’épaisseur de la rétine dans toutes les cohortes de dosage, et qu’elle était bien tolérée28
En ce qui concerne les futures thérapies à surveiller, la Dre Arepalli estime que l’IL-6 est la plus prometteuse à l’heure actuelle. « DOVETAIL a montré une réduction significative de l’œdème maculaire uvéitique par administration intraoculaire, explique-t-elle. Traditionnellement, le traitement intravitréen de l’œdème maculaire uvéitique nécessite des stéroïdes, ce qui offre la possibilité d’un traitement local sans stéroïdes »29
Le gevokizumab, un inhibiteur de l’IL-1, semblait initialement encourageant, mais n’a pas atteint les critères d’évaluation primaires dans les grands essais cliniques, a déclaré la Dre Smith.
Le daclizumab (Zinbryta), qui cible le récepteur de l’IL-2 et a montré des résultats prometteurs dans de petits essais cliniques chez des patients atteints d’uvéite, a été retiré temporairement du marché en raison d’une faible demande, mais il est maintenant de nouveau disponible hors étiquette, a déclaré la Dre Sen.
Les ophtalmologistes ont acquis une connaissance anecdotique des produits biologiques et ont commencé à les tester après leur utilisation en rhumatologie, en gastro-entérologie et en dermatologie, a déclaré le Dr Dunn. Cependant, l’expérience directe de l’ophtalmologie avec les médicaments biologiques pour l’uvéite est limitée à environ 15 ans, a déclaré Justine R. Smith, FRANZCO, Ph. D, à l’Université Flinders d’Adélaïde, en Australie du Sud. « Si j’avais une uvéite et que ma maladie répondait bien au méthotrexate, est-ce que je voudrais prendre un médicament biologique ? Non, je voudrais prendre du méthotrexate, que nous avons depuis bien plus longtemps. Nous connaissons très bien son profil d’effets secondaires et il est beaucoup moins cher30 »
« Les produits biologiques offrent l’avantage d’une thérapie plus ciblée, a déclaré la Dre Thorne, mais l’uvéite englobe au moins 30 syndromes différents, et beaucoup de ces maladies sont indifférenciées, sans cause définissable connue ni mécanisme spécifique. »
Des progrès sont réalisés dans la compréhension des voies inflammatoires impliquées dans l’uvéite, a déclaré le Dr Dunn. « Mais nous avons encore tendance à penser qu’il s’agit d’un processus linéaire qui peut être complètement court-circuité par un seul médicament. Cependant, il arrive que nous bloquions une voie et que la nature trouve un moyen de la contourner en suivant une autre voie inflammatoire. Nous savons depuis longtemps qu’il en va de même pour d’autres maladies telles que l’asthme. »
Les corticostéroïdes sont depuis longtemps un pilier du traitement de l’uvéite non infectieuse. Cependant, lorsque les corticostéroïdes sont utilisés pendant de nombreuses années, il existe une réelle inquiétude quant au développement d’un déséquilibre dans l’équation bénéfice/risque, a déclaré Richard Lee, MRCOphth, Ph. D, au National Institute for Health Research Moorfields Biomedical Research Centre à Londres. « Avec une pléthore d’effets nocifs associés, dont le diabète sucré et l’hypertension artérielle, la prednisone est le croque-mitaine de la communauté médicale31 »
Les médecins doivent évaluer les effets secondaires d’une thérapie stéroïdienne orale à long terme par rapport aux risques biologiques, principalement l’infection, a ajouté le Dr Dunn. Malgré leur potentiel d’effets secondaires, les immunosuppresseurs ont un meilleur profil à long terme que la prednisone à des doses de 10 mg par jour.
On pourrait cependant affirmer que les effets secondaires des médicaments biologiques sont pires chez certains patients atteints d’uvéite que chez les patients souffrant de maladies systémiques, a déclaré la Dre Smith. « Cela peut s’expliquer par le fait que l’on bloque une trop grande quantité d’une substance qui est également nécessaire au fonctionnement normal du système immunitaire. En revanche, les patients atteints d’une maladie inflammatoire systémique peuvent conserver une quantité suffisante [de la substance ciblée] après le traitement parce qu’ils ont commencé avec des niveaux plus élevés », a-t-elle ajouté13

BEHÇET. Ce patient de 30 ans souffrait d’une rétinite maculaire et d’une vascularite (images du haut). Il a répondu favorablement aux perfusions d’infliximab et la rétinite et les fuites vasculaires ont disparu (images du bas).
Les cliniciens n’associent généralement pas deux médicaments biologiques, en raison d’un risque d’infection plus élevé. « Avec ce type d’association, un essai a révélé une augmentation significative des infections sans augmentation significative de l’efficacité », a déclaré la Dre Sen. Mais l’association de médicaments biologiques avec des médicaments non biologiques est courante, a-t-elle ajouté. Ainsi, un patient peut prendre un bloqueur du TNF et un antimétabolite (par exemple, le méthotrexate ou le mycophénolate mofétil) ou un inhibiteur des lymphocytes T (comme la cyclosporine ou le tacrolimus). Dans de rares cas, des médicaments tels que le rituximab (Rituxin) et des agents alkylants tels que le cyclophosphamide ont également été associés. Les inhibiteurs du TNF ne sont généralement pas associés à d’autres médicaments biologiques32
Quel est l’avantage d’associer des médicaments biologiques au mycophénolate mofétil, par exemple ? Y a-t-il un effet additif, les deux médicaments contrôlant la réponse immunitaire anormale ? Ou bien le mycophénolate mofétil empêche-t-il la production d’anticorps par le système immunitaire de l’hôte, ce qui neutralise le médicament ? Il est probable que ce soit les deux, a déclaré le Dr Lee.

ATTENTION. Les inhibiteurs du TNF peuvent réactiver une infection chez les patients atteints de certaines maladies, notamment la tuberculose et l’hépatite. Par conséquent, les patients comme celui-ci (dont l’uvéite granulomateuse était liée à la tuberculose) doivent d’abord être traités pour la maladie sous-jacente, et il ne doit y avoir aucun signe d’infection active. Université de l’Iowa.
1. https://www.merckmanuals.com/fr-ca/professional/ troubles-oculaires/uv%C3%A9ite-et-troublesassoci%C3%A9s/revue-g%C3%A9n%C3%A9raledes-uv%C3%A9ites
2. https://www.opdivo.com/
3. https://en.wikipedia.org/wiki/Ipilimumab
4. https://www.ncbi.nlm.nih.gov/pmc/articles/PMC4455042/
5. Gritz DC, Wong IG. Incidence and prevalence of uveitis in Northern California; the Northern California Epidemiology of Uveitis Study. Ophthalmology. (2004) 111:491–500; discussion 500. 10,1016/j.ophtha.2003.06.014
6. Thorne JE, Suhler E, Skup M, Tari S, Macaulay D, Chao J, et al.. Prevalence of noninfectious uveitis in the united states: a claims-based analysis. JAMA Ophthalmol. (2016) 134:1237–45. 10.1001/jamaophthalmol.2016.3229
7. Bodaghi B, Cassoux N, Wechsler B, Hannouche D, Fardeau C, Papo T, et al. Chronic severe uveitis: etiology and visual outcome in 927 patients from a single center. Medicine. (2001) 80:263–70. 10.1097/00005792-200107000-00005
8. Acharya NR, Tham VM, Esterberg E, Borkar DS, Parker J V, Vinoya AC, et al. Incidence and prevalence of uveitis: results from the Pacific Ocular Inflammation Study. JAMA Ophthalmol. (2013) 131:1405–12. 10.1001/jamaophthalmol. 2013.4237 [PubMed] [CrossRef] [Google Scholar]
9. Suhler EB, Lloyd MJ, Choi D, Rosenbaum JT, Austin DF. Incidence and prevalence of uveitis in Veterans Affairs Medical Centers of the Pacific Northwest. Am J Ophthalmol. (2008) 146:890–6.e8. 10.1016/j. ajo.2008.09.014
10. Jaffe GJ, Dick AD, Brézin AP, et al. Adalimumab in patients with active noninfectious uveitis. N Engl J Med 8;375(10):932-43, 2016. doi: 10.1056/NEJMoa1509852
11. Lee J, Koreishi AF, Zumpf KB, et al. Success of weekly adalimumab in refractory ocular inflammatory disease. Ophthalmology S0161-6420(20)30333-X, 2020. doi: 10.1016/j.ophtha.2020.04.009
12. Kruh JN, Yang P, Suelves AM, et al. Infliximab for the treatment of refractory noninfectious uveitis: A study of 88 patients with long-term follow-up. Ophthalmology 121(1):358-364, 2014. doi: 10.1016/j.ophtha.2013.07.019
13. https://www.reviewofophthalmology.com/article/thetoolbox-for-noninfectious-uveitis
14. https://www.medecinesciences.org/articles/medsci/ full_html/2020/08/msc200148/F3.html
15. https://www.sfo-online.fr/revue-presse/efficacite-ettolerance-long-terme-des-anti-tnf-alpha
16. https://www.sciencedirect.com/science/article/pii/ S0248866318300833
17. https://www.researchgate.net/publication/284359987_ Infliximab_versus_adalimumab_dans_les_uveites_ severes_etude_multicentrique_francaise
18. https://www.sciencedirect.com/science/article/pii/ S024886631400589X ?via%3Dihub
19. https://www.jrheum.org/content/43/7/1445 :
20. Simonini G, Xu Z, Caputo R, De Libero C, Pagnini I, Pascual V, et al. Clinical and transcriptional response to the long-acting interleukin-1 blocker canakinumab in Blau syndrome-related uveitis. Arthritis Rheum 2013;65:513–8.
21. Ugurlu S, Ucar D, Seyahi E, Hatemi G, Yurdakul S. Canakinumab in a patient with juvenile Behçet’s syndrome with refractory eye disease. Ann Rheum Dis 2012;71:1589–91.
22. Hirano M, Seguchi J, Yamamura M, Narita A, Okanobu H, Nishikomori R, et al. Successful resolution of stromal keratitis and uveitis using canakinumab in a patient with chronic infantile neurologic, cutaneous, and articular syndrome: a case study. J Ophthalmic Inflamm Infect 2015;5:34.
23. https://pubmed.ncbi.nlm.nih.gov/30148652/
24. Fabiani C, Vitale A, Rigante D, Emmi G, Lopalco G, Di Scala G, Sota J, Orlando I, Franceschini R, Frediani B, Galeazzi M, Iannone F, Tosi GM, Cantarini L. The Presence of Uveitis is Associated with a Sustained Response to the Interleukin (IL)-1 Inhibitors Anakinra and Canakinumab in Behçet's Disease. Ocul Immunol Inflamm. 2020;28(2): 298-304. doi: 10.1080/09273948.2018.1511810. Epub 2018 Aug 27. PMID: 30148652.
25. Fabiani C, Vitale A, Emmi G, Lopalco G, Vannozzi L, Guerriero S, Gentileschi S, Bacherini D, Franceschini R, Frediani B, Galeazzi M, Iannone F, Tosi GM, Cantarini L. Interleukin (IL)-1 inhibition with anakinra and canakinumab in Behçet's disease-related uveitis: a multicenter retrospective observational study. Clin Rheumatol. 2017 Jan;36 (1) :191-197. doi: 10.1007/s10067-016-3506-4. Epub 2016
26. Miserocchi E, Modorati G, Pontikaki I, Meroni P, Gerloni V. Golimumab treatment for complicated uveitis. 2013;31:320–1.
27. https://www.sciencedirect.com/journal/la-revue-demedecine-interne/vol/38/suppl/S1
28. Sharma S, Suhler E, Lin P, Pauly-Evers M, Willen D, Peck R, Storti F, Rauhut S, Gott T, Passemard B, Macgregor L, Haskova Z, Silverman D, Fauser S, Mesquida M. A novel intravitreal anti-IL-6 monoclonal antibody for uveitic macular edema (UME): Preliminary results from the phase 1 DOVETAIL study. Invest Ophthalmol Vis Sci 2023;64:8:5100.
29. https://iovs.arvojournals.org/article. aspx ?articleid=2789443
30. https://onlinelibrary.wiley.com/doi/abs/10.1111/ceo.13856
31. https://www.aao.org/Assets/e7a0ea7d-31c4-4f07-9eff685a60d64fce/636338245965130000/july-2017feature-pdf
32. https://eyewiki.aao.org/Treatment_of_Uveitis

mini facilite le démarrage du traitement de la sécheresse oculaire et des allergies chez vos patients, et HYLO-DUAL® pour un traitement à plus long terme.
• Ectoïne: soulagement immédiat des symptômes causés par les allergies et l'inflammation 1,2
• Hyaluronate de sodium: de haute qualité (poids moléculaire élevé) pour un soulagement durable de la sécheresse oculaire 3
• Flacon sans entrée d’air, de conception allemande, distribuant une goutte à la fois






Introduction
La blépharoptose (ou ptose) est une affection oculaire courante, souvent liée à l’âge, qui se caractérise par la chute d’une ou des deux paupières supérieures en dessous de leur position anatomique normale. Le ptosis a des effets néfastes sur la fonction visuelle et la qualité de vie et peut être indésirable sur le plan esthétique.
Épidémiologie et impact du ptosis
La blépharoptose (du grec bleph [paupière] et ptosis [chute]) est un état clinique caractérisé par la chute du bord de la paupière supérieure lorsque l’œil est dans le premier regard (droit devant). La paupière saine tombe sur la face supérieure du globe de telle sorte que la distance entre le réflexe pupillaire central et le bord central de la paupière est de 4 à 5 mm; ce paramètre est appelé distance réflexe marginale (DRM) 1. Il y a ptosis lorsque la distance réflexe marginale 1 est inférieure à la normale. Le ptosis peut être unilatéral ou bilatéral; la latéralité peut donner des indications sur l’étiologie1
Selon les études ophtalmologiques réalisées sur des patients atteints de ptose, les taux d’occurrence sont les suivants. L’âge moyen des femmes atteintes de ptose aponévrotique est de 67,83 ans et celui des hommes de 68,19 ans. L’âge moyen de la ptose congénitale est de 12,27 ans pour les femmes et de 8,57 ans pour les hommes. L’âge moyen du ptosis mécanique est de 49,41 ans chez les femmes et de 43,30 ans chez les hommes. L’âge moyen du ptosis myogène est de 53,45 ans pour les femmes et de 43,30 ans pour les hommes. L’âge moyen du ptosis neurogène est de 43,6 ans chez la femme et de 32,62 ans chez l’homme. Enfin, l’âge moyen du ptosis traumatique est de 35,12 ans chez les femmes et de 33,4 ans chez les hommes2. Il n’a pas été constaté que le ptosis était lié au sexe ou à la race3
Le ptosis survient généralement lorsque le muscle releveur se détache de son insertion dans la paupière et peut se manifester de manière unilatérale ou bilatérale, congénitale ou acquise4. Sa prévalence varie de 4,7 % à 13,5 % chez l’adulte et son incidence augmente avec l’âge5. Bien que la ptose acquise soit fréquemment observée en milieu clinique, il est essentiel de procéder à un diagnostic différentiel lors de l’évaluation du patient afin d’exclure les maladies neurologiques ou orbitales graves. Si elle n’est pas traitée, la ptose peut entraîner une anxiété liée à l’apparence, une dépression et des déficits du champ visuel supérieur6-8

Paupière supérieure (DRM1) : il s’agit de la distance en millimètres entre le réflexe lumineux cornéen et le bord de la paupière supérieure. DRM2 : distance entre le réflexe lumineux de la cornée et le bord de la paupière inférieure. Le ptosis est défini par une valeur DRM1 faible. DRM, distance entre le bord et le réflexe. (Avec l’aimable autorisation de Harsha S. Reddy, MD.)

La fonction du releveur (excursion du releveur) est mesurée en alignant une règle sur le bord de la paupière lorsque le patient regarde vers le bas. On demande ensuite au patient de regarder vers le haut (pendant que l’examinateur regarde vers le haut), et la position maximale de la paupière supérieure est marquée sur la même règle – dans ce cas, 12,5 mm. (Avec l’aimable autorisation de Harsha S. Reddy, MD.)
Le ptosis est fréquent dans la population adulte générale. Dans les études épidémiologiques, la prévalence du ptosis varie de 4,7 % à 13,5 %1. Il existe un lien étroit entre le ptosis et l’âge9. Bien que le ptosis affecte environ 5 % des adultes âgés de 49 ans et moins, la prévalence est d’environ 12 % chez les adultes âgés de ≥ 50 ans et de plus de 20 % chez les adultes âgés de plus de 70 ans10-12
Les mesures quantitatives de la position des paupières permettent d’évaluer la fonction des muscles rétracteurs, d’identifier les anomalies anatomiques et peuvent également être utiles pour surveiller la progression ou l’amélioration du ptosis au fil du temps.
Ces mesures, appelées distance marginale réflexe (DRM) 1, 2 et 3, sont effectuées à l’aide d’une lampe-stylo dirigée vers les yeux du patient lorsqu’il est dans le regard principal. Pour la DRM1, la distance en millimètres entre la partie centrale du bord de la paupière supérieure et le réflexe pupillaire est enregistrée pour les deux yeux14-16. Une DRM1 normale est de 4 mm à 5 mm. La différence de DRM1 entre l’œil normal et l’œil ptosé correspond à l’importance de la ptose. Si la ptose est suffisamment importante pour que le réflexe pupillaire ne puisse pas être visualisé, la distance en millimètres à laquelle la paupière doit être soulevée jusqu’à ce que le réflexe pupillaire puisse être vu est enregistrée en tant que DRM1 en nombre négatif14
La DRM2 diffère en ce qu’elle mesure le regard primaire, du réflexe cornéen à la lumière à la partie centrale de la paupière inférieure12. La DRM3 détermine la quantité de releveur à réséquer chez les patients atteints de ptosis congénital, qui présentent un strabisme vertical associé à un ptosis et chez qui la chirurgie du strabisme n’est pas indiquée17
La fonction du releveur peut être mesurée en déterminant le mouvement total en millimètres de la paupière supérieure entre le regard vers le bas et le regard vers le haut. Cette mesure est importante pour le chirurgien lorsqu’il détermine la procédure de correction la plus appropriée. La fonction normale du releveur est généralement supérieure à 15 mm, tandis que 12 à 14 mm sont considérés comme bons, 5 à 11 mm comme moyens et moins de 4 mm comme médiocres.
Le pli de la paupière supérieure représente la jonction entre l’aponévrose du releveur et le muscle orbiculaire sus-jacent. La zone allant du bord de la paupière supérieure en position couchée au pli de la paupière mesure normalement environ 8 mm chez les hommes et 9 à 10 mm chez les femmes, bien qu’elle puisse varier en fonction de la race10. Chez les patients atteints de ptosis congénital ou myogène, le pli de la paupière supérieure est souvent absent ou subtil. Chez les patients atteints de ptosis aponévrotique, le pli de la paupière supérieure est positionné beaucoup plus haut11
La fissure palpébrale (FP) est simplement la distance la plus large entre les bords des paupières supérieure et inférieure dans le regard primaire et permet une comparaison globale de la ptose relative. Les valeurs moyennes se situent entre 8 et 11 mm10
Une FP normale est de 8 à 11 cm; une valeur inférieure peut indiquer une désinsertion de l’aponévrose du releveur de la plaque tarsienne. La hauteur du pli de la paupière supérieure est la distance entre le bord de la paupière et le pli de la paupière supérieure. Elle est généralement de 7 à 8 mm chez les hommes et de 9 à 10 mm chez les femmes. Ce paramètre est augmenté en cas de ptosis aponévrotique et absent en cas de ptosis congénital. La meilleure façon de mesurer le DRM1 et la FP est d’utiliser la règle qui se trouve sur le bord de la plupart des cartes de vision de près12
Examen de l’anatomie des paupières
La paupière est un élément essentiel de l’annexe oculaire, car elle protège la cornée, élimine les débris de la surface oculaire et produit et distribue le film lacrymal qui maintient et protège la cornée sur le plan immunologique. Une anatomie complexe sous-tend ces fonctions10-12. La paupière est tapissée par la peau à l’extérieur et par la conjonctive le long de la surface bulbaire, qui se rejoignent à la jonction cutanéo-muqueuse le long du bord de la paupière. Le bord de la paupière comporte également les cils et les glandes sébacées de Zeiss et de Moll qui leur sont associées, ainsi que les orifices des glandes de Meibomius. La substance de la paupière supérieure est composée de la plaque tarsale contenant les glandes de Meibomius et de trois muscles : l’orbicularis oculi, le levator palpebrae superioris et le muscle de Müller (également appelé muscle tarsal supérieur).
Étiologies du ptosis
Le ptosis peut être classé en trois catégories selon l’étiologie : congénitale, acquise et pseudoptose14
Types de ptoses13-15
Congénital Acquis
• Congénital Ptosis
• Congénital troisième nerf crânien
• Syndrome de Horner
• Syndrome de Marcus-Gunn de la mâchoire
• Aponévrotique
• Mécanique
• Myogène
• Neurogène
• Traumatique
Pseudoptose
• Ptose des sourcils
• Énophtalmie
• Contralatérale rétraction de la paupière (maladie oculaire de la thyroïde)
• Contralatéral Proptose
• Dermatochalasis
• Hypertropie
• Hyperglobus
Le ptosis congénital est peu fréquent, avec une prévalence de 8 pour 100 00016. La forme la plus courante de ptosis congénital (75 %)14 est due à une dysgénésie du muscle releveur, dans laquelle les fibres musculaires sont remplacées par de la graisse et du tissu fibreux et où le pli de la paupière est absent16. Le syndrome du clignement de la mâchoire de Marcus-Gunn18 survient lorsque l’innervation motrice du muscle ptérygoïdien latéral est mal dirigée vers le releveur, ce qui entraîne une rétraction de la paupière lors de la mastication. Le syndrome de Horner, qui résulte de l’interruption de l’innervation sympathique, se caractérise par la trinité ptosis, myosis et anhidrose et, dans les cas congénitaux, par une hétérochromie de l’iris ipsilatéral19. Les autres causes de ptosis congénital comprennent la paralysie congénitale du troisième nerf crânien, les traumatismes à la naissance et divers néoplasmes et syndromes16

Le ptosis mécanique survient en cas de lésions massives de la paupière qui la rendent trop lourde pour que les muscles puissent l’élever. Les causes les plus fréquentes sont les tumeurs, les lésions inflammatoires telles que les granulomes ou le chalazion, et les affections cicatricielles13, 14, 19. Le ptosis neurogène est lié à une innervation défectueuse des muscles rétracteurs. Les causes courantes sont le syndrome de Horner20, la paralysie du troisième nerf crânien, la myasthénie grave, le syndrome de Guillain-Barré, la sclérose en plaques et les céphalées en grappe13, 14, 19. Un cas particulier de ptosis neurogène se présente comme une complication post-injection de neurotoxine botulique de type A administrée dans la paupière à des fins thérapeutiques ou cosmétiques. La migration de la toxine dans le releveur, qui provoque un ptosis, est peu fréquente et temporaire20-23
Le ptosis acquis, ou involutionnel, est classé selon le ou les mécanismes sous-jacents à l’affection. La déhiscence ou l’involution de l’aponévrose du releveur est la forme la plus courante de ptosis acquis et résulte d’un étirement du releveur lié à l’âge en raison d’un amincissement ou d’une diminution du tonus musculaire14, 15, 21, 22. L'étiologie de cette affection est incomplètement caractérisée et elle est associée à des traumatismes tels que des antécédents de frottement des yeux et d'utilisation de spéculums au cours d'une chirurgie oculaire, ou à des injections intravitréennes répétées pour des maladies du segment postérieur.14,15 Le ptosis involutif peut être observé à un âge plus précoce chez les porteurs de lentilles de contact, probablement en raison de traumatismes répétitifs dus au frottement de la paupière sur la lentille21. Le ptosis myogène est causé par un dysfonctionnement du muscle releveur14, 15. Ce résultat est souvent observé dans des pathologies telles que la myasthénie grave, l’ophtalmoplégie externe progressive chronique, la dystrophie musculaire oculopharyngée et la dystrophie myotonique14, 15, 21
Le ptosis traumatique résulte d’une lésion directe ou indirecte du complexe de la paupière. Les muscles rétracteurs, leurs tendons ou leurs nerfs peuvent être endommagés par une déhiscence consécutive à un traumatisme ou par un œdème résultant d’un traumatisme15, 23-25. Selon la nature et l’étendue de la lésion, le ptosis traumatique peut être temporaire ou permanent.
Résumé des types courants de ptosis acquis, des causes et des facteurs de risque de ptosis
Types de ptosis acquis
Aponévrotique (involutionnel)
Causée par l’étirement, la déhiscence ou le détachement de l’aponévrose des releveurs, elle est typiquement associée au vieillissement.26, 27, 28
Se présente généralement avec une réduction de la DRM1, un pli de la paupière supérieure élevé, une fonction des releveurs proche de la normale et une diminution de la DFP28
Myogène
Causée par une myopathie primaire ou secondaire du muscle releveur (par exemple, due à une OPMD, une dystrophie myotonique ou une CPEO)26, 27, 29
Peut se manifester par un pli de la paupière supérieure faible ou absent, une mauvaise fonction des muscles releveurs et un décalage de la paupière lors du mouvement de descente28
Neurogène
Type de ptosis relativement rare, causé par une anomalie du SNC ou une affection neurologique sous jacente affectant les nerfs oculomoteurs ou sympathiques26, 27, 29
Peut se présenter de différentes manières, en fonction de la cause sous-jacente (par exemple, le syndrome de Horner se présente comme un ptosis unilatéral avec une constriction pupillaire ipsilatérale et une anhidrose faciale)26, 27, 28
Mécanique
Causé par un excès de poids sur la paupière supérieure, généralement dû à un néoplasme bénin ou malin (par exemple, hémangiome, chalazion, neurofibrome, kyste dermoïde)26, 29
Il peut également s’agir d’une « pseudoptose » (par exemple, dermatochalasis, dans lequel la fonction du releveur n’est pas altérée)26, 27, 29
Traumatique
Causé par un traumatisme des muscles rétracteurs de la paupière, de l’aponévrose ou des entrées neurales de la paupière29
Peut être de nature myogène, aponévrotique ou neurogène29
Facteurs de risque environnementaux communs pour le ptosis acquis.
L’âge
Dans les populations adultes, la prévalence du ptosis augmente avec l’âge30-32
La ptose aponévrotique liée à l’âge est la forme la plus courante de ptose chez les patients adultes plus âgés qui sont orientés vers la chirurgie de la ptose28, 33
Port de lentilles de contact
Le port à long terme de lentilles de contact dures ou souples est associé à un risque accru de ptosis33-36
Chirurgie oculaire
Ptosis transitoire ou persistant associé à une série d’interventions, y compris la chirurgie du glaucome, de la cornée, du strabisme et de la cataracte37, 38, 39, 40
Le risque peut dépendre de la technique chirurgicale utilisée38, 39, 40
Injection périoculaire de neurotoxine
Injections de toxine botulique associées à une ptose transitoire de la paupière supérieure41-43
CNS système nerveux central, CPEO ophtalmoplégie externe progressive chronique, DRM-1 Marginal Reflex Distance 1, OPMD dystrophie musculaire oculopharyngée, DFP distance de la fissure palpébrale.
Diagnostiquer la ptose :
Évaluation clinique
Le diagnostic et la prise en charge du ptosis se font en deux étapes : reconnaître sa présence et déterminer sa cause. Le ptosis peut être facilement ignoré. Une fois identifié, il est essentiel de procéder à une anamnèse et à un examen clinique approfondis et d’examiner attentivement les affections sous-jacentes ou masquées qui peuvent nécessiter une prise en charge médicale immédiate. Une anamnèse complète peut révéler des indices sur l’étiologie du ptosis36. L’apparition et la durée du ptosis permettent de distinguer les causes aiguës des causes chroniques. L’examen de photographies anciennes (le permis de conduire actuel du patient est généralement le plus facile à obtenir) révèle souvent une ptose subtile antérieure à la prise de conscience de l’affection par le patient. La latéralité peut également limiter le diagnostic différentiel. S’il est unilatéral, une évaluation minutieuse de l’autre œil peut servir de contrôle normal pour évaluer la magnitude et peut révéler un ptosis léger, ce qui indique une cause bilatérale.

L’acteur hollywoodien Forest Whitaker présente une ptose à l’œil gauche.
https://en.wikipedia.org/wiki/Ptosis_(eyelid)
La variabilité du degré de chute des paupières au cours de la journée peut indiquer une affection sous jacente telle que la myasthénie grave. Des antécédents de traumatisme, de chirurgie oculaire ou d’injection de neurotoxine botulique de type A peuvent également être liés à l’apparition d’un ptosis. Des antécédents familiaux de ptosis ou d’autres faiblesses musculaires peuvent indiquer une association systémique héréditaire. Un ptosis survenant isolément avec des mouvements de la mâchoire ou des yeux peut indiquer un trouble secondaire tel que le syndrome de Marcus-Gunn. La présence d’une diplopie peut être le signe d’une paralysie du troisième nerf crânien. Des difficultés de déglutition ou d’élocution peuvent indiquer un trouble musculaire. Plusieurs éléments de l’examen oculaire guident le diagnostic, dont l’examen de la paupière supérieure est le plus important. L’évaluation standard du ptosis comprend trois paramètres liés à la position des paupières44, 45
La fonction de chaque rétracteur de la paupière supérieure peut être évaluée de manière isolée afin d’identifier plus précisément la source du ptosis. La fonction du releveur est quantifiée en mesurant le mouvement de la paupière supérieure du regard vers le bas au regard vers le haut tout en stabilisant manuellement le front pour empêcher la contribution du muscle frontalis44. La fonction du releveur est considérée comme médiocre si l’élévation est comprise entre 0 et 4 mm, moyenne entre 5 et 11 mm, bonne entre 12 et 14 mm et normale si elle est supérieure à 15 mm. La fonction du muscle de Miller est évaluée en instillant de la phényléphrine à 2,5 % pour stimuler le système sympathique : l’amélioration de la hauteur de la paupière supérieure est proportionnelle à la fonction intacte du muscle de Müller.
La paupière elle-même doit être examinée à la recherche d’indices sur l’étiologie du ptosis. Les lésions de masse telles que le chalazion peuvent contribuer à la ptose mécanique. Un corps étranger sur la surface conjonctivale du tarse peut produire une chute protectrice de la paupière qui disparaît avec le retrait du corps étranger.
L’examen pupillaire doit comprendre l’évaluation de la forme et de la taille de la pupille à la fois en lumière faible et en lumière vive, ainsi que la symétrie de la réactivité à la lumière. L’anisocorie dans le cadre d’un ptosis peut indiquer un syndrome de Horner, une paralysie du troisième nerf crânien, un traumatisme, une iritis, une pupille tonique ou peut être une variante physiologique de la normale13, 29. Si la pupille de l’œil ptosé est la plus grande, il faut envisager une paralysie du troisième nerf crânien; si, au contraire, elle est la plus petite, il faut envisager un syndrome de Horner46
La fonction des muscles extraoculaires doit être évaluée par un examen sensorimoteur portant sur toutes les directions du regard. La présence de défauts de motilité suggère une cause neurologique ou myopathique. Un ptosis accompagné d’une motilité anormale et de pupilles symétriques suggère une paralysie du troisième nerf crânien, une myasthénie grave, une ophtalmoplégie externe progressive chronique, une dystrophie musculaire ou une maladie oculaire thyroïdienne. Si les pupilles sont asymétriques, une paralysie du troisième nerf crânien doit être envisagée.
L’évaluation du champ visuel est utile pour quantifier et documenter l’impact du ptosis sur la fonction visuelle. Les champs visuels doivent être évalués à la fois avec et sans tapotement de la paupière supérieure. La périmétrie standard automatisée avec une stratégie de test 24-2 est la plus courante dans la pratique clinique. La tonométrie de Goldmann est moins courante et nécessite un périmétriste compétent pour cartographier les défauts. Le test du champ périphérique de Leicester (LPFT) a été conçu pour cartographier la perte de champ liée au ptosis et au dermatochalasis et évalue les 48° supérieurs du champ visuel47
Traitement du ptosis
Approches traditionnelles
Le ptosis résulte d’une altération anormale de l’anatomie normale. Dans la plupart des cas, le traitement définitif consiste en une correction chirurgicale.
Dans les cas légers ou temporaires et dans les cas où la chirurgie n’est pas souhaitée ou est contre-indiquée, des options non chirurgicales peuvent améliorer les symptômes sans s’attaquer au défaut anatomique sous-jacent. Il s’agit notamment de diverses stratégies mécaniques pour soutenir la paupière et de plusieurs médicaments développés pour d’autres indications et utilisés hors AMM pour leurs effets secondaires bénéfiques sur la position de la paupière supérieure.
Interventions mécaniques
Plusieurs techniques ont été mises au point pour soulever mécaniquement la paupière supérieure afin de traiter la ptose48. La plus simple d’entre elles consiste à fixer les paupières supérieures au sourcil à l’aide d’un ruban adhésif. Pour les patients qui portent des lunettes pour corriger leur vue, des béquilles de paupière peuvent être fixées aux montures pour soutenir la paupière. Il existe également des lentilles de contact haptiques, bombées au sommet, qui soutiennent physiquement la paupière supérieure. Ces approches mécaniques sont généralement utilisées dans les cas de ptosis myogène ou neurogène. Elles ne doivent être envisagées que dans les cas où l’on s’attend à ce qu’elles soient temporaires.
Ces techniques présentent l’inconvénient d’être peu esthétiques, dans le cas des paupières collées, elles peuvent être pires que la ptose sous-jacente et de provoquer à la fois un inconfort et un assèchement de la surface oculaire.
La chirurgie est considérée comme le pilier du traitement de la ptose et donne des résultats toujours satisfaisants. Les complications postopératoires sont généralement légères et comprennent des ecchymoses, des gonflements, des saignements et des infections, et une surcorrection ou une sous-correction est possible. Plusieurs procédures sont disponibles. Le choix de l’intervention est déterminé par l’état de la fonction du releveur et la réponse au test sympathomimétique du muscle de Müller.
Chez les patients dont la fonction des releveurs est intacte, les procédures courantes comprennent l’avancement des releveurs ou la Müllerectomie conjonctivale. Lorsque la fonction des releveurs est moyenne, une résection de ceux-ci est indiquée. Lorsque la fonction des releveurs est faible, une suspension du frontalis doit être envisagée. Chez les patients dont la fonction du releveur est intacte, les procédures courantes comprennent l’avancement du releveur ou la Müllerectomie conjonctivale.
Interventions pharmacologiques
Plusieurs médicaments topiques approuvés pour d’autres indications peuvent être utilisés pour le diagnostic et la prise en charge du ptosis. Tous ces médicaments sont des agonistes alpha-adrénergiques48
La phényléphrine est utilisée pour évaluer la fonction du muscle de Müller par stimulation sympathique, ce qui a été décrit précédemment. L’utilisation de la phényléphrine pour le traitement du ptosis est limitée par les effets indésirables de la dilatation chronique de la pupille, notamment la sensibilité à la lumière et la perte d’acuité visuelle49
La naphazoline est un agoniste alpha-adrénergique non mydriatique disponible sans ordonnance comme vasoconstricteur et décongestionnant pour les yeux rouges32. Dans une étude non randomisée menée chez des adultes sains sans ptosis, la naphazoline, 0,05 %, a produit une augmentation moyenne faible mais significative de la DMR1 30 minutes (0,56 + 0,11 mm; P < 0,001) et 60 minutes (0,47 + 0,12 mm; P = 0,001), mais pas 120 minutes (0,26 + 0,09 mm; P = 0,028) après l’instillation49
L’apraclonidine, approuvée pour le traitement à court terme du glaucome à une concentration de 0,5 %50 et pour la prévention des pics de pression intraoculaire (PIO) à la suite d’interventions au laser sur le segment antérieur à une concentration de 1 %51, a été utilisée pour l’évaluation de la fonction du muscle de Müller chez les patients atteints de ptosis35 et également comme traitement chez les patients atteints de ptosis lié à la neurotoxine botulique de type28, 53 Son utilisation est limitée par des effets indésirables, notamment l’hyperémie, les démangeaisons, le larmoiement, la gêne, l’œdème des paupières, la sécheresse buccale, la sensation de corps étranger, la perte transitoire de la vision, la conjonctivite allergique et la dermatite de contact53. Très proche de l’apraclonidine, la brimonidine est également approuvée pour le glaucome à des concentrations de 0,2 %, 0,15 % et 0,1 %54, 55. Les études de phase 4 n’ont pas réussi à démontrer une amélioration cliniquement significative de la DRM1 avec la concentration de 0,2 %49 ou de la hauteur de la FP avec la concentration de 0,025 % (W. W. Lee, MD, données non publiées, 2021).
La neurotoxine botulique de type A peut être utilisée pour affaiblir sélectivement le muscle orbicularis oculi56. En outre, des produits de comblement à base d’acide hyaluronique peuvent être injectés dans la paupière supérieure controlatérale; un effet de Hering inversé peut entraîner une élévation de la paupière ptosée56, 57
Oxymétazoline : Nouvelle thérapie médicale approuvée pour la correction du ptosis.
En 2020, la Food and Drug Administration des États-Unis a approuvé la solution ophtalmique de chlorhydrate d’oxymétazoline, 0,1 %, pour le traitement de la blépharoptose acquise chez les adultes58.
L’oxymétazoline est un agoniste des récepteurs adrénergiques à action directe qui, à raison d’une goutte par jour, soulève la paupière supérieure en stimulant le muscle de Müller58.
Depuis 1964, l’oxymétazoline est disponible sur ordonnance et en vente libre pour la vasoconstriction de la surface oculaire, la décongestion nasale et l’érythème facial associé à la rosacée59, 60
Trois essais de phase 3, tous randomisés, à double masque et contrôlés par placebo, ont été menés44-46. Deux de ces études ont évalué l’efficacité et l’autre s’est concentrée sur la sécurité et la tolérabilité. Des analyses groupées des deux études d’efficacité ont été rapportées61, 62
Les deux études d’efficacité ont été conçues de manière identique61, 62. Les patients (n = 304 dans les deux études) présentant un ptosis acquis (DRM1 s 2 mm) et un défaut du champ visuel supérieur au LPFT dans au moins un œil ont été répartis au hasard dans un rapport 2:1 pour recevoir soit de l’oxymétazoline, 0,1 %, soit un véhicule une fois par jour dans les deux yeux pendant 6 semaines. Le principal critère d’évaluation était de nature fonctionnelle : changement moyen par rapport à la ligne de base du nombre de points observés dans les 4 rangées supérieures du LPFT (sur un total possible de 35 points) aux jours 1 et 14. Le principal résultat secondaire était de nature anatomique : valeurs moyennes de DRM1 aux jours 1, 14 et 42. La figure 8 présente les résultats fonctionnels primaires. Une augmentation statistiquement significative (P < 0,001) du nombre de points supérieurs observés sur le LPFT a été démontrée à la fois au jour 1 (6 heures après l’instillation) et au jour 14 (2 heures après l’instillation)62. La figure 9 présente les résultats anatomiques secondaires. Une amélioration statistiquement plus importante (P < 0,0S) de la DRM1 a été observée dans le groupe oxymétazoline par rapport au groupe véhicule 15 minutes, 2 heures et 6 heures après l’instillation aux jours 1, 14 et 4261
La sécurité a été le résultat principal d’un troisième essai de phase 3 et a également été évaluée dans les deux essais d’efficacité et dans une étude de phase 2 de validation du concept; les résultats de ces quatre essais ont été regroupés pour caractériser de manière robuste la sécurité de l’oxymétazoline topique dans le traitement du ptosis63 Les effets indésirables apparus au cours du traitement étaient similaires en nature et en fréquence dans les groupes oxymétazoline et véhicule, les plus fréquents étant la kératite ponctuée, l’hyperémie conjonctivale, la vision floue, la sécheresse oculaire, la douleur au site d’instillation et la coloration de la cornée par le colorant vital. La plupart d’entre eux étaient d’une gravité légère à modérée et n’étaient pas liés au traitement de l’étude. Il n’y a pas eu de changements statistiquement significatifs de la pression artérielle, de la PIO, du diamètre de la pupille ou de l’acuité visuelle dans le groupe traité ou dans le groupe traité par le véhicule.
1. https://www.reviewofophthalmology.com/article/ ptosis-diagnostic-tips-and-surgical-options
2. Gonzalez-Esnaurrizar, G. The Epidemiology and Etiology of Ptosis in an Ophthalmic Center. Investigative Ophthalmology & Visual Science. 49 (13): 640. ISSN 1552-5783. Archived from the original on 2021-04-29.
3. https://www.reviewofophthalmology.com/article/ how-to-spot-and-treat-dangerous-ptosis
4. Bacharach J, Lee WW, Harrison AR, et al. A review of acquired blepharoptosis: prevalence, diagnosis, and current treatment options. Eye (Lond). 2021; Apr 29. [Epub ahead of print].
5. McKean-Cowdin R, Varma R, Wu J, Hays RD, Azen SP, Los Angeles Latino Eye Study Group. Severity of visual field loss and health-related quality of life. Am Ophthalmol. 2007,143: 1013-23.
6. Richards HS, Jenkinson E, Rumsey N, et al. The psychological well-being and appearance concerns of patients presenting with ptosis. Eye. 2014;28:296-302.
7. Meyer DR, Stern JH, Jarvis JM, Lininger LL. Evaluating the visual field effects of blepharoptosis using automated static perimetry. Ophthalmology. 1993;100:651-8.
8. Small RG, Meyer DR. Eyelid metrics. Ophthalmic Plast Reconstr Surg. 2004 Jul;20(4):266-7.
9. https://en.wikipedia.org/wiki/Ptosis_(eyelid)
10. Bacharach J, Lee WW, Harrison AR, Freddo TF. A review of acquired blepharoptosis: prevalence, diagnosis, and current treatment options. Eye (Lond). 2021;35(9): 2468-2481.
11. Sridharan GV, Tallis RC Leatherbarrow & Forman WM. A community survey of ptosis of the eyelid and pupit size of elderly people. Age Ageing. 1995;24(1)-21-24.
12. Paik J-S, Han K, Yang S-W, et al Blepharoptosis among Korean adults: age-related prevalence and threshold age for evaluation. BMC Ophthalmol 2020;20(1):99.
13. https://www.reviewofoptometry.com/article/the-odsguide-to-ptosis-workup
14. Alsuhaibani A. Bleph aroptosis. EyeWiki. February 3, 2022. https://ey ewiki.aao.ore/Blepharoptosis
15. Latting MW, Huggins A8, Marx OP, Giacometti JN. Clinical evaluation of btepharoptosis: distinguishing age-related ptosis from masquerade conditions. Semin Plast Surg. 2017;31(1)}:15-16.
16. Griepentrog GJ, Diehl NN, Mohney BG. Incidence and demographics of childhood ptosis. Ophthalmology. 2011;118(6):1180-1183.
17. Shukla UV, Patel BC. Congenital ptosis. In: StatPearis. StatPearls Publishing LLC; November 2, 2021. Accessed April 9, 2022. https://www.ncbi.nim.nih.gov/books/NBKS68688
18. Reede OL, Garcon E, Smoker WRK, Kardon R. Horner's syndrome: clinical and radiographic evaluation. Neuroimaging Clin N Am. 2008;18(2):369-385.
19. Klejch W, Vislisel JM, Allen RC. A primer on ptosis. EyeRounds.org. April 6, 2015. http://webeye.ophth.uiowa.edu/eyeforuny tutorials/ ptosis/index.htm
20. Stapleton F, Bakkar M, Carnt N, et al CLEAR-Contact lens complications. Cont Lens Anterior Eye. 2021;44(2):330-367.
21. Kanagalingam S, Miller NR. Horner syndrome: clinical perspectives. Eye Brain. 2015;7:35-46.
22. Wijemanne S, Vijayakumar D, Jankovic J. Apraclonidine in the treatment of ptosis. J Neurol Sci. 2017:376:129-132.
23. King M. Management of ptosis. J Clin Aesthet Dermatol. 2016;9(12):E1-E4.
24. Traumatic Ptosis: Evaluation of Etiology, Management and Prognosis. .https://www.ncbi.nlm.nih.gov/pmc/ articles/PMC6210876/
25. Wladis EJ. Traumatic ptosis. American Academy of Ophthatmology. https://www.aao.org/oculoplasticscenter/traumatic-ptosis
26. Finsterer J. Ptosis: causes, presentation, and management. Aesthetic Plast Surg. 2003;27:193–204. doi: 10.1007/ s00266-003-0127-5.
27. Latting MW, Huggins AB, Marx DP, Giacometti JN. Clinical evaluation of blepharoptosis: distinguishing age-related ptosis from masquerade conditions. Semin Plast Surg. 2017;31:5–16. doi: 10.1055/s-0037-1598190.
28. Lim JM, Hou JH, Singa RM, Aakalu VK, Setabutr P. Relative incidence of blepharoptosis subtypes in an oculoplastics practice at a tertiary care center. Orbit. 2013;32:231–4. doi: 10.3109/01676830.2013.788673.
29. Sudhakar P, Vu Q, Kosoko-Lasaki O, Palmer M. Upper eyelid ptosis revisited. Am J Clin Med. 2009;6:5–14.
30. Forman WM, Leatherbarrow B, Sridharan GV, Tallis RC. A community survey of ptosis of the eyelid and pupil size of elderly people. Age Ageing. 1995;24:21–24. doi: 10.1093/ ageing/24.1.21.
31. Hashemi H, Khabazkhoob M, Emamian MH, Yekta A, Jafari A, Nobovati P, et al. The prevalence of ptosis in an Iranian adult population. J Curr Ophthalmol. 2016;28:142–5. doi: 10.1016/j.joco.2016.04.005.
32. Kim MH, Cho J, Zhao D, Woo KI, Kim YD, Kim S, et al. Prevalence and associated factors of blepharoptosis in Korean adult population: the Korea National Health and Nutrition Examination Survey. Eye. 2017;31:940–6. doi: 10.1038/eye.2017.43.
33. Thean JHJ, McNab AA. Blepharoptosis in RGP and PMMA hard contact lens wearers. Clin Exp Optom. 2004;87:11–14. doi: 10.1111/j.1444-0938.2004.tb03139.x.
34. Bleyen I, Hiemstra CA, Devogelaere T, van den Bosch WA, Wubbels RJ, Paridaens DA. Not only hard contact lens wear but also soft contact lens wear may be associated with blepharoptosis. Can J Ophthalmol. 2011;46:333–6. doi: 10.1016/j.jcjo.2011.06.010.
35. Hwang K, Kim JH. The risk of blepharoptosis in contact lens wearers. J Craniofac Surg. 2015;26:e373–e374. doi: 10.1097/SCS.0000000000001876.
36. Satariano N, Brown MS, Zwiebel S, Guyuron B. Environmental factors that contribute to upper eyelid ptosis: a study of identical twins. Aesthet Surg J. 2015;35:235–41. doi: 10.1093/asj/sju070.
37. Wang Y, Lou L, Liu Z, Ye J. Incidence and risk of ptosis following ocular surgery: a systematic review and metaanalysis. Graefes Arch Clin Exp Ophthalmol. 2019;257:397–404. doi: 10.1007/s00417-018-4130-6.
38. Godfrey KJ, Korn BS, Kikkawa DO. Blepharoptosis following ocular surgery: identifying risk factors. Curr Opin Ophthalmol. 2016;27:31–37. doi: 10.1097/ ICU.0000000000000218.
39. Linberg JV, McDonald MB, Safir A, Googe JM. Ptosis followoing radial keratectomy: performed using a rigid eyelid speculum. Ophthalmology. 1986;93:1509–12. doi: 10.1016/S0161-6420(86)33529-2.
40. Loeffler M, Solomon LD, Renaud M. Postcataract extraction ptosis: effect of the bridle suture. J Cataract Refract Surg. 1990;16:501–4. doi: 10.1016/S08863350(13)80807-3.
41. Cavallini M, Cirillo P, Fundaro SP, Quartucci S, Sciuto C, Sito G, et al. Safety of botulinum toxin A in aesthetic treatments: a systemitc review of clinical studies. Dermatol Surg. 2014;40:525–36. doi: 10.1111/dsu.12463.
42. Steinsapir KD, Groth MJ, Boxrud CA. Persistence of upper blepharoptosis after cosmetic botulinum toxin type A. Dermatol Surg. 2015;41:833–40. doi: 10.1097/ DSS.0000000000000386.
43. Wijemanne S, Vijayakumar D, Jankovic J. Apraclonidine in the treatment of ptosis. J Neurol Sci. 2017;376:129–32. doi: 10.1016/j.jns.2017.03.025.
44. Pauly M, Sruthi R. Ptosis: evaluation and management. Kerala J Ophthalmol. 2019;31(1):11-16.
45. Yadegari S. Approach to a patient with blepharoptosis. Neurol Sci. 201 6;37(10):1589-1596.
46. Boisvert CJ, Tran N-A. Anisocoria. EyeWiki. January 29, 2022.
47. Ho SF, Morawski A, Sampath R, Burns J. Modified visual field test for ptosis surgery (Leicester Peripheral Field Test). Eye (Lond). 2011;25(3):365-369.
48. Greer C, Burnstine MA. Nonsurgical management of ptosis. Ento Key. https//entokey.com/37-nonsurgical-management-ofptosis/
49. Mendonca TB, Lummertz AP, Bocaccio FJL, Procianoy F. Effect of low-concentration, nonmydriatic selective alphaadrenergic agonist eyedrops on upper eyelid position. Dermatol Surg. 2017;43(2):270-274.
50. US National Library of Medicine. Apraclonidine ophthalmic package insert. Updated July 25, 2019. Accessed April 9, 2022. https://dailymed.nim.nih.gov/dailymed
51. US National Library of Medicine. Apraclonidine hydrochloride solutions/drops package insert. Updated October 7, 2021. Accessed April 9, 2022. https://dailymed.nimnih.gov/dailymed
52. Kirkpatrick CA, Shriver EM, Clark TJE, Kardon RH. Upper eyetid response to topical 0.5% apraclonidine. Ophthaimic Plast Reconstr Surg. 2018;34(1)13-19.
53. Omoigui S, irene S. Treatment of ptosis as a complication of botulinum toxin injection. Pain Med. 2005;6(2):149-151.
54. US National Library of Medicine. Brimonidine tartrate soiution/drops package insert. Updated August 31, 2021. Accessed April 9, 2022. https://dailymed.nimnih.gov/dailymed/
55. US National Library of Medicine. Brimonidine tartrate ophthalmic solution package insert. https://dailymed.nimnih.gov/dailymed
56. Pao KY, Mancini R. Nonsurgical periocular rejuvenation: advanced cosmetic uses of neuromodulators and fillers. Curr Opin Ophthalmol. 2014;25(5):461-469,
57. Sundaram H, Kiripolsky M. Nonsurgical rejuvenation of the upper eyelid and brow. Clin Plast Surg. 2013;40(1):55-76.
58. US National Library of Medicine. Oxymetazoline hydrochloride ophthalmic solution/drops package insert. Updated August 1, 2021. Accessed April 9, 2022. https://dailymed.nlm.nih.gov/dailymed/
59. US National Library of Medicine. Oxymetazoline hydrochloride spray package insert. Updated January 15, 2019. Accessed April 9, 2022. https://dailymed.nimnih.gov/dailymed/
60. US National Library of Medicine. Oxymetazoline hydrochloride cream package insert. Updated October 8, 2021. Accessed April 9, 2022. https://dailymed.nimnih.gov/dailymed/
61. Bacharach J, Wirta DL, Smyth-Medina R, et al Rapid and sustained eyelid elevation in acquired blepharoptosis with oxymetazoline 0.1%: randomized phase 3 trial results. Clin Ophthaimol. 2021;15:2743-2751.
62. Stonim CB, Foster S, Jaros M, et al. Association of oxymétazoline hydrochloride, 0.1%, solution administration with visual field in acquired ptosis: a pooled analysis of 2 randomized clinical trials. JAMA Ophthalmol. 2020;138(11):1168-1175.




Pour les professionnels de la santé et les propriétaires de cliniques visuelles, une fiducie peut être un outil avantageux en matière de planification fiscale et successorale. Pour en apprendre plus sur ce type de véhicule juridique et ses avantages, découvrez les conseils de Julie Hébert, directrice principale au sein de l’équipe de fiscalité de MNP.

En termes juridiques, il s’agit d’un patrimoine d’affectation autonome et distinct. En d’autres mots, c’est un acte par lequel une personne (le « constituant ») transfère un ou des biens à une ou plusieurs personnes (le ou les « fiduciaire(s) ») au profit de tiers (les « bénéficiaires »). L’acte de fiducie viendra imposer certaines conditions et restrictions quant à l’administration des biens transférés. Tout bien qui est transféré dans une fiducie sort du patrimoine personnel de l’auteur du transfert. La fiducie n’est pas une entité juridique en soi, mais elle est toutefois considérée comme un particulier aux fins fiscales. Elle est utile à toute personne (particulier ou professionnel) et peut être créée en tout temps, sous réserve de sa situation personnelle, qui peut varier d’un individu à l’autre. La fiducie constitue un outil particulièrement avantageux pour les entrepreneurs.
Une fiducie peut être utilisée pour diverses fins. Voici les avantages les plus connus :
Le report de l’impôt au décès : Lorsqu’une personne décède, elle est réputée, en vertu des lois fiscales, avoir disposé de l’ensemble de ses biens à leur juste valeur marchande immédiatement avant son décès, bien qu’il n’y ait pas de disposition ou de vente réelle. Cette disposition réputée entraîne un gain en capital si les biens visés avaient accumulé une plus-value. Or, les biens détenus par la fiducie ne sont pas visés par cette disposition réputée, puisqu’ils ne font pas partie du patrimoine du défunt. Cela a pour effet de reporter l’impôt dans le temps. La protection d’actifs : En cas de poursuite ou d’une faillite, une fiducie peut offrir une certaine protection, puisque les biens qu’elle détient sont exclus du patrimoine personnel de l’individu visé par la poursuite ou la faillite. À titre d’exemple, une fiducie pourrait être constituée pour fins de détention et protection de la résidence familiale.
La multiplication de l’exonération du gain en capital : Chaque particulier au Canada peut bénéficier d’une exonération d’impôt à vie sur gain en capital. En 2024, l’exonération est de 1 016 836 $ (ce montant est indexé annuellement) sur la vente d’actions admissibles d’une petite entreprise canadienne.
Lorsque ces actions sont détenues et vendues par une fiducie plutôt que par un individu, chacun des bénéficiaires de la fiducie peut bénéficier de cette exonération. Cette dernière sera donc multipliée par le nombre de particuliers désignés bénéficiaires de la fiducie (normalement l’entrepreneur et les membres de sa famille), ce qui générera une économie d’impôt importante.
Une plus grande latitude quant au transfert de l’entreprise à la prochaine génération : L’entrepreneur n’est pas toujours en mesure de déterminer si l’un ou plusieurs de ses enfants souhaiteront intégrer l’entreprise dans le futur. En constituant une fiducie, laquelle détiendra les actions de la société, l’entrepreneur pourra attendre d’être en mesure de déterminer à qui il passera le flambeau et attribuer les actions aux enfants qui souhaiteront reprendre l’entreprise.
Il existe deux types de fiducies : les fiducies entre vifs, soit celles établies du vivant de la personne, et les fiducies testamentaires, soit celles établies aux termes d’un testament et entrant en vigueur uniquement au décès du constituant.
Pour les entreprises et les professionnels de la santé, la fiducie la plus couramment utilisée est la fiducie familiale qui aura comme principal objectif la détention des actions de la société opérante. La fiducie familiale peut être entre vifs ou testamentaire, mais le plus souvent elle est entre vifs, c’est-à-dire qu’elle sera constituée et opérante du vivant de l’entrepreneur et pourra se poursuivre au-delà du décès de celui-ci au bénéfice des autres bénéficiaires.
Quels sont les rôles des intervenants au sein d’une fiducie?
Constituant : Il s’agit d’un particulier qui crée la fiducie en établissant les modalités de celle-ci en lui transférant des biens. Ce particulier est aussi connu sous le nom de « donateur » ou « cédant ».
Fiduciaire : Il s’agit du propriétaire en droit des biens (notion de Common Law) chargé de leur administration conformément aux modalités de l’acte de fiducie et aux lois pertinentes régissant les fiducies. La Loi constitutive permet généralement au constituant de se nommer fiduciaire. Toutefois, pour des raisons fiscales, et sauf dans certains cas (c'est-à-dire une fiducie au bénéfice de soi-même), le fiduciaire ne devrait pas être la même personne que le constituant.
Bénéficiaire(s) : Il s’agit de la ou les personnes au profit desquelles la fiducie est constituée. Ils sont les propriétaires ultimes des biens et des revenus y afférents.
Les bénéficiaires sont habituellement l’entrepreneur ainsi que les membres de sa famille immédiate (conjoint ou conjointe, enfants, petits enfants).
Les étapes pourront différer d’un professionnel à l’autre en fonction de sa situation personnelle. Par exemple, si le professionnel n’est pas encore incorporé, la constitution de la fiducie pourra se faire immédiatement avant l’incorporation de la société professionnelle et de la société de gestion, le cas échéant.
Si le professionnel est déjà incorporé, l’intégration de la fiducie à la structure corporative existante nécessitera une « remise à zéro » de la valeur de la société. Pour se faire, les actions participantes détenues par le professionnel seront converties en actions privilégiées dont la valeur correspondra à la valeur de la société à ce moment. Une fois cette opération réalisée et la fiducie constituée, cette dernière pourra souscrire à de nouvelles actions participantes de la société pour une considération minimale. Dans un contexte comme celui ci, une évaluation de la société pourra s’avérer nécessaire.

Un acte de fiducie contient de nombreuses subtilités fiscales et plusieurs aspects techniques. Dans tous les cas, la documentation nécessaire devra être complétée par un conseiller juridique (notaire ou avocat).
de vie d’une fiducie
Selon le Code civil du Québec, une fiducie a une durée de vie de cent ans. Toutefois, les lois fiscales établissent certaines règles afin d’éviter que l’impôt sur les gains réalisés sur les actifs de la fiducie soit reporté indéfiniment dans le temps. Ainsi, en vertu de la Loi de l’impôt sur le revenu, une fiducie est généralement réputée disposer de ses biens à son 21e anniversaire. C’est donc pour cette raison que de nombreuses fiducies limiteront leur existence à 21 ans et s’assureront de distribuer leurs actifs aux bénéficiaires, le plus souvent en franchise d’impôt, afin de contourner cette règle de disposition réputée.
Quels sont les inconvénients d’une fiducie?
La constitution d’une fiducie est un processus qui peut être lourd et onéreux. De plus, la fiducie sera soumise à certaines règles et obligations tout au long de son existence. Elle devra, notamment, produire une déclaration de revenus annuellement. Cette déclaration vient s’ajouter à la déclaration de revenus personnelle de l’entrepreneur de même qu’à celle de chacune des sociétés faisant partie de la structure corporative, occasionnant ainsi des honoraires professionnels supplémentaires.
Depuis quelques années, les fiducies sont sous la loupe des autorités fiscales. Les exigences en matière de déclaration fiscale et de divulgation ont été resserrées afin de fournir aux autorités fiscales une plus grande transparence au détriment de la protection des renseignements confidentiels autrefois accordée aux fiduciaires et aux bénéficiaires. Ces nouvelles exigences contribuent à la lourdeur du maintien de la fiducie au sein de la structure corporative.
De quelle façon MNP peut-il vous aider?
Chaque situation est unique. C’est pourquoi une rencontre avec l’équipe de fiscalité de MNP permettra d’analyser votre situation et de déterminer s’il s’agit du bon moment pour procéder à l’incorporation de votre pratique professionnelle, mettre en place une fiducie, ou encore constituer une société de gestion. Notre équipe vous accompagnera tout le long du processus et saura vous guider, ainsi que vos conseillers juridiques, dans la mise en place de votre nouvelle structure. Ils pourront également vous mettre en lien avec des conseillers juridiques et autres types de professionnels au gré de vos besoins.
Bien que la mise en place d’une fiducie puisse offrir de nombreux avantages, il n’en demeure pas moins qu’il s’agit d’un mécanisme comportant de nombreuses subtilités fiscales et plusieurs aspects techniques. Il est donc important de consulter des professionnels en la matière. Notre équipe de fiscalistes sera en mesure de vous aider à choisir la formule la mieux adaptée à votre situation et à votre entreprise. N’hésitez pas à nous contacter si vous désirez entreprendre ce genre de démarches.

Voyez-y clair avec notre équipe dévouée aux professionnels de la vue
Nos conseillers peuvent vous aider pour la constitution d’une fiducie.

Julie Hébert, notaire M. Fisc., Directrice principale, Fiscalité 579.309.0415 | julie.hebert@mnp.ca

Afin de souligner le mois de la santé visuelle, le CPRO vous offre 15% de rabais sur toutes les autoformations du 1er au 7 mai
- Mois de la santé visuelle 15% de rabais sur les autoformations
Nous vous rappelons que lorsque vous vous inscrivez à une autoformation, vous y avez accès dès que le paiement est finalisé; vous avez 90 jours suivant la date d’achat pour regarder la formation et compléter l’examen et le contenu de la conférence demeure disponible dans votre dossier pendant 1 an.
Profitez-en pour faire le plein d’UFC!


Cet automne, le colloque aura lieu les 4 et 5 octobre prochains et c’est avec grand plaisir que nous retournons au Palais des congrès de Montréal
En 2025, le Colloque reprend sa formule sur trois jours et se déroulera du 24 au 26 octobre, toujours au Palais des congrès de Montréal.
Réservez ces dates! Les inscriptions pour le Colloque 2024 ouvriront en septembre

Dans un effort visant à contrer les effets dévastateurs de la crise du logement, le gouvernement du Québec a adopté récemment le projet de loi 31. La Loi modifiant diverses dispositions législatives en matière d’habitation (ci-après PL-31) est entrée en vigueur le 21 février 2024, apportant d’importants changements au droit du logement. Que vous soyez locataire ou propriétaire d’un immeuble à revenus, il est crucial que vous soyez informés de ces nouveautés qui auront un impact considérable sur vos droits et obligations.

L’éviction
Le propriétaire d’un logement peut en évincer le locataire s’il souhaite subdiviser le logement, l’agrandir substantiellement ou en changer l’affectation1. Pour ce faire, il doit transmettre un avis d’éviction au locataire au moins six mois avant l’expiration du bail à durée fixe ou, lorsque le bail est à durée indéterminée, six mois avant la date prévue de l’éviction2. Le locataire dispose alors d’un délai d’un mois pour faire connaître ses intentions au propriétaire, soit de se conformer à l’avis d’éviction ou non.
a. Avant le PL-31 : Avant la nouvelle législation, le locataire qui ne répondait pas à l’avis d’éviction dans le délai d’un mois était réputé avoir consenti à quitter les lieux. S’il désirait s’opposer au projet du propriétaire, c’est le locataire qui avait le fardeau de s’adresser au Tribunal administratif du logement (ci-après « TAL »). De plus, les locataires ainsi évincés n’avaient droit qu’à une indemnité équivalente à trois mois de loyer ainsi qu’au remboursement des frais raisonnables de déménagement.
1 Article 1959 Code civil du Québec (ci-après « C.c.Q. »).
2 Article 1960 C.c.Q.
b. Depuis le 21 février 2024 : Le locataire qui reçoit un avis d’éviction n’a plus à introduire un recours devant le TAL. S’il omet d’aviser le propriétaire de ses intentions dans le mois qui suit la réception de l’avis, il est réputé avoir refusé de quitter le logement. C’est donc le propriétaire qui devra obtenir l’autorisation du TAL pour procéder à l’éviction. Il devra démontrer qu’il entend réellement évincer le locataire pour les fins mentionnées dans l’avis et qu’il ne s’agit pas d’un prétexte pour atteindre d’autres fins. L’indemnité devant être versée au locataire évincé a également été bonifiée pour tenir compte de la durée d’occupation du logement par ce dernier. En effet, en plus de rembourser les frais raisonnables de déménagement, le propriétaire sera tenu de verser une indemnité équivalente à un mois de loyer pour chaque année de location ininterrompue du logement par le locataire, pour un maximum de 24 mois de loyer.
Finalement, la présomption de bonne foi du propriétaire est écartée, permettant ainsi à tout locataire faisant l’objet d’une éviction ou d’une reprise de logement de s’adresser au TAL pour demander des dommagesintérêts. Il revient désormais au propriétaire de prouver que l’éviction ou la reprise est effectuée de bonne foi et ne constitue pas des manœuvres illicites visant à contourner la loi.

En bonifiant l’indemnité payable aux locataires et en dérogeant à la présomption de bonne foi applicable en droit civil québécois, le PL-31 démontre un souci de mieux protéger les locataires contre le fléau des rénovictions.
La cession de bail
Le locataire ne désirant plus habiter dans son logement peut céder son bail à un tiers (ci-après « le cessionnaire »). Il doit alors aviser le propriétaire de l’identité du cessionnaire et doit obtenir le consentement du propriétaire. Cette cession de bail a pour effet de décharger entièrement l’ancien locataire de ses obligations et de transmettre les droits et obligations résultant du bail au cessionnaire.
a. Avant le PL-31 : Un propriétaire ne pouvait refuser la cession de bail à moins d’alléguer un motif sérieux, par exemple l’insolvabilité du cessionnaire. Dans ce cas, lors d’un refus injustifié, le locataire devait s’adresser au TAL pour faire valoir son droit de cession de bail. Par ailleurs, il était possible pour un locataire de « vendre » au cessionnaire ses droits découlant du bail et d’effectuer une cession de bail et même une sous-location à profit.
b. Depuis le 21 février 2024 : Désormais, dans son avis de cession de bail, le locataire devra indiquer la date de cession prévue. Quant à lui, le propriétaire pourra refuser de consentir à la cession pour tout motif. Dans ce cas, le bail sera résilié de plein droit à la date de cession indiquée dans l’avis transmis par le locataire. Nul besoin pour le locataire de s’adresser au TAL. Par ailleurs, il est désormais interdit à un locataire d’effectuer une sous-location ou une cession de bail à but lucratif. Le locataire qui cède son bail ne pourra exiger une contrepartie. Quant à la sous-location, le locataire ne pourra exiger du sous-locataire un loyer supérieur au loyer dû au propriétaire en vertu du bail.
3 Article 1896 C.c.Q.
4 Article 1950 C.c.Q.
Cet amendement à la loi suscite l’indignation des organismes défenseurs des droits des locataires. Malgré qu’il offre une plus grande flexibilité aux locataires d’être libéré de leur bail, plusieurs craignent des augmentations de loyer indues dans un contexte où le coût des loyers grimpe déjà de manière fulgurante. En effet, les propriétaires ayant désormais la possibilité de refuser la cession de bail pourraient ainsi récupérer le logement afin d’y effectuer des travaux et de le relouer plus cher par la suite.
Lors de la signature d’un bail, le propriétaire doit remettre au locataire un avis indiquant le loyer le plus bas payé au cours des 12 mois précédant le début du bail3. Aussi connu sous la « clause G » des baux résidentiels, cet avis protège les nouveaux locataires contre des hausses abusives. Dans les 10 jours de la signature du bail, le nouveau locataire peut s’adresser au TAL pour exiger une fixation de loyer s’il paie un loyer supérieur au locataire précédent. Si la clause G n’est pas remplie par le propriétaire, le nouveau locataire bénéficie alors d’un délai de deux mois pour demander une fixation de loyer au TAL4
a. Avant le PL-31 : Les propriétaires qui omettaient de remplir la clause G du bail n’étaient soumis à aucune pénalité.
b. Depuis le 21 février 2024 : Maintenant, pour les baux conclus depuis le 21 février 2024, le propriétaire qui inscrit de fausses informations dans cet avis ou qui omet volontairement de remplir la clause G s’expose à devoir verser des dommages-intérêts punitifs à la demande du locataire.
Il est à prévoir que le locataire aura le fardeau de prouver que l’omission du propriétaire était volontaire et empreinte de mauvaise foi afin de réclamer des dommages-intérêts punitifs. La jurisprudence des prochaines années nous en dira certainement davantage sur le sujet.
L’augmentation de loyer des constructions neuves
Pendant les cinq premières années suivant la construction d’un logement locatif neuf, le propriétaire peut en augmenter le loyer sans être assujetti aux balises établies par le TAL. Pour bénéficier de cette latitude, la « clause F » du bail doit avoir été cochée. Dans ces cas, le locataire qui refuse une augmentation de loyer annuelle devra quitter son logement.
a. Avant le PL-31 : Cette clause F prévue dans les baux résidentiels vise à atténuer les risques pour les promoteurs et les développeurs de nouveaux logements locatifs. L’explosion des coûts des matériaux, de la main-d’œuvre et des taux d’intérêt fait très mal aux investisseurs locatifs. Cette clause leur permet de réajuster les loyers à la réalité d’un marché variable. Or, le revers de la médaille est une grande imprévisibilité de la hausse des loyers pour les locataires, des hausses pouvant atteindre 30 % ont été médiatisées.
b. Depuis le 21 février 2024 : Les modifications adoptées par le PL-31 imposent désormais au propriétaire l’obligation d’inclure à la clause F du bail le loyer maximal qu’il pourrait exiger au cours des cinq premières années. Par conséquent, le locataire est informé dès la conclusion du bail du montant maximal que son loyer pourrait atteindre dans une période de cinq ans et peut ainsi prendre une décision libre et éclairée de signer le bail ou non.
Encore une fois, la jurisprudence nous permettra certainement d’en connaître davantage sur les exigences qu’imposeront les tribunaux quant à la déclaration du propriétaire à la clause F. Celui-ci pourrait-il par exemple prévoir un loyer maximal exagérément élevé afin de se donner une grande marge de manœuvre et ainsi pouvoir augmenter le loyer à sa guise ?
Représentation devant le tal
Les règles de représentation devant le TAL ont également été assouplies afin d’assurer une meilleure accessibilité à la justice.
a. Avant le PL-31 : Une personne physique ne pouvait être représentée que par les personnes suivantes :
Son conjoint;
Un parent, seulement si la personne est dans l’impossibilité de se présenter elle-même pour cause de maladie, d’éloignement ou d’une autre cause jugée suffisante;
Une autre personne physique qui est également partie à la demande;
Un avocat, seulement si l’objet de la demande n’était pas le recouvrement d’une créance inférieure à 15 000,00 $.
Quant aux personnes morales, elles devaient être représentées par un administrateur, un dirigeant, un employé ou un avocat si l’objet de la demande n’était pas le recouvrement d’une créance inférieure à 15 000,00 $.
b. Depuis le 21 février 2024 : Les personnes physiques et morales peuvent désormais être représentées par la personne de leur choix. La seule restriction est qu’il n’est pas possible d’être représenté par un professionnel radié, déclaré inhabile à exercer sa profession ou dont le droit d’exercer des activités professionnelles a été limité ou suspendu. Cette nouveauté permettra tant aux locataires qu’aux propriétaires d’être représentés par des tiers défenseurs de leurs droits à moindre coût que par des avocats (par exemple : comité de logement ou association de propriétaires). D’ailleurs la représentation par avocat demeure limitée aux seuls dossiers dont l’objet n’est pas le recouvrement d’une créance inférieure à 15 000,00 $.
Le PL-31 prévoit de nombreuses autres nouveautés dans le domaine de l’habitation. Si vous êtes locataire ou propriétaire et que vous avez des questions à ce sujet, vous pouvez communiquer avec les avocats de votre ligne d’assistance téléphonique juridique gratuite du lundi au vendredi de 8 h à 18 h en composant le 1-877-579-7052.







Grâce à la section des petites annonces classées de la revue l’Optométriste vous faites d’une pierre deux coups : votre annonce, au coût de 25 $ par parution (taxes en sus), sera publiée dans la revue et sera distribuée aux optométristes, aux opticiens d’ordonnances, aux ophtalmologistes et aux compagnies d’optique. Elle se retrouvera également sur notre site Internet jusqu’à la parution de la prochaine revue. Vous bénéficierez donc d’une visibilité accrue.
Votre annonce doit contenir environ 50 mots et doit être au nom d’un optométriste membre de l’AOQ. Vous devez nous faire parvenir votre annonce par courriel à josee.lusignan@aoqnet.qc.ca ou par télécopieur au 514 288-7071.


Le printemps est arrivé et les patients souffrant d'allergies saisonnières vont bientôt affluer dans votre clinique pour chercher à soulager leurs démangeaisons et leurs yeux brûlants.
Saviez-vous que vous pouvez faire la différence en leur offrant une alternative éprouvée aux antihistaminiques et aux stabilisateurs de mastocytes1,2 pour le soulagement des allergies saisonnières, et ce, directement dans votre clinique ?
Le nouveau HYLO-DUAL® mini (nouveau format d'emballage de départ) ou le HYLO-DUAL® déjà bien établi sont indiqués pour le soulagement immédiat des démangeaisons et de la sensation de brûlure causées par les allergies ainsi que des symptômes de sécheresse oculaire.
Quels sont les avantages pour vous et vos patients ?
HYLO-DUAL® mini et HYLO-DUAL® sont les seules gouttes contre les allergies et la sécheresse oculaire à être vendues au détail dans votre clinique d'optométrie. Elles sont aussi efficaces que les antihistaminiques modernes et les stabilisateurs de mastocytes (et supérieures au cromoglycate) avec une meilleure tolérance1,2 et elles sont sans agent de conservation et sans phosphate pour une sensation de confort et une utilisation avec n'importe quelle lentille de contact.
Pour commander, n'hésitez pas à contacter Candorvision (info@candorvision.com).
Références:
1. Allegri P, Marrazzo G, Ciurlo C, Mastromarino A, Autuori S, Murialdo U. Retrospective study to evaluate the efficacy on vernal kerato-conjunctivitis (VKC) of 2% Ectoine versus 0.05% ketotifen eye-drops. Invest Ophthalmol Vis Sci 2014 Apr; 55(13):2492.
2. Werkhäuser N, Bilstein A, Sonnemann U. Treatment of allergic rhinitis with ectoine containing nasal spray and eye drops in comparison with azelastine containing nasal spray and eye drops or with cromoglycic acid containing nasal spray. J Allergy (Cairo). 2014;2014:176597. doi: 10.1155/2014/176597. Epub 2014 Jun 1. PMID: 24982680; PMCID: PMC4058592.


Antiseptiques topiques pour réduire au minimum la charge bactérienne de la surface oculaire avant une chirurgie ophtalmique : un essai contrôlé randomisé
Points forts
La chlorexidine topique 0,02 % et la povidone iodée 0,6 % ont réduit de manière significative la charge bactérienne de la surface oculaire.
La chlorexidine 0,02 % et la povidone iodée 0,6 % ont toutes deux préservé la composition taxonomique conjonctivale.
Dans cet essai randomisé, la chlorexidine 0,02 % a induit une réduction plus importante de la charge bactérienne et a été mieux tolérée.
Objectif : Étudier la réduction de la charge bactérienne de la surface oculaire induite par deux formulations antiseptiques ophtalmiques disponibles dans le commerce, la povidone iodée (PVI) 0,6 % et la chlorexidine (CLX) 0,02 %, avant une intervention chirurgicale oculaire.
Conception : Essai contrôlé randomisé.
Méthodes utilisées : Soixante-dix patients adultes, subissant une chirurgie intraoculaire (phacoémulsification), ont été sélectionnés au hasard pour recevoir dans l’œil index PVI (groupe A) QID pendant 3 jours ou CLX (groupe B) QID pendant 3 jours avant l’opération. L’œil non traité a servi de contrôle. Un écouvillon conjonctival a été prélevé dans les deux yeux avant (T0) et après (T1) le traitement. L’ADN microbien a été quantifié par analyse PCR en temps réel. L’algorithme Mick a été utilisé pour comparer l’abondance de chaque genre/générique à la distribution des abondances de la référence. À T1, les patients ont rempli un questionnaire pour évaluer les symptômes induits par la thérapie. Le résultat principal était la réduction de l’ADN bactérien à T1 (charge microbienne), par rapport au bras de contrôle, exprimée en nombre moyen de temps de cycle PCR en temps réel (CT). Les résultats secondaires étaient la composition taxonomique, l’abondance différentielle et les symptômes oculaires induits par la thérapie.
Résultats : La différence T0-T1 dans le CT était significative dans le groupe B, mais pas dans le groupe A (moyenne [IC 95 %], 0,99 [0,33] c. 0,26 [0,15], p < 0,001, et 0,65 [0,3] c. 0,45 [0,41], p = 0,09, respectivement). La composition taxonomique, la diversité alpha et bêta sont restées constantes à tous les moments dans les deux groupes. Le taux de patients rapportant des symptômes oculaires induits par la thérapie et le degré d’inconfort moyen étaient plus élevés dans le groupe A que dans le groupe B (97 % contre 26 % et 4,97 ± 2,48 contre 0,66 ±1,53, respectivement).
Conclusions : Comparé au PVI 0,6 %, le CLX 0,02 % a induit une plus grande réduction de la charge bactérienne de la surface oculaire, sans altération significative de la composition taxonomique. De plus, CLX a été mieux toléré que PVI.
Source : https://www.ajo.com/article/S0002-9394 (24) 00010-2/fulltext

En ciblant l’évaporation des larmes, le F6H8 ouvre une nouvelle ère dans le traitement de la sécheresse oculaire.
L’approbation du perfluorohexyloctane (Miebo; Bausch + Lomb) pour le traitement des signes et symptômes de la sécheresse oculaire suscite beaucoup d’enthousiasme. Le perfluorohexyloctane (F6H8) cible directement l’évaporation des larmes1. Il s’agit d’un alcane semi-fluoré (SFA) qui stabilise le film lacrymal à la surface de l’œil, stoppant l’évaporation des larmes et empêchant la dessiccation de la surface oculaire.
Les composés fluorés sont utilisés dans des applications cliniques et biomédicales depuis des décennies. Les SFA, qui sont des molécules diblocs et n’existent pas à l’état naturel, sont des liquides inertes, incolores et non aqueux, constitués de molécules de perfluorocarbone et d’hydrocarbure. La nomenclature des SFA est simplifiée sous la forme FnHm, dans laquelle « n » et « m » décrivent le nombre d’atomes de carbone dans les chaînes de fluorocarbures et d’hydrocarbures, respectivement. La nouvelle classe d’alcanes semi-fluorés possède des propriétés physiochimiques qui incluent une grande solubilité dans les gaz (par exemple, pour l’oxygène) et une faible tension superficielle. En raison de leur forte propension à s’assembler aux interfaces, ils peuvent être utilisés pour formuler une variété de systèmes colloïdaux multiphasés, notamment des émulsions, des microbulles et des nanoémulsions, des gels, des dispersions, des suspensions et des aérosols2, 3
Les SFA peuvent dissoudre des médicaments lipophiles et, par conséquent, être utilisés comme nouveaux excipients ou systèmes d’administration de médicaments4. Les alcanes semi-fluorés forment des monocouches aux propriétés intéressantes à l’interface air-eau en raison de leur nature amphi-solvophobe prononcée (c’est-à-dire qu’ils n’ont pas d’affinité pour un solvant spécifique des deux côtés) et de la rigidité des fluorocarbones. Les SFA sont extrêmement hydrophobes, thermiquement, chimiquement et au laser stable, et biologiquement inertes en raison de l’absence de groupe fonctionnel3. En raison de leur structure moléculaire amphiphile (segments lipophobes et lipophiles), les SFA sont également lipophiles2
Les SFA, qui possèdent deux groupements de caractère opposé, un carbone perfluoré et un fragment hydrogéné, ont également des propriétés tensioactives (les tensioactifs sont des composés chimiques qui diminuent la tension de surface ou la tension interfaciale entre deux liquides, un liquide et un gaz, ou un liquide et un solide)5
Les SFA, par exemple le F6H8, sont utilisés en ophtalmologie clinique pour la chirurgie vitréo-rétinienne, sous forme d’endotamponnades lourdes à long terme, généralement mélangées à des huiles de silicone (SO)6. Cette combinaison peut être particulièrement bénéfique dans le traitement du décollement de la rétine rhegmatogène inférieur et de la vitréorétinopathie proliférative. Une étude de 2014 a examiné l’utilisation du F6H8 en combinaison avec l’huile de silicone dans une série de 22 yeux présentant un décollement de la rétine rhégmatogène inférieur avec une vitréorétinopathie proliférative, où le F6H8 a été utilisé pour aplatir la rétine et a ensuite été partiellement mélangé avec de l’huile de silicone pour un tamponnement à long terme.
Cette combinaison a donné lieu à un tamponnement clair permettant la visualisation postopératoire de la rétine, sans émulsification, inflammation ou autres complications. Plusieurs combinaisons différentes de F6H8/SO ont été utilisées dans cette étude – 30/70, 40/60, 50/50, 60/40 et 70/30. Les meilleurs résultats ont été obtenus avec des rapports F6H8/SO compris entre 50/50 et 30/70.7
Miebo, une goutte thérapeutique récemment approuvée pour le traitement de la sécheresse oculaire par évaporation, est composée à 100 % de perfluorohexyloctane dont les études cliniques ont démontré les effets bénéfiques pour les patients souffrant de sécheresse oculaire par évaporation8 et de dysfonctionnement des glandes de Meibomius 9 Comme le perfluorohexyloctane à 100 % est un liquide non aqueux, la croissance microbienne n’est pas possible et, par conséquent, il n’a pas besoin d’agent de conservation.
Le perfluorohexyloctane s’étale rapidement sur la surface oculaire en raison de sa faible tension superficielle; il provoque également des troubles visuels minimes par rapport aux traitements à base de gel ou de pommade, car son indice de réfraction est similaire à celui de l’eau10. En outre, un essai clinique randomisé de phase 3 (Gobi) a fourni des preuves statistiquement significatives d’une réduction des signes et des symptômes de la dermatite atopique pendant 8 semaines de traitement au perfluorohexyloctane par rapport aux patients traités au sérum physiologique11. Il a été proposé que le F6H8 puisse prévenir l’augmentation de l’évaporation causée par la dermatite atopique en formant une couche occlusive et en réduisant les forces de cisaillement de la paupière pendant le clignement des yeux9, 10
Outre la prévention de l’évaporation, le F6H8 peut faciliter l’échange de chaleur entre le tissu cornéen et l’environnement, réduisant ainsi la température de la cornée et activant le TRPM8 (transient receptor potential cation channel subfamily M [melastatin] member 8), canaux thermosensibles au froid des nerfs thermorécepteurs du froid. Le TRPM8 est également connu sous le nom de récepteur du froid et du menthol 1 (CMR1) et est une protéine codée par le gène TRPM8; le canal TRPM8 est le principal transducteur moléculaire de la somatosensation du froid chez l’homme. L’activité accrue des nerfs cornéens froids entraîne à son tour une augmentation du larmoiement et de la fréquence des clignements, mais ne provoque pas de réaction d’inconfort oculaire12
Les SFA peuvent également être efficaces comme vecteur de médicaments topiques, par exemple pour la cyclosporine et l’azithromycine, sur la surface oculaire13, 14. Les avantages des formulations SFA, en particulier pour les protéines et les anticorps, comprennent des gouttes oculaires prêtes à l’emploi avec une stabilité améliorée à température ambiante, ainsi qu’une meilleure absorption du médicament. Pour la cornée, par exemple, les particules en suspension de la SFA permettent d’obtenir une concentration locale élevée de médicament et un temps de séjour plus long.

Autres possibilités d’administration de médicaments par les SFA
Les SFA sont prometteurs pour l’administration topique de médicaments à la peau, ce qui est particulièrement difficile, car ils améliorent la pénétration cutanée. Cette amélioration s’expliquerait par un effet d’occlusion croissant avec la teneur en SFA de la nanoémulsion et, par conséquent, par la promotion de la pénétration dans la peau15. L’occlusion réduit l’évaporation de l’eau de la peau, nécessaire à la pénétration cutanée, et favorise donc la pénétration des substances actives dans la peau16
Les SFA ont également été étudiés pour l’administration de médicaments par voie intraveineuse, l’administration de médicaments par voie pulmonaire et l’administration de médicaments à base de protéines17-19. La faible viscosité des SFA en fait des options prometteuses en tant que vecteurs de suspensions de poudre19
Grâce à leur capacité à transporter de l’oxygène17, le potentiel des SFA offre de nouvelles possibilités pour le traitement de troubles systémiques multiples, y compris des voies passionnantes pour le développement de médicaments innovants pour des maladies autres que celles de l’œil.
1. Bausch + Lomb and Novaliq announce FDA approval of Miebo (perfluorohexyloctane ophthalmic solution) for the treatment of the signs and symptoms of dry eye disease. Novaliq. News release. May 18, 2023. Accessed October 1, 2023. https:// www.novaliq.com/press-releases/2023/05/19/ bausch-lomb-and-novaliq-announce-fda-approvalof-miebotm-perfluorohexyloctane-ophthalmicsolution-for-the-treatment-of-the-signs-and-symptomsof-dry-eye-disease/
2. Tsagogiorgas C, Otto M. Semifluorinated alkanes as new drug carriers—an overview of potential medical and clinical applications. Pharmaceutics. 2023;15(4):1211. doi:10.3390/pharmaceutics15041211
3. Krafft MP. Fluorocarbons and fluorinated amphiphiles in drug delivery and biomedical research. Adv Drug Deliv Rev. 2001;47(2-3):209-228. doi:10.1016/s0169409x(01)00107-7
4. Meinert H, Roy T. Semifluorinated alkanes— a new class of compounds with outstanding properties for use in ophthalmology. Eur J Ophthalmol. 2000;10(3):189-197. doi:10.5301/EJO.2008.1838
5. Turberg MP, Brady JE. Semifluorinated hydrocarbons: primitive surfactant molecules. J Am Chem Soc. 1988;110(23):7797–7801.doi:10.1021/ja00231a034
6. Kirchhof B, Wong D, Van Meurs J, et al. Use of perfluorohexyloctane as a long-term internal tamponade agent in complicated retinal detachment surgery. Am J Ophthalmol. 2002;133(1):95-101. doi:10.1016/s00029394(01)01295-8
7. Tosi GM, Marigliani D, Bacci T, et al. F6H8 as an intraoperative tool and F6H8/silicone oil as a postoperative tamponade in inferior retinal detachment with inferior PVR. J Ophthalmol. 2014;2014:956831. doi:10.1155/2014/956831
8. Steven P, Scherer D, Krösser S, Beckert M, Cursiefen C, Kaercher T. Semifluorinated alkane eye drops for treatment of dry eye diseasea prospective, multicenter noninterventional study. J Ocul Pharmacol Ther. 2015;31(8):498-503. doi:10.1089/jop.2015.0048
9. Steven P, Augustin AJ, Geerling G, et al. Semifluorinated alkane eye drops for treatment of dry eye disease due to meibomian gland disease. J Ocul Pharmacol Ther. 2017;33(9):678-685. doi:10.1089/jop.2017.0042
10. Schmidl D, Bata AM, Szegedi S, et al. Influence of perfluorohexyloctane eye drops on tear film thickness in patients with mild to moderate dry eye disease: a randomized controlled clinical trial. J Ocul Pharmacol Ther. 2020;36(3):154-161. doi:10.1089/jop.2019.0092
11. Tauber J, Berdy GJ, Wirta DL, Krösser S, Vittitow JL; GOBI Study Group. NOV03 for dry eye disease associated with meibomian gland dysfunction: results of the randomized phase 3 GOBI study. Ophthalmology. 2023;130(5):516-524. doi:10.1016/j.ophtha.2022.12.021
12. Delicado-Miralles M, Velasco E, Díaz-Tahoces A, Gallar J, Acosta MC, Aracil-Marco A. Deciphering the action of perfluorohexyloctane eye drops to reduce ocular discomfort and pain. Front Med (Lausanne). 2021;8:709712. doi:10.3389/fmed.2021.709712
13. Gehlsen U, Braun T, Notara M, Krösser S, Steven P. A semifluorinated alkane (F4H5) as novel carrier for cyclosporine A: a promising therapeutic and prophylactic option for topical treatment of dry eye. Graefes Arch Clin Exp Ophthalmol. 2017;255(4):767-775. doi:10.1007/s00417016-3572-y
14. Agarwal P, Craig JP, Krösser S, Eickhoff K, Swift S, Rupenthal ID. Topical semifluorinated alkane-based azithromycin suspension for the management of ocular infections. Eur J Pharm Biopharm. 2019;142:83-91. doi:10.1016/j.ejpb.2019.06.008
15. Binder L, Jatschka J, Kulovits EM, Seeböck S, Kählig H, Valenta C. Simultaneous penetration monitoring of oil component and active drug from fluorinated nanoemulsions. Int J Pharm. 2018;552(1-2):312–318. doi:10.1016/j.ijpharm.2018.10.012
16. Wissing S, Müller R. The influence of the crystallinity of lipid nanoparticles on their occlusive properties. Int J Pharm. 2002;242(1-2):377-379. doi:10.1016/s03785173(02)00220-x
17. Seiffge DJ, Lapina NE, Tsagogiorgas C, Theisinger B, Henning RH, Schilling L. Improvement of oxygen supply by an artificial carrier in combination with normobaric oxygenation decreases the volume of tissue hypoxia and tissue damage from transient focal cerebral ischemia. Exp Neurol. 2012;237(1):18-25. doi:10.1016/j. espneurol.2012.06.007
18. Tsagogiorgas C, Jung T, Krebs J, et al. Aerosolized semifluorinated alkanes as excipients are suitable for inhalative drug delivery—a pilot study. Int J Pharm. 2012;422(1-2):194-201. doi:10.1016/j.ijpharm.2011.10.051
19. Günther B, Theisinger B, Theisinger S, et al, inventors. Novaliq GMBH, assignee. Stabilised protein compositions based on semifluorinated alkanes. US Patent 9,757,460. September 12, 2017.

Analyse de l’efficacité de la lumière pulsée (M22) dans le traitement du dysfonctionnement des glandes de Meibomius dû aux acariens Demodex
Objectif : Étudier l’efficacité de la lumière intense pulsée (M22) dans le traitement des patients souffrant d’un dysfonctionnement des glandes de Meibomius causé par les acariens Demodex.
Méthodes : Un total de 100 patients (100 yeux) diagnostiqués avec des acariens demodex par examen microscopique à la clinique ophtalmologique Shanxi Bethune entre juin 2021 et mai 2023 ont été sélectionnés par échantillonnage de commodité. Les patients ont été divisés au hasard en deux groupes : un groupe expérimental (n = 50) et un groupe témoin (n = 50). Le groupe témoin a reçu un traitement complet comprenant des larmes artificielles, une compresse chaude, une pommade oculaire anti-inflammatoire, un nettoyage à l’acide hypochloreux, un tampon de coton au gombo et un massage des glandes de Meibomius. En plus du traitement complet, le groupe expérimental a reçu une thérapie à la lumière intense pulsée (M22). Après 8 semaines de traitement, le taux d’élimination des acariens et le taux de guérison de la sécheresse oculaire ont été mesurés pour les deux groupes. Le taux de récurrence de la sécheresse oculaire a également été observé 4 semaines après l’arrêt du traitement par M22.
Résultats : Le groupe expérimental a obtenu un taux de guérison des acariens de 88,0 %, tandis que le groupe témoin a obtenu un taux de 58,0 %, avec une différence statistiquement significative (χ2 = 5,43, P = 0,017). En ce qui concerne le taux de guérison de la sécheresse oculaire, le groupe expérimental a montré un taux de 92,0 %, tandis que le groupe témoin a eu un taux de 82,0 %, avec une différence statistiquement significative (χ2 = 3,61, P = 0,021). En ce qui concerne le taux de récurrence de la sécheresse oculaire, le groupe expérimental a présenté un taux de 13,04 %, alors que le groupe témoin a présenté un taux de 26,83 %, avec une différence statistiquement significative (χ2 = 4,18, P = 0,016).
Conclusion : La lumière intense pulsée (M22) a démontré une efficacité supérieure dans l’éradication des acariens demodex, le traitement de la sécheresse oculaire et le maintien de l’efficacité du traitement par rapport à un traitement complet avec des médicaments chez les patients souffrant d’une dysfonction des glandes de Meibomius avec des acariens demodex.
Source : Zhang W, Cao X, Yang L, Duan Y, Zhang W. Analysis of Treatment Efficacy of Intense Pulsed Light (M22) for Meibomian Gland Dysfunction with Demodex Mites. Clin Cosmet Investig Dermatol. 2023 Dec 27;16:3743-3751. doi: 10.2147/CCID.S435723. PMID : 38 164 126; PMCID : PMC10758316.

Rôle du 5-fluorouracil topique dans la blépharite associée à Demodex
Objectif : Le but de cette étude était de rapporter des observations cliniques suggérant l’efficacité du 5-fluorouracil (5-FU) topique à 1 % dans le traitement de la blépharite associée à Demodex.
Méthodes : Une étude rétrospective observationnelle de 13 yeux de 13 personnes présentant des lésions néoplasiques conjonctivales et une infestation concomitante des cils par Demodex qui ont reçu des gouttes ophtalmiques topiques de 5-FU à 1 %. Les patients ont subi un examen à la lampe à fente à chaque visite de suivi. Des photographies cliniques de la ligne des cils ont été prises après le début du traitement. Dans un sous-groupe de patients, les cils ont été épilés bilatéralement et analysés au microscope pour détecter la présence d’acariens Demodex avant et après le début du traitement.
Résultats : L’âge moyen de la population était de 68 ± 14 ans (intervalle : 30-84 ans) et 92 % étaient des hommes. Chez les 13 patients, un examen à la lampe à fente a permis de constater une réduction marquée des pellicules cylindriques dans l’œil traité après 2 cycles de 5-FU. On a observé une résolution complète des pellicules cylindriques dans 10 des 13 yeux traités, contre une résolution nulle des pellicules cylindriques dans les yeux non traités (P = 0,0001). Chez les 6 patients qui ont reçu une épilation, les cils de l’œil traité ne présentaient pas de Demodex, alors que les cils de l’autre œil non traité présentaient des Demodex persistants.
Conclusions : Le 5-FU topique à 1 % est efficace dans le traitement de la blépharite associée aux Demodex. D’autres études sont indiquées pour reproduire nos résultats et évaluer l’utilisation potentielle du 5-FU comme ingrédient de traitement.
Source : https://journals.lww.com/corneajrnl/fulltext/9900/role_of_topical_5_ fluorouracil_in.453.aspx


Résultats cliniques et facteurs pronostiques dans la kératite à Acanthamibe
But : Rapporter les résultats cliniques et les facteurs de pronostic pour les résultats visuels et morphologiques chez les patients atteints de kératite à Acanthamibe (KA).
Méthodes : Étude monocentrique, rétrospective et longitudinale de 51 cas de KA diagnostiqués par réaction en chaîne de la polymérase en temps réel (RT-PCR) entre mars 2010 et octobre 2022. Le résultat principal était la meilleure acuité visuelle corrigée (BCVA) finale. Un mauvais résultat visuel a été défini comme une BCVA finale ≥ 1 unité logMAR, tandis qu’un bon résultat visuel a été défini comme une BCVA finale < 1 unité logMAR. Les yeux de ces deux groupes ont été comparés en ce qui concerne les variables démographiques et cliniques initiales, le traitement anti-Acanthamibe utilisé et les complications de la maladie. Le diagnostic précoce a été défini comme ≤ 14 jours entre l’apparition des symptômes et la confirmation du diagnostic et le début du traitement médical par Acanthamibe. Une régression logistique multivariable a été utilisée pour déterminer les facteurs prédictifs d’un mauvais résultat visuel.
Résultats : Au total, 51 yeux de 46 patients diagnostiqués avec une KA, tous porteurs de lentilles de contact, ont été inclus dans cette étude. Le suivi moyen était de 39,0 ± 30,2 [intervalle total 14-120] mois. Trente et un yeux (60,8 %) ont présenté un bon résultat visuel, avec un âge de départ plus bas (30,5 ± 9,0 c. 42,3 ± 15,8; p = 0,020), une meilleure BCVA initiale (0,8 ± 0,7 unités logMAR c. 1. 3 ± 0,9 unités logMAR; p = 0,047), un taux plus élevé de diagnostic précoce (45,2 % c. 5,6 %; p = 0,004), et un taux plus élevé de débridement épithélial thérapeutique (64,5 % c. 10 %; p < 0,001). 20 yeux (39,2 %) ont présenté un mauvais résultat visuel, 12 yeux ayant subi une éviscération/énucléation (23,5 %). Ces 20 yeux présentaient un taux de complications plus élevé (90 % contre 61,3 %; p = 0,031). En analyse multivariable, le diagnostic précoce de la KA (OR 19,78; IC 95 % 2,07-189,11; p = 0,010) et le débridement épithélial thérapeutique (OR 19,02; IC 95 % 3,27-110,57; p = 0,001) ont été associés à un bon résultat visuel.
Conclusions : Dans la présente étude, un mauvais résultat visuel était présent dans 39 % des yeux affectés. Un diagnostic précoce de la KA (≤14 jours après l’apparition des symptômes) et un débridement épithélial thérapeutique ont été associés à un bon résultat visuel final.
Source : Vilares-Morgado R, Ferreira AM, Marques-Couto P, Madeira C, Moreira R, Torrão L, Neves-Cardoso P, Cunha AM, Rebelo S, Pinheiro-Costa J. Clinical outcomes and prognostic factors in Acanthamoeba keratitis. Cont Lens Anterior Eye. 2024 Jan 13:102119. doi: 10.1016/j.clae.2023.102119. Epub ahead of print. PMID : 38 220 498.

La choriorétinopathie centrale séreuse complexe est plus fréquente chez les hommes
La choriorétinopathie centrale séreuse complexe est plus susceptible de se développer et de récidiver chez les hommes que chez les femmes.
Les hommes sont plus susceptibles d’avoir une choriorétinopathie séreuse centrale complexe (CSCR) et une récurrence que les femmes, selon une recherche sur un système de classification basé sur l’imagerie multimodale, analysée dans le journal londonien Eye.
Les chercheurs ont analysé 109 yeux de 58 patients adultes (55 yeux, 28 femmes [âge moyen, 40,3 ± 10,2 ans; 54 yeux, 30 hommes [âge moyen, 47,3 ± 10,3 ans]) qui ont eu une CSCR, ont subi une imagerie multimodale et ont eu au moins 3 ans de suivi.
Les CSCR « simples » impliquaient des altérations de l’épithélium pigmentaire rétinien (EPR) ne dépassant pas 2 zones discales. Les patients atteints de choriorétinopathie séreuse centrale « complexe » présentaient davantage de zones discales ou des altérations multifocales de l’EPR.
Les femmes présentaient des symptômes depuis plus longtemps (médiane de 6 mois contre médiane de 2 mois). Huit femmes et un homme avaient pris des stéroïdes.
Les hommes étaient plus susceptibles d’avoir un CSCR complexe (85,2 % des cas chez les hommes et 61,8 % des cas chez les femmes). Un homme sur 10 avait au moins un œil atteint de CSCR complexe, tandis qu’un peu plus de 3 femmes sur 4 avaient au moins un œil atteint de CSCR complexe. La récidive était plus fréquente chez les hommes (P = 0,03).
Les femmes avaient une acuité visuelle de base plus faible (VA 0,27 ± 0,35 logMAR) que les hommes (0,13 ± 0,18 logMAR). Les groupes avaient une acuité visuelle finale corrigée (BCVA) similaire.
Environ 7 yeux sur 10 chez les hommes et environ 65 % chez les femmes ont nécessité un traitement. L’analyse de régression multivariable a indiqué que l’utilisation antérieure de stéroïdes, une bonne acuité visuelle de base et une CSCR simple étaient liées à un besoin moindre de traitement renforcé et à une BCVA finale plus élevée. Les adultes plus âgés étaient plus susceptibles d’avoir une AV finale réduite. Le sexe n’était pas associé au traitement ou à l’AV finale.
« La classification basée sur l’imagerie multimodale récemment validée fournit un système permettant de catégoriser la maladie en fonction de sa gravité et de son pronostic », notent les auteurs de l’étude.
« Comme cette classification basée sur l’imagerie multimodale s’est avérée reproductible, il est pertinent de comprendre les associations spécifiques au sexe à l’aide de ce nouveau système. Dans cette étude, nous avons donc comblé cette lacune en caractérisant les yeux sur la base de la nouvelle classification multimodale du CSCR et en analysant les changements à long terme chez les patients masculins et féminins ».
Les auteurs de l’étude signalent qu’il est possible que le facteur de la prise de stéroïdes ait suivi une « bonne réponse » après un simple arrêt des stéroïdes.
Les limites de l’étude comprennent l’absence d’analyse des paramètres quantitatifs et l’exclusion possible des yeux présentant une maladie très légère ou très grave en raison de la durée du suivi.
Source : Sahoo NK, Ong J, Selvam A, et al. Gender differences in central serous chorioretinopathy based on the new multimodal imaging classification. Eye. Published online November 4, 2023. doi:10.1038/s41433-023-02812-5

Étude
registre EUROLIGHT pour évaluer la photobiomodulation dans la DMLA sèche
LumiThera a annoncé que l’étude EUROLIGHT évaluera la sécurité, l’efficacité et les biomarqueurs du traitement par photobiomodulation de la dégénérescence maculaire liée à l’âge.
« La série d’essais LIGHTSITE a démontré des améliorations des bénéfices visuels avec les traitements PBM dans un essai clinique prospectif randomisé (ECR), a déclaré René Rückert, MD, MBA, directeur médical de LumiThera, dans un communiqué de presse. Les résultats de l’essai clinique randomisé ont démontré des avantages cliniques chez les patients en phase précoce ou intermédiaire jusqu’à 2 ans, avec des preuves anatomiques du ralentissement de la progression de la DMLA.
L’étude EUROLIGHT évaluera la sécurité, l’efficacité et les biomarqueurs du traitement par photobiomodulation de la dégénérescence maculaire sèche liée à l’âge.
L’étude clinique multicentrique portera sur 500 à 1 000 patients traités au cours des trois dernières années par photobiomodulation (PBM) à l’aide du système d’administration de la lumière de Valeda. Dans un premier temps, l’étude se concentrera sur 20 centres européens, mais elle pourrait être étendue à d’autres pays où Valeda est approuvé.
Des données rétrospectives seront collectées tandis que les patients seront suivis de manière prospective. L’objectif est de collecter des données sur le traitement pour justifier le remboursement ainsi que des informations sur l’utilisation de Valeda dans le monde réel.
« La capacité de recueillir des données supplémentaires sur l’innocuité et l’efficacité de nos expériences mondiales nous aidera à poursuivre l’étude de l’innocuité et de l’efficacité de la PBM dans le traitement de la DMLA sèche aux stades précoces et avancés de la maladie, ainsi que de son effet sur la progression de la maladie et la croissance des taux de lésions [d’atrophie géographique] au moyen d’une analyse anatomique détaillée par TCO dans plusieurs sous-ensembles de patients », a déclaré Clark Tedford, Ph. D., président et chef de la direction de LumiThera, dans le communiqué de presse.
LumiThera annonce le lancement de l’étude EUROLIGHT visant à évaluer les avantages à long terme du traitement par photobiomodulation (PBM) à l’aide du système de diffusion de la lumière Valeda® chez les patients atteints de dégénérescence maculaire sèche liée à l’âge (DMLA).
LumiThera inc. est une société de dispositifs médicaux qui propose un traitement par photobiomodulation (PBM) des lésions et des maladies oculaires. Elle a annoncé aujourd’hui le lancement de l’essai PBM le plus important jamais réalisé sur des patients atteints de dégénérescence maculaire liée à l’âge (DMLA) sèche. Un registre mondial de collecte de données de patients traités par PBM à l’aide du Valeda® Light Delivery System (Valeda) a été établi avec Dendrite Clinical Systems Ltée, une société basée au Royaume-Uni et spécialisée dans les études de registre. L’étude de registre clinique multicentrique portera sur 500 à 1 000 patients traités par PBM au cours des trois dernières années. L’étude comprendra initialement jusqu’à 20 centres européens et pourrait être étendue à d’autres pays en dehors de l’Union européenne (UE) où Valeda est approuvé.
EUROLIGHT (European Union Registry Study) recueillera des données sur la sécurité et l’efficacité clinique, telles que la meilleure acuité visuelle corrigée (BCVA) et les données d’imagerie par tomographie par cohérence optique (TCO), auprès de plusieurs centres qui traitent des sujets atteints de DMLA sèche dans le cadre de leur pratique. Le grand registre recueillera des données rétrospectives, les centres fournissant des données existantes sur les sujets ayant subi un traitement par PBM tous les 4 à 6 mois pendant une période pouvant aller jusqu’à trois ans. Les patients continueront à être suivis de manière prospective. Les données seront utilisées pour justifier le remboursement dans plusieurs pays et fourniront des informations cliniques importantes sur l’utilisation de Valeda dans le monde réel. L’étude a ciblé des centres européens sélectionnés ayant une grande expertise dans l’utilisation de Valeda.
La collection de registres actuelle examinera les patients du stade précoce au stade avancé de la DMLA et fournira des preuves de la sécurité, de l’efficacité clinique et des biomarqueurs à partir des données d’imagerie. On estime à 16 000 le nombre de patients traités à ce jour en Europe et en Amérique latine, ce qui représente un ensemble de données précieuses pour obtenir de plus amples informations sur le traitement par PBM et la progression de la DMLA.
« Nous sommes très heureux que le Duke Reading Center ait été choisi comme centre de lecture d’images indépendant pour examiner les données issues de l’utilisation de Valeda dans le monde réel », a déclaré Glenn Jaffe, MD, professeur d'ophtalmologie Robert Machemer, Duke University et directeur du Duke Reading Center.
Le traitement par PBM a montré un ralentissement statistiquement significatif de la progression de la maladie chez les patients atteints de DMLA sèche précoce ou intermédiaire pendant une période allant jusqu’à deux ans dans le cadre de l’étude LIGHTSITE III. L’étude de registre mondial nous fournira un ensemble de données unique pour évaluer les biomarqueurs et la progression de la maladie, y compris le dépôt de drusen et la formation de nouvelles atrophies géographiques (AG) ainsi que les taux de croissance des lésions.
« Nous sommes ravis de participer à l’étude EUROLIGHT », a déclaré Oygunn Uthiem, MD, Ph. D., Norwegian Dry Eye Clinic/Øyehelseklinikken, Department of Medical Biochemistry/Department of Ophthalmology, Oslo University Hospital. « Nous avons traité plus de 350 patients au cours des quatre dernières années et avons constaté les avantages réels des traitements de Valeda chez nos patients. Nous avons commencé à télécharger des données dans la base de données du registre et avons obtenu plus de 70 consentements éclairés de la part de patients souhaitant participer à l’étude. Nos patients ont suivi strictement les protocoles de l’essai clinique et ont été testés tous les 4 à 6 mois, certains pendant quatre ans. ».
« Nous avons vu des publications récentes dans le monde réel qui reflètent les résultats de notre essai clinique et nous avons plusieurs années d’expérience avec les traitements de Valeda dans l’UE et le LATAM », a déclaré Clark Tedford, Ph. D., président et PDG de LumiThera. « La possibilité de recueillir des données supplémentaires sur l’innocuité et l’efficacité à partir de nos expériences mondiales nous aidera à poursuivre l’étude de l’innocuité et de l’efficacité de la PBM dans le traitement de la DMLA sèche aux stades précoces et avancés de la maladie, ainsi que de son effet sur la progression de la maladie et la croissance des taux de lésions de l’AG à l’aide d’une analyse anatomique détaillée par TCO dans plusieurs sous-ensembles de patients ».
Source : https://www.businesswire.com/news/home/20240116921449/en/ LumiThera-Announces-Initiation-of-EUROLIGHT-Registry-Study-toEvaluate-Long-term-Benefits-of-Photobiomodulation-PBM-Treatmentusing-the-Valeda%C2%AE-Light-Delivery-System-in-Patients-with-DryAge-Related-Macular-Degeneration-AMD

La thérapie cellulaire de la télangiectasie maculaire répond aux critères d’évaluation primaires dans les essais de phase 3
Le NT-501, une thérapie cellulaire encapsulée pour le traitement de la télangiectasie maculaire de type 2, a atteint ses critères d’évaluation primaires dans deux essais de phase 3, selon un conférencier à Retina 2024.
« Le traitement par NT-501 c. sham a préservé les photorécepteurs chez les patients atteints de MacTel 2, satisfaisant ainsi au critère d’évaluation primaire », a déclaré Jiong Yan, MD.
Les essais NTMT-03-A et NTMT-03-B ont randomisé les patients 1:1 entre le traitement par NT-501 (revakinagene taroretcel, Neurotech Pharmaceuticals) et le traitement fictif pour étudier l’efficacité et l’innocuité de la thérapie cellulaire. Les essais ont porté sur 115 et 113 patients, respectivement. Les critères d’inclusion comprenaient une rupture de la zone ellipsoïde (ZE) entre 0,16 mm2 et 2,00 mm2 et une acuité visuelle corrigée supérieure ou égale à 54 lettres EDTRS – un équivalent Snellen de 20/80 ou mieux. Seuls les patients âgés de plus de 21 ans et de moins de 80 ans ont été inclus.
La thérapie cellulaire est implantée dans l’œil et ancrée à la sclérotique, où elle est conçue pour protéger les cellules photoréceptrices avec des niveaux soutenus à long terme de facteur neurotrophique ciliaire (CNTF).
Le critère d’évaluation principal des deux essais était le taux de changement de la zone de perte de la ZE entre le début de l’essai et le 24e mois. Dans une analyse post-hoc, les patients présentant une préservation de la ZE de plus de 20 % par rapport à l’étude sham ont été classés comme répondeurs, tandis que ceux présentant une préservation de plus de 50 % par rapport à l’étude sham ont été classés comme grands répondeurs. Les patients traités avec le NT-501 avaient significativement plus de chances d’obtenir le statut de répondeur ou de haut répondeur.
« Les facteurs associés à une plus grande probabilité d’obtenir le statut de répondeur avec le NT-501 par rapport au sham comprenaient une perte de surface de la ZE de base plus faible, un âge plus jeune et une absence d’atteinte fovéale », a déclaré M. Yan.
Les patients du groupe NTMT-03-A présentaient une perte médiane de ZE inférieure à celle du groupe B au départ.
Selon Yan, le groupe NTMT-03-A a enregistré une réduction de 55 % de la perte de surface de la ZE jusqu’à deux ans après le traitement, tandis que le groupe NTMT-03-B a enregistré une réduction de 31 % après le traitement pendant la même période. Le NT-501 a été bien toléré, la plupart des effets indésirables du traitement oculaire, y compris le retard de l’adaptation à l’obscurité et le myosis, ayant été considérés comme légers ou transitoires.
« Les quelques cas d’événements graves liés au traitement oculaire étaient liés à la chirurgie et ont été résolus avec des stéroïdes topiques », a déclaré Yan.
« Le traitement de la télangiectasie maculaire au début de la progression de la maladie peut augmenter la probabilité d’obtenir une réduction plus importante de la progression de la maladie », a-t-elle déclaré.
Source : Yan J. Baseline characteristics associated with treatment response across phase 3 studies of ciliary neurotrophic factor — Producing Revakinagene Taroretcel (NT-501) in people with Macular Telangiectasia Type 2. Presented at: Retina 2024; Jan. 13-19, 2024; Wailea, Hawaii.

De nouvelles données à 6 mois évaluent l’AZR-MD-001 pour le trouble des glandes de Meibomius
De nouvelles données cliniques présentées lors de la réunion annuelle de l’American Academy of Optometry (AAO) ont permis de faire le point sur l’essai de phase 2 d’Azura Ophthalmics Ltée évaluant l’AZR-MD-001 pour le traitement du dysfonctionnement des glandes de Meibomius (MGD).
L’AZR-MD-001 est une pommade ophtalmique à base de sulfure de sélénium conçue pour être appliquée directement sur la surface de la paupière inférieure comme traitement potentiel du dysfonctionnement des glandes de Meibomius.
Selon Azura, la formulation est destinée à cibler la pathophysiologie primaire de la production anormale de kératine et de l’obstruction, de la mauvaise qualité du meibum et des signes et symptômes oculaires qui en résultent :
Ralentir le taux de prolifération des kératinocytes et la production de kératine (en ralentissant la formation et l’obstruction du bouchon de la glande de Meibomius);
Ramollir les agrégats de kératine en brisant les liaisons disulfures, en ouvrant les obstructions et en améliorant la qualité du meibum et son écoulement dans les glandes de Meibomius;
Stimuler la lipogenèse pour augmenter la quantité de lipides produits par les glandes de Meibum;
Tue les acariens et les bactéries sur les follicules des cils.
L’étude multicentrique randomisée, en double aveugle, contrôlée par véhicule, en groupes parallèles (NCT03652051) a été menée auprès de 245 patients (âgés de plus de 18 ans) chez qui l’on avait diagnostiqué une mgD et une sécheresse oculaire par évaporation (DED).
Les patients ont été recrutés sur la base des critères suivants au moment de la sélection et au début de l’étude, dans 29 sites en Australie, en Nouvelle-Zélande et au Canada :
Meilleure acuité visuelle corrigée (BCVA) de 20/40 ou mieux;
Observation d’une obstruction des glandes de Meibomius;
Signes et symptômes de sécheresse oculaire signalés (au cours des 3 derniers mois).
Les patients ont été randomisés 1:1 pour recevoir l’une des deux doses d’AZR-MD-001 (0,5 % [n = 82] ou 1,0 % [n = 83]) ou le véhicule (n = 80) dans les deux yeux, appliquée deux fois par semaine immédiatement avant le sommeil sur les paupières inférieures.
À noter que tous les participants ont été stratifiés en fonction de la durée du diagnostic de mgD (< 5 ou ≥ 5 ans) et du score de sécrétion de la glande de Meibomius (MGS) (< 6, ou ≥ 6 et ≤ 12) au début de l’étude.
Publiées en août 2023, les données à 3 mois ont montré que l’AZR-MD-001 0,5 % a satisfait aux deux critères d’évaluation principaux, avec une amélioration significativement plus importante des scores de sécrétion liquide de la glande de Meibomius (MGYLS) entre le début de l’étude et le 3e mois, par rapport au véhicule.
De même, la dose de 0,5 % a entraîné une amélioration significativement plus importante du score total de l’indice des maladies de la surface oculaire (OSDI) entre le début de l’étude et le troisième mois, par rapport à l’excipient.
Dans l’ensemble, le traitement avec AZR-MD-001 0,5 % a démontré une augmentation moyenne des glandes ouvertes sécrétant du meibum ainsi qu’un plus grand soulagement des symptômes par rapport au véhicule.
Au troisième mois, les investigateurs ont noté que l’AZRMD-001 présentait un pourcentage plus élevé de patients avec une amélioration cliniquement significative de ≥ 5 glandes supplémentaires produisant du meibum par rapport à l’excipient :
MGYLS : 60 %, p < 0,0001 pour AZR MD 001 0,5 %;
MGLYS : 43 %, p = 0,0218 pour AZR MD 001 1,0 %;
MGLYS : 22 % pour le véhicule.
En outre, un nombre significativement plus élevé de patients ayant reçu l’AZR-MD-001, quel que soit le dosage, ont atteint un taux de meibum normal (MGS > 12) dès le 14e jour, selon les données lues :
AZR-MD-001 0,5 %
• 20 %, p = 0,0380
AZR-MD-001 1,0
• 19 %, p = 0,0949
Véhicule
• 7,6 %
Et au 6e mois ?
Au mois, les patients continuaient à présenter un meibum normal :
AZR-MD-001 0,5 %
• 74 %, p = 0,0017
AZR-MD-001 1,0 % O 63 %, P = 0,1273
• 63 %, p = 0,1273
Véhicule
• 48 %
Au mois 6, un nombre significativement plus élevé de patients traités par AZR-MD-001 (pour les deux dosages) étaient asymptomatiques pour la maladie (OSDI < 13) :
AZR-MD-001 0,5 %
• 48 %, p = 0,0333
AZR-MD-001 1,0 %
• 50 %, p = 0,0205
Véhicule
• 30 %
Ils ont conclu qu’une proportion statistiquement significative de patients traités par AZR-MD-001 présentait une réponse cliniquement significative, la normalisation de la fonction de leurs glandes de Meibomius et l’obtention d’un statut asymptomatique pour la maladie.
Source : American Academy of Optometry (AAOPT) annual meeting in New Orleans, Louisiana, October 11-14, 2023.
https://www.clinicaltrials.gov/study/NCT03652051 ClinicalTrials.gov ID NCT03652051
Étude multicentrique évaluant l’AZR-MD-001 chez des patients souffrant d’un dysfonctionnement des glandes de Meibomius et d’une sécheresse oculaire évaporative (DED)
Résumé : AZ201801 est une étude multicentrique de la pommade AZR-MD-001 et du véhicule AZR-MD-001 chez des patients souffrant de dysfonctionnement des glandes de Meibomius (MGD) et de sécheresse oculaire évaporative (DED).
Description détaillée : AZ201801 est une étude multicentrique, doublement masquée, contrôlée par véhicule, randomisée, en groupes parallèles, menée dans 2 cohortes se chevauchant séquentiellement, évaluant l’innocuité, l’efficacité et la tolérabilité de la pommade AZR-MD-001 et du véhicule AZR-MD-001 chez des patients atteints de dysfonctionnement des glandes de Meibomius (MGD) et de sécheresse oculaire par évaporation (DED).
Titre officiel
Étude multicentrique randomisée et contrôlée par véhicule visant à évaluer l’innocuité, la tolérabilité, la pharmacocinétique systémique et la pharmacodynamique de l’AZR-MD-001 chez des patients atteints de dysfonctionnement des glandes de Meibomius et de sécheresse oculaire par évaporation.
Intervention / Traitement
– Médicament : AZR-MD-001 à faible dose
– Médicament : AZR-MD-001 à dose moyenne
– Médicament : AZR-MD-001 à dose élevée
– Médicament : Véhicule AZR-MD-001

Mesure des résultats
3 mois
Glande de Meibum sécrétion de la glande de Meibomius (MGS)
Changement par rapport à la ligne de base du mgS. Le mgS peut varier de 0 (très anormal) à 45 (normal).
Glandes de Meibomius produisant une sécrétion liquide (MGYLS)
Changement par rapport à la ligne de base dans le mgYLS. Le mgYLS peut varier de 0 (anormal) à 15 (normal).
Korb et Blackie ont mesuré l’expressivité des glandes simples ou multiples ou des mgS pendant l’application d’une force standardisée. Pour les glandes multiples, la force standard est appliquée pendant 10 à 15 secondes à l’aide d’un instrument spécialement conçu à cet effet1
Korb et Blackie1 enregistrent le nombre de glandes dans une zone de 15, qui produisent une sécrétion liquide après une expression standardisée (score 0-45). La qualité du meibum est évaluée dans chacune des 15 glandes du tiers central de la paupière inférieure sur une échelle de 0 à 3 pour chaque glande : 0 = meibum clair; 1 = meibum trouble; 2 = trouble avec débris (granuleux); 3 = épais, comme du dentifrice.
Le mgYLS mesure le nombre de glandes sécrétant du liquide en observant 15 glandes de la paupière inférieure, après un diagnostic d’expressivité, pour déterminer si elles sécrètent du liquide (résultat binaire); le score est compris entre 0 et 15, les scores les plus élevés étant les meilleurs2 L’expressivité du meibum est évaluée à partir de 5 glandes : 0 = toutes les glandes sont exprimables; 1 = 3-4 glandes sont exprimables; 2 = 1-2 glandes sont exprimables; 3 = aucune glande n’est exprimable. Elle peut être évaluée au niveau de la paupière inférieure ou supérieure.
1 Korb DR, Blackie CA. Meibomian gland diagnostic expressibility: correlation with dry eye symptoms and gland location. Cornea. 2008;27(10):1142–1147.
2 Tomlinson A, et al. Invest Ophthalmol Vis Sci. 2011;52 (4):2006-49.

Les instruments à lumière rouge pour la myopie dépassent les limites de sécurité
Objectif : La thérapie par lumière rouge de faible intensité (LLRL) s’est récemment imposée comme traitement de la myopie chez les enfants, plusieurs études faisant état d’une réduction significative de l’allongement axial et de la progression de la myopie. L’objectif de cette étude était de caractériser la sortie et de déterminer l’exposition maximale admissible (EMA) thermique et photochimique des appareils LLRL pour le contrôle de la myopie.
Méthodes : Deux dispositifs LLRL, un Sky-n1201a et un Future Vision, ont été examinés. Les mesures de puissance optique ont été effectuées à l’aide d’un radiomètre à sphère intégrante à travers une ouverture de 7 mm de diamètre, conformément à la norme ansI Z136.1-2014, sections 3.2.33.2.4. Les tailles des taches rétiniennes des dispositifs ont été obtenues à l’aide d’un œil modèle et d’un profileur de faisceau à haute résolution. L’irradiance cornéenne, l’irradiance rétinienne et l’EMA ont été calculées pour un œil positionné au niveau des oculaires de chaque dispositif.
Résultats : Il a été confirmé que les deux appareils étaient des produits laser de classe 1. Les résultats ont montré que le Sky-n1201a émet une lumière laser en tant que source ponctuelle avec une longueur d’onde de 654 nm, une puissance de 0,2 mW (ouverture de Ø 7 mm, distance de 10 cm), une irradiance cornéenne de 1,17 mW/cm2 et une irradiance rétinienne de 7,2 W/cm2 (pupille de Ø 2 mm). L’EMA pour les lésions photochimiques est de 0,55 à 7,0 s pour les pupilles de 2 à 7 mm et pour les lésions thermiques de 0,41 à 10 s pour les pupilles de 4,25 à 7 mm. Future Vision délivre le laser sous la forme d’une source étendue de 0,75 × 0,325°. Il a une longueur d’onde de 652 nm, une puissance de 0,06 mW (ouverture de Ø 7 mm, distance de 10 cm), une irradiation cornéenne de 0,624 mW/cm2 et une irradiation rétinienne de 0,08 W/cm2 (pupille de Ø 2 mm). L’EMA pour les dommages photochimiques est de 50 à 625 s pour les pupilles de 2 à 7 mm.
Discussion : Pour les deux dispositifs LLRL évalués ici, 3 minutes d’observation continue approchent ou dépassent l’EMA, exposant la rétine au risque de dommages photochimiques et thermiques. Les cliniciens doivent être prudents avec l’utilisation de la thérapie LLRL pour la myopie chez les enfants jusqu’à ce que les normes de sécurité puissent être confirmées.
Source : https://onlinelibrary.wiley.com/doi/10.1111/opo.13272

La lumière artificielle extérieure nocturne peut augmenter le risque de dégénérescence maculaire liée à l’âge
Une nouvelle étude cas-témoins a révélé que les personnes âgées de 70 ans et plus vivant dans les zones urbaines de Corée du Sud présentaient un risque significativement plus élevé de développer une dégénérescence maculaire exsudative liée à l’âge.
Les résultats d’une récente étude cas-témoins menée en Corée du Sud indiquent que l’exposition à la lumière artificielle extérieure pendant la nuit, appelée OALAN par les auteurs, peut augmenter le risque de dégénérescence maculaire liée à l’âge (DMLA).
Dirigée par le docteur Ahnul Ha, du département d’ophtalmologie de la faculté de médecine de l’université nationale de Jeju, l’équipe de chercheurs a constaté que les personnes vivant dans des zones urbaines étaient plus susceptibles de développer une DMLA exsudative, les hommes âgés de 70 ans ou plus vivant dans ces zones présentant le risque apparemment le plus élevé1

Les chercheurs ont cité les troubles du sommeil, l’obésité, les maladies cardiovasculaires, les cancers et les troubles mentaux parmi les effets négatifs potentiels de la pollution lumineuse sur la santé. « La pollution lumineuse est l’un des risques environnementaux les plus répandus, mais souvent négligés, résultant de l’activité humaine. Elle se caractérise par la perturbation de l’environnement nocturne due à la lumière émise par des sources anthropogéniques, et ses effets négatifs sur la santé humaine sont récemment devenus une préoccupation urgente », notent les auteurs. Ha et son équipe soulignent que la lumière artificielle nocturne est largement reconnue comme ayant un impact néfaste sur la rétine et le nerf optique, y compris des dommages potentiels directs et indirects sur le tissu oculaire.
Les données utilisées pour l’étude proviennent de la base de données du Service national coréen d’assurance maladie, qui assure 99,8 % de la population sud-coréenne, de 2008 à 2020. Les personnes âgées de 50 ans et plus chez qui un diagnostic d’EAMD a été posé entre début 2010 et 2011 ont été incluses dans l’étude afin de tenir compte de l’âge typique d’apparition de la maladie. Sur plus de 126 000 participants, environ 4 100 avaient reçu un diagnostic de DMLA.
Les participants vivant dans des zones urbaines représentaient 60 % de l’étude, où les niveaux moyens de lumière artificielle extérieure pendant la nuit étaient trois fois plus élevés que dans les zones rurales. « Ces différences régionales suggèrent la présence d’un seuil potentiel au-delà duquel les niveaux d’OALAN peuvent augmenter le risque d’EAMD, écrivent les chercheurs. Les niveaux d’OALAN dans les zones rurales peuvent ne pas avoir dépassé le seuil associé à un risque accru. En outre, l’impact potentiel de facteurs spécifiques à la région ne peut pas être entièrement exclu ». Les chercheurs ont également noté que les différences de mode de vie entre les zones urbaines et rurales peuvent également avoir eu un impact sur les résultats de l’étude.
La principale source de données OALAN utilisée est le système Operational Linescan du Defense Meteorological Satellite Program de l’armée de l’air américaine. La saturation des données est ensuite corrigée par le National Geophysical Data Center « en fusionnant les niveaux d’image à gain fixe faible, moyen et élevé et en publiant des ensembles de données globales de lumière nocturne calibrée en fonction de la radiance ».
Pour évaluer l’OALAN en unités de radiance (nanowatts par centimètre carré et par stéradian), les chercheurs ont accédé à des adresses géocodées grâce aux dernières données de luminosité nocturne calibrées en fonction de la radiance du National Geophysical Data Center (Centre national de données géophysiques). « Ces données ont été proposées comme une mesure indirecte fiable des niveaux relatifs d’illumination nocturne au niveau du sol et ont été utilisées récemment pour évaluer les effets de la pollution lumineuse sur diverses comorbidités », ont déclaré les auteurs.
Les chercheurs ont exclu de l’étude plus de 23 500 participants souffrant de dépression et de troubles du sommeil afin de mieux évaluer l’association entre l’OALAN et le risque d’EAMD, qui s’est avérée inchangée. Étant donné les nombreux autres facteurs qui pourraient être en jeu, Ha et son équipe suggèrent de mener des études plus approfondies sur l’exposition, les comportements adaptatifs individuels et les médiateurs potentiels.
Source : Kim SH; Kim YK, Shin YI, et coll. Nighttime outdoor artificial light and risk of age-related macular degeneration. JAMA Netw Open. 2024;7(1):e2351650. doi:10.1001/jamanetworkopen.2023.51650

Qui dit printemps dit pluies abondantes… et parfois dommages causés à votre résidence par l’eau. Sauf si vous posez certains gestes qui la protégeront.

1. Nettoyez vos gouttières et descentes pluviales :
Débarrassez-les des feuilles, branches ou débris pouvant obstruer le flux d’eau. Cela permettra d’éviter les débordements et les dommages aux fondations. Les tuyaux de descentes pluviales doivent rejeter l’eau à au moins deux mètres des fondations de la maison, puis l’envoyer vers l’extérieur de votre terrain. Sinon, installez un tonneau qui récoltera l’eau pour le jardin.
2. Créez des pentes positives :
De bonnes pentes canalisent et éloignent de la maison l’eau provenant de la fonte des neiges. Vous réduirez ainsi les risques d’infiltration et de sinistres.
3. Vérifiez et imperméabilisez vos fondations :
L’eau s’infiltre dans des craques et trous minuscules. Il est donc impératif de les repérer et de les calfeutrer. Pour les grandes fissures, utilisez un ciment hydraulique. Celui-ci développe de la résistance en présence d’humidité. Quant à la membrane imperméable, elle protégera vos fondations des effritements prématurés et étirera la vie du béton.
4. Inspectez votre toiture :
Votre toit représente la partie de votre résidence qui subit le plus de dégradation en raison des intempéries. Avant la saison des pluies, vérifiez l’état des joints et du bardeau, et assurez-vous de réparer les fissures qui favoriseraient l’infiltration d’eau.
5. Installez une pompe de puisard :
Voilà une excellente manière de protéger votre maison et ses fondations, car la pompe évacuera vers l’extérieur l’eau qui entrerait dans la résidence. Munissez-vous aussi d’une pompe de rechange alimentée par une batterie ou une génératrice pour vous prémunir en cas de panne de courant.
6. Éloignez les plates-bandes :
Parce que les végétaux ont besoin d’eau et qu’ils l’attirent, n’installez pas de plates-bandes près des fondations. En plus, lors des pluies abondantes, les plantes n’absorbent pas toujours assez vite la quantité d’eau accumulée. Conséquence, l’humidité risque d’endommager les fondations et de s’infiltrer chez vous. Il en est de même pour les arbres. Attirées par l’eau proche des fondations, leurs racines pourraient abîmer ou même bloquer votre système de drainage.
Le saviez-vous ?
Les dommages par l’eau sont les risques les plus courants en assurance habitation et représentent près de la moitié des réclamations enregistrées. Parlez-en à votre courtier et assurez-vous d’avoir les garanties nécessaires pour protéger votre maison.

Dernièrement, vous ressentez une sensation d’épuisement, de lassitude ou de somnolence… vous pourriez dormir partout, à tout moment… bref, vous êtes fatigué !

Eh bien, vous n’êtes pas seul. Il semblerait que plus de 30 % des consultations médicales soient en lien avec la fatigue. Les conséquences de la fatigue peuvent toucher les capacités mentales et physiques et pourraient vous placer à risque de blessure ou baisse d’efficacité au travail.
Qu’est-ce qui cause votre fatigue ?
Une combinaison de différentes sources est possible.
un manque de sommeil
une activité mentale ou physique intense prolongée
de longues périodes de stress ou d’angoisse
une surcharge de travail prolongée
un aménagement non adéquat d’un poste de travail
une mauvaise planification du travail et/ou des activités personnelles
un effet secondaire d’une médication
le manque d’activité physique, etc.
Si vous ressentez un ou plusieurs de ces symptômes pour une durée prolongée, il serait important d’en parler à un médecin.
Maux de tête
Perte d’appétit
Baisse de concentration
Quelques chiffres…
Perte de mémoire
Démotivation
Somnolence
17 heures sans sommeil équivalent à un taux d’alcoolémie de 0,05
21 heures sans sommeil équivalent à un taux d’alcoolémie de 0,08
(limite légale au Canada)
de 24 à 25 heures sans sommeil équivalent à un taux d’alcoolémie de 0,10
Les saines habitudes de vie, des alliées importantes pour réduire la fatigue.
Se lever et se mettre au lit à la même heure tous les jours
Utiliser son lit pour dormir seulement (ne pas écouter la télévision, utiliser des appareils électroniques, lire, travailler, etc.)
Avoir un éclairage plus sombre dans la chambre à coucher et une température plus fraiche
Faire de l’exercice un peu tous les jours
Avoir une alimentation équilibrée Éviter la caféine, le tabac ou l’alcool avant d’aller au lit
Le saviez-vous ?
Certains modules de votre programme d’assurance collective prévoient le remboursement des prestations de professionnels tels que les physiothérapeutes, les massothérapeutes, les acupuncteurs ou encore les psychologues, auxquels vous pourriez avoir recours en cas de fatigue ou surmenage. Assurez-vous d’avoir choisi le module d’assurance collective qui correspond le mieux à vos besoins, ou parlez-en à votre conseiller chez Lussier pour évaluer les options d’assurance individuelle disponibles.
Sources : CCHST : https://www.cchst.ca/oshanswers/psychosocial/ fatigue.html#section-1-hdr
SAAQ : https://saaq.gouv.qc.ca/fileadmin/documents/ publications/guide-gestion-fatigue-conducteursindustrie-transport-routier.pdf
Dormez là-dessus : www.dormezladessuscanada.ca

Assurance responsabilité professionnelle
Assurance clinique d’optométrie
Assurance des particuliers
Assurance collective
Appelez-nous pour une soumission dès aujourd’hui !
Cabinet de services financiers 1 877 543-2960
Lussier.co/AOQ

Rabais de groupe disponibles

514 686-2081
Les taux d’inoccupation sont en chute libre au pays depuis bientôt une décennie si l’on fait abstraction des deux années de pandémie. Notre capacité à construire des logements locatifs semble bien en deçà de la demande pour ce type d’habitation, et aucune région n’échappe à ce phénomène. Pour l’ensemble du pays, en début de 2024, il n’en coûte pas moins de 1 359 $ par mois pour un loyer de deux chambres à coucher, selon le plus récent rapport de la Société canadienne d’hypothèque et de logement (SCHL). C’est une hausse annuelle de 8 %, soit une progression nettement plus rapide que l’inflation. Cette moyenne cache une réalité de plus en plus préoccupante : les hausses de loyers sont encore plus salées pour les « nouveaux » locataires. La roue qui assurait le bon fonctionnement du marché du logement locatif semble s’être brisée. Que s’est-il passé ?

Au Québec, l’année 2023 est une annus horribilis pour ce qui concerne la construction résidentielle. Sont sorties de terre moins de 30 000 unités de logement, toutes catégories confondues, alors que la capacité productive tourne généralement autour de 60 000 unités. La récente hausse des taux d’intérêt n’est certainement pas étrangère à ce fort ralentissement, mais la hausse des coûts de construction observée au cours de la période de reprise postpandémique aura aussi joué un rôle décisif. La hausse des coûts aura dépassé les 20 % annuellement (graphique 1), et bien que la fluidité des chaînes d’approvisionnement du secteur se soit normalisée depuis et que la pression soit retombée, le mal est fait. L’ardeur des entrepreneurs en construction est passablement refroidie, les coûts de construction demeurant élevés en regard des revenus.
Les nouvelles ne sont pas particulièrement bonnes non plus du côté de la main-d’œuvre qualifiée. Le taux de postes vacants est particulièrement élevé dans le secteur de la construction, et ce, malgré le ralentissement de l’activité. Au bas mot, il y avait en fin d’année dernière plus de 65 000 postes à combler à l’échelle du pays, dont 10 000 au Québec seulement. De plus, le secteur ne bénéficie pas de l’apport de sang neuf fourni par l’immigration, qu’elle soit permanente ou temporaire. Les données démontrent que les migrants sont en effet sous-représentés, alors qu’ils ne comptent que pour 9 % des travailleurs de l’industrie. Une bonne part du problème de pénurie de maind’œuvre dont souffre la construction au Québec pourrait probablement s’alléger si on s’attelait à embaucher davantage, et surtout, à mieux intégrer les immigrants.
Du côté de la demande de logement, les sources de pressions s’accentuent depuis quelques années déjà. D’abord, le marché du travail reste résilient malgré la pandémie et le ralentissement économique que nous vivons. Le chômage se maintient à des niveaux historiquement faibles et la croissance des salaires parvient, malgré tout, à soutenir le marché immobilier de propriété.
Après un certain relâchement des prix à Montréal et Québec l’an dernier, l’indice du prix des logements en propriété reprend, depuis plusieurs mois, sa tendance à la hausse. Les acheteurs potentiels se replient alors sur le marché locatif, démontrant à nouveau hors de tout doute les liens unissant ces deux marchés. La forte demande pour le logement locatif s’explique donc en partie par la faible abordabilité des habitations pour les propriétaires-occupants. Le phénomène est particulièrement probant chez les 15 à 24 ans qui ont profité de l’effervescence économique pour se tailler une position enviable sur le marché du travail, sans pour autant être en mesure d’accéder à la propriété. Certains iront jusqu’à dire qu’un problème d’équité intergénérationnelle se dessine actuellement au pays.
D’ordinaire circonscrites aux grands centres urbains, les pressions sur le secteur du logement se sont généralisées durant la pandémie, avec l’exode de nombreux travailleurs qui ont quitté les grands centres ou la banlieue pour aller vivre aux quatre coins du Québec. À titre d’exemple, les taux d’inoccupation à Trois-Rivières et à Drummondville étaient respectivement de 0,4 % et 0,5 % en 2023, alors que ce taux à Montréal oscillait autour de la moyenne nationale, déjà très faible, de 1,5 %. Pour mettre les choses en perspective, il y a un logement libre à Trois-Rivières pour chaque tranche de 250 logements répertoriés. Un marché à l’équilibre est réputé avoir une habitation disponible pour chaque tranche de 30 logements. Nous sommes loin du compte.


Côté immigration, les deux dernières années sortent complètement du lot. S’il est vrai que l’immigration permanente est en progression, c’est plutôt la hausse des résidents non permanents qui explique la forte progression de la population canadienne au cours des 24 derniers mois (graphique 2). Cette hausse, combinée au fait que les nouveaux immigrants ont une forte propension à louer, et que la nouvelle règle entrée en vigueur le 1er janvier 2023 empêche les étrangers non canadiens d’acquérir un bien immobilier pendant une période de 2 ans, est un des facteurs qui contribuent à la progression de la demande de logement locatif.

Les experts sont clairs, l’abordabilité a grandement diminué au pays.
Les loyers ont augmenté plus rapidement que le salaire moyen et les faibles taux d’inoccupation placent les ménages, particulièrement ceux à faible revenu, dans une situation difficile. Que faire ?
Conclusion
Le modèle économique est suffisamment limpide : lorsqu’il y a décalage entre l’offre et la demande et que les prix s’échappent vers le firmament, il faut trouver un moyen de rehausser l’offre… et de calmer les pressions de la demande. Finalement, contenir la demande sera difficile, voire impossible. Les besoins en main-d’œuvre de notre économie sont trop importants pour espérer atténuer la pression sur le marché du logement avec une mesure de réduction marquée de notre accueil immigrant.
Temps plein
Optiprix optiprixgranby.com
Contractuel 1 semaine ou + / année
Docteure Annie Dionne, optométriste
514 694-0836



Docteur Mario Duchemin, optométriste Madame Marie-Joëlle Papineau 450 777-4833 info@optiprixgranby.com
Horaire flexible. Clientèle établie, bureau en pleine expansion. Trois opticiennes d’ordonnances et un optométriste. Équipe stable. Ambiance de travail agréable et sans pression. Possibilité de prime à la signature d’un contrat et ou association. Situé près de l’autoroute 10.
Temps plein / partiel / permanent Lunetterie Optiprix optiprix.ca
Docteur Normand Houle, optométriste 819 820-8912 n.houle@optiprix.ca
Joignez-vous à notre équipe de 4 optométristes, 4 opticiennes d’ordonnances et 9 assistant(e)s certifié(e)s. Local très spacieux et lumineux avec 4 salles d’examens, OCT, OCTOPUS, caméra grand-champ (ZEISS). Ambiance familiale et équipe dynamique pour prendre soin de notre fidèle clientèle. Pour une pratique professionnelle variée (horaire rempli des mois à l’avance) et un milieu de vie des plus agréables. L’Estrie est un terrain de jeu pour les sportifs et les amants de la nature. Vous y trouverez de nombreux plans d’eau, des terrains de golf, un paradis pour les cyclistes ainsi qu’un relief montagneux pour le ski et des randonnées inoubliables. On vous attend !
Demandez Steffan steffandonnelly_ood@hotmail.com optiquedonnelly.com
Optique Donnelly est à la recherche d'optométristes pour accompagner ses équipes d'opticiens d’ordonnances à travers le Nunavik. Saisissez l'opportunité de découvrir les communautés du Grand Nord québécois. 14 villages de la Baie d'Hudson et d'Ungava vous attendent. Les voyages sont de 6 jours. Déplacements et hébergements pris en charge. Rémunération jusqu'à 2000 $ / jour de travail + perdiem. Expérience extraordinaire et dépaysement garanti.
Temps plein / partiel / permanent / temporaire
Optique Santé optiquesante.com
Docteure Ariane Roy, optométriste
Madame Christine Michaud 418 543-2020 ou 418 590-2021 info@optiquesante.com
Que cherchez-vous comme pratique d’optométrie ? La flexibilité, l’humanité, l’équilibre entre la vie professionnelle sociale et familiale, un environnement technologique, un personnel dévoué ? Optique Santé, clinique indépendante établie depuis 35 ans, vous offre 8 salles d’examen, la présence de 5 optométristes, 3 opticiens d’ordonnances, assistantes, OCT, caméras, Lipiview-Lipiflow et la possibilité de travailler selon vos disponibilités ou en téléoptométrie. Aucune fin de semaine. On vous attend pour vivre l’expérience de notre clinique située au cœur de la ville de Chicoutimi.
Temps partiel / remplacements ponctuels
Raymond et Côté, opticiens et optométristes mobiles visionrc.ca
Docteure Shelton Regismarianayagam, optométriste 514 946-1010 poste #3 cv@visionrc.ca
L’équipe de Raymond et Côté est à la recherche d’optométristes désireux de varier leur pratique à travers nos cliniques visuelles mobiles au service des aînés. Forts de nos 31 ans d’expertise en cliniques mobiles dans la région de Montréal, nos services s’installent dans la région de Québec. Nous offrons un environnement de travail atypique et très enrichissant auprès d’une clientèle ayant de grands besoins. Que ce soit pour des besoins ponctuels ou de façon plus régulière à temps partiel, nous serons enchantés de vous accueillir dans notre belle équipe déjà composée de 6 opticiens d’ordonnances et 7 optométristes. Au plaisir de vous rencontrer !
Temps plein, temps partiel, volant, permanent ou temporaire
IRIS, Le Groupe Visuel
Pour plus de détails, visitez : career.iris.ca/fr/optometristes
Docteure Jahel St-Jacques, optométriste 418 234-4510 jahel.st-jacques@iris.ca
La qualité des services aux patients vous tient à coeur ?
Vous recherchez un environnement de pratique favorisant la collaboration interprofessionnelle, une clientèle familiale et fidèle ainsi que de l’équipement de pointe ? IRIS a des opportunités partout au Québec : Rive-Sud de Montréal, Outaouais, Lanaudière, Trois-Rivières, Sherbrooke, Québec/Lévis, Bas-St-Laurent, Charlevoix, Sept-Iles, Saguenay-Lac-St-Jean, Abitibi-Témiscamingue ! Plusieurs postes d’optométristes volants et opportunités de partenariat sont disponibles ! En plus d’une remarquable qualité de pratique, plusieurs secteurs vous offriront une qualité de vie avantageuse et de nombreux attraits touristiques et activités de plein air.
Temps plein / partiel / permanent Clinique visuelle de Verchères optoplus.com
Docteure Johanne Roy, optométriste
450 583-6644 optojroy@yahoo.ca
Vous cherchez un environnement de travail agréable qui répond à vos besoins ? La clinique visuelle de Verchères, bien établie depuis 33 ans, est à la recherche d’un(e) optométriste motivé(e) pour se joindre à son équipe dynamique. En plus d’une clientèle fidèle et variée, la clinique est fermée la fin de semaine pour une conciliation travail-vie personnelle idéale. Vous aurez la chance de planifier votre horaire selon vos disponibilités et de développer la pratique que vous souhaitez. Venez pratiquer dans une clinique bien équipée (OCT, CV, laboratoire sur place) qui vous permettra de vous épanouir sur le plan professionnel ! Vous pouvez me rejoindre en toute confidentialité.
RIMOUSKI • ROUYN • ST-JÉRÔME
JOLIETTE • BELOEIL • ST-JEAN
GRANBY • ST-BRUNO ET DANS
Temps plein / permanent / temporaire / partiel Greiche & Scaff greiche-scaff.com
Docteur André Aoun, optométriste 514 207-9211 andre.aoun@greiche-scaff.com
Nous vous offrons des conditions exceptionnelles, une très grande flexibilité de pratique et un encadrement dynamique. Nos priorités sont vos besoins pour oeuvrer à la santé de vos patients. Parce qu’avant d’être nos clients, ils sont avant tout vos patients. Saisissez dès maintenant l’opportunité de faire partie de notre grande famille Greiche & Scaff. Notre promesse ? Votre tranquillité d’esprit. Discrétion assurée.
Temps plein
Centre Visuel des Eskers 819 732-6831
Docteure Andrée-Anne Roy, optométriste 819 354-6078
andree-anne.roy@hotmail.com
Docteure Caroline Coulombe, optométriste 819 856-3630 caroline.coulombe@lino.com
Le Centre Visuel des Eskers d’Amos recherche un(e) optométriste à temps plein avec possibilité de travailler 4 ou 5 jours par semaine. Notre clinique établie depuis plus de 75 ans, permet aux optométristes d’avoir une pratique de l’optométrie très variée, valorisante et enrichissante. Patients fidèles à leur optométriste, clientèle variée de tous âges, pathologies, lentilles cornéennes, lunetterie, équipements de pointe, collaboration avec les ophtalmologistes, assistantes certifiées et opticienne d’ordonnances. Nous avons des horaires flexibles et très remplis. Fermé les samedis et ouvert un seul soir par semaine. C’est l’opportunité de démarrer une merveilleuse carrière en région, loin des embouteillages, de profiter des grands espaces et de travailler près de la maison. De plus, notre clinique est entièrement rénovée ! Nous vous attendons !
Temps plein permanent
Clinique d’optométrie de Buckingham buckingham@opto-reseau.com
Docteure Christine Paquin, optométriste 819 213-5438 cpaquin@optobuck.ca
Clinique indépendante, membre de la bannière Opto-Réseau recherche un(e) optométriste pour joindre une équipe dynamique de 4 opticiens d’ordonnances et plusieurs assistantes. Les horaires sont flexibles et nous sommes fermés la fin de semaine. Nous avons 4 salles d’examens disponibles et avons OCT, Optomap, topographe, champ visuel Humphrey, biométrie et clinique de sécheresse (IPL, radiofréquence) ainsi qu’un laboratoire sur place. Nous avons une clientèle très diversifiée, familiale et fidèle. N’hésitez pas à me contacter en toute confidentialité.
Temps partiel permanent Centre Visuel de Lorraine centrevisueldelorraine.com
Docteure Isabelle Ouimet, optométriste 514 570-9024
isaouimetod@hotmail.ca
Notre belle clinique est à la recherche d’un(e) optométriste pour compléter son équipe. Clinique indépendante établie depuis 40 ans et membre du regroupement SOI. Horaire flexible et de semaine disponible. Salle de prétests bien équipée et comptant des assistantes certifiées et une opticienne d’ordonnances. Au plaisir de vous rencontrer !
Temps plein
LOPTICIEN.CA
Docteur Alain Côté, optométriste 514 244-0151 ou 514 592-3692
Madame Marie Vachon marie.vachon@lopticien.ca
LOPTICIEN.CA propriétaire indépendant avec deux boutiques dans la région de Laval offre à ses optométristes un environnement professionnel, l’utilisation d’équipements à la fine pointe de la technologie et garantit des journées complètes de rendez-vous.
Temps partiel / permanent Clinique d’optométrie Embrun embrunoptometry.com
Docteure Céline Pomainville, optométriste 613 443-5550 embrunod@live.ca
La clinique d’optomérie d’Embrun est à la recherche d’un(e) optométriste préférablement bilingue pour se joindre à notre équipe. Notre clinique est équipée avec : OCT Zeiss – Optomap Monaco – Myah de Topcon – Nidek (auto-réfraction / kératométrie / NCT / pachymétrie) –champs visuels Humphrey – dispensaire et laboratoire sur place, belles heures d’ouverture.
Temps partiel / permanent
Lunetterie Abella & De Montigny lunetterieabella.com
Docteure Sylvie Larouche, optométriste Monsieur Yazid Abella 514 243-5114 contact@lunetterieabella.com
La Lunetterie Abella & de Montigny, clinique indépendante établie depuis 44 ans, est à la recherche d’un(e) optométriste pour se joindre à son équipe une journée par semaine et possibilité de deux journées. La clinique est bien équipée (OCT, champ visuel, autoréfractomètre 4 en 1) dans le but de bien servir sa clientèle chaleureuse et fidèle. Vous bénéficierez d’un horaire complet dans une ambiance de travail conviviale, professionnelle et sans pression avec une équipe motivée et à l’écoute. La clinique est située dans le quartier Ahuntsic, près du métro Crémazie (stationnement disponible). Au plaisir de vous rencontrer !
Temps partiel / remplacements ponctuels
Raymond et Côté, opticiens et optométristes mobiles visionrc.ca
Docteure Shelton Regismarianayagam, optométriste 514 946-1010 poste #3 cv@visionrc.ca
L’équipe de Raymond et Côté est à la recherche d’optométristes un jour/semaine sur le territoire de Laval et de la Rive-Nord. Vous êtes optométriste à la recherche d’un peu d’aventure ? Nous sommes ouverts à rencontrer des professionnels de coeur qui veulent améliorer le monde. Si vous voulez explorer vos possibilités de pratique mobile en RPA et en CHSLD avec une équipe dédiée à la mission, contactez-nous pour en discuter et venir observer nos équipes sur le terrain. Nous serons enchantés de vous accueillir dans notre belle équipe déjà composée de 6 opticiens d’ordonnances et 7 optométristes. Au plaisir de vous rencontrer !
Docteur David Yalovsky, optométriste 514 235-0787
Visiomètre Marco RT-300
Huvitz MRK-3100 PREMIUM
(Auto-réfracto-kératomètre)
Biomicroscope SL-D4 Topcon (2022)
(avec tonomètre Goldman attache) Lentimètre manuel Topcon
LM-8E (2023) external scale a/c adaptor
Kit de lentilles d’essai
Autres outils optométriques sur demande (test 3D etc.)
Outils pour les opticiens d’ordonnances sur demande (sphéromètre etc.)

Réduire la durée des tests.
Améliorer la compréhension du glaucome.


Les tests de seuil sont plus rapides que jamais avec SITA Faster 24-2
SITA Faster 24-2 améliore le flux de travail clinique et la satisfaction des patients grâce au temps de test le plus rapide dans les tests de seuil HFA. Environ 50% plus rapide que SITA Standard, SITA Faster 24-2 est également 30% plus rapide que SITA Fast, tout en offrant la même reproductibilité.
Obtenez plus d’informations dans le champ visuel central SITA Faster avec 24-2C : Une combinaison gagnante
Réduisez les temps de test de moitié* en utilisant SITA Faster sans compromettre les résultats des tests. Ajoutez dix points de test centraux au 24-2 en utilisant le nouveau modèle 24-2C qui comprend des emplacements le long des faisceaux de fibres nerveuses connus pour être susceptibles de présenter des défauts glaucomateux.


Éclairer votre prise de décision grâce à la GPA
Identifier les progressions rapides avec l’analyse guidée de la progression (GPA™) en utilisant à la fois les anciens et les nouveaux tests SITA. Détecter et évaluer les changements dans la progression du glaucome à l’aide de tests SITA mixtes effectués sur n’importe quel HFA.
Optimisez le flux de travail de votre clinique avec le HFA3.
Scannez pour en savoir plus.
